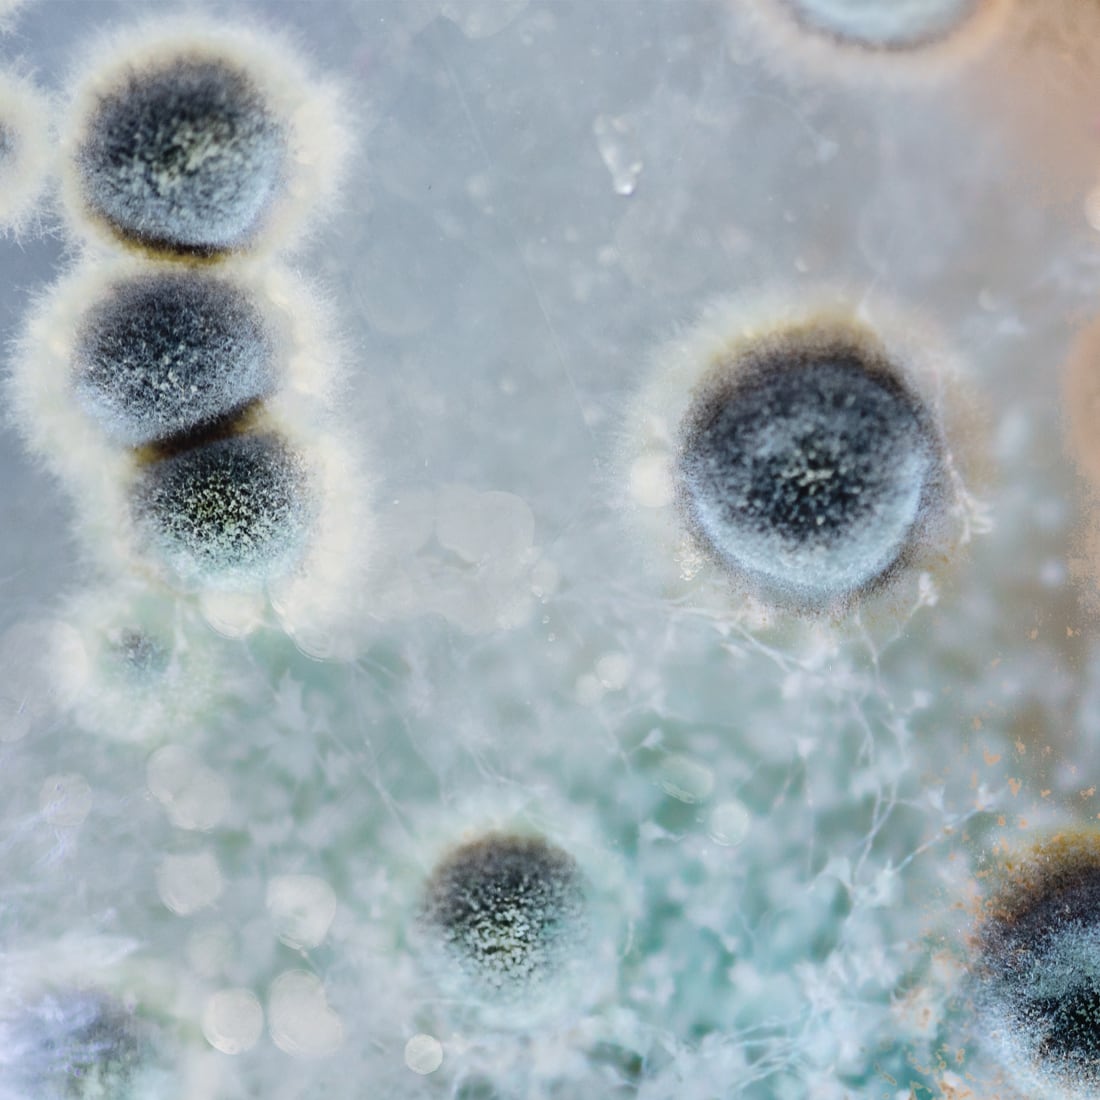

laboratoire écologie et art pour une société en transition
médias
Filtré par
-
Texte
-
Vidéo
-
Audio
- presse
- Tous les médias
Optimisme cruel
Texte
L‘“optimisme cruel”, selon Lauren Berlant, réfère à ce qui fait grincer nos désirs et nous empêche d’avancer comme espéré.
least

Le nid
Texte
Une réflexion poétique de Gaston Bachelard sur le nid, symbole d’intimité, de refuge et d’univers imaginaire.
CROSS FRUIT (ex Verger de Rue)
Faire commun
Tout coule
Texte
La vie repose sur une synchronisation fine entre les rythmes du vivant et les cycles de la Terre.
Faire commun
Vivre le Rhône
CROSS FRUIT (ex Verger de Rue)
Marcher à Tarente
Texte
Rencontrer une ville à travers la marche.
least
Laggiù, Taranto
La « vie » des objets
Texte
La matière ne devrait pas être conçue comme passive et inerte, mais comme dotée d’une vitalité intrinsèque.
d'un champ à l'autre / von Feld zu Feld
Peau Pierre
Urgence et cocréation
Texte
Un entretien avec l’architecte Antonella Vitale.

Un sol vivant
Texte
Même si nous le foulons quotidiennement nous réfléchissons rarement à l’importance du sol dans nos vies.
CROSS FRUIT (ex Verger de Rue)
Faire commun
Arpentage
Clôture et Pouvoir
Texte
Les fruits sont à tous et la terre n’est à personne.
Arpentage
Faire commun
d'un champ à l'autre / von Feld zu Feld
Se rencontrer sur le seuil
L’automne du jardinier
Texte
“On dit que le printemps est l’époque du bourgeonnement ; en réalité l’époque du bourgeonnement, c’est l’automne”.
CROSS FRUIT (ex Verger de Rue)
Faire commun
Arpentage
Comme la petite pierre est heureuse
Texte
Emily Dickinson célèbre le bonheur d’une vie simple et indépendante.
Peau Pierre
Arpentage
Faire commun
d’un champ à l’autre / von Feld zu Feld
Ô noble Vert
Texte
La «Ignota Lingua» de Hildegarde de Bingen.
CROSS FRUIT
Common Dreams
Faire commun

La multiplicité des communs
Texte
Yves Citton nous parle de biens communs, de communs négatifs et de sous-communs.
Common Dreams Panarea: Flotation School
Faire commun
Arpentage
CROSS FRUIT
L’expérience du paysage
Texte
La complexité du terme «paysage» peut être mieux comprise à travers le concept d’«expérience».
Vivre le Rhône
Faire commun
Arpentage
CROSS FRUIT
Heidi 2.0
Texte
Les Alpes et «l’exotisme de proximité».
Arpentage
d’un champ à l’autre / von Feld zu Feld
Écouter le levain
Texte
Un entretien avec l’artiste et académique Marie Preston sur les pratiques coopératives et l’inclusion du plus-qu’humain.
Common Dreams Panarea: Flotation School
Faire commun
La vie minérale
Texte
La reconnaissance de notre enchevêtrement avec les processus géologiques.
Peau Pierre
Repenser la transition
Texte
Un entretien avec Denise Medico.
Peau Pierre
CROSS FRUIT (ex Verger de Rue)
Vidéo
Un projet d’écologie urbaine impliquant les citoyen·ne·x·s dans la conception, la création et l’entretien d’un verger.
CROSS FRUIT (Verger de Rue)
Vivre le Rhône: partie 3
Vidéo
Gardien·ne·x·s du fleuve
Vivre le Rhône

Zone de sacrifice
Texte
«Un jour, alors que nous nous baladions près de l’Ironbound Community Corporation, nous avons senti une odeur âcre.»
least
La Recette du Gesamthof: Un Jardin Lesbien
Texte
Le Gesamthof est un jardin qui n’est pas centré sur l’humain et qui évince l’idée d’un résultat final.
Peau Pierre
CROSS FRUIT
Peau Pierre: une capsule sonore
Audio
« Lorsque nous nous sommes finalement touchés, l’eau a été un intermédiaire de cette rencontre».
Peau Pierre
Le pain sauvage
Texte
Un essai sur l’expérience de la faim en Europe à l’époque moderne.
CROSS FRUIT
Faire commun


Vivre le Rhône: le podcast, partie 03
Audio
Un projet audio qui retrace l’expérience de celleux qui se sont rapproché•es du fleuve en marchant.
Vivre le Rhône
Vivre le Rhône: le podcast, partie 02
Audio
Un projet audio qui retrace l’expérience de celleux qui se sont rapproché•es du fleuve en marchant.
Vivre le Rhône
Spillovers
Texte
Un essai de science-fiction sur l’eau et un manuel sexuel créé par Rita Natálio.
Peau Pierre
Vivre le Rhône: partie 2
Vidéo
Quand l’art rencontre le droit.
Vivre le Rhône
Gardien·ne·x·s de la nature
Texte
Entretien avec Marine Calmet, avocate spécialisée dans le droit de l’environnement et des peuples autochtones.
Vivre le Rhône
Corps d’eau
Texte
Embrasser l’hydroféminisme.
Vivre le Rhône
Common Dreams
Peau Pierre
Faire commun
Intimité entre étrangers
Texte
Les lichens nous parlent d’un monde vivant dans lequel la solitude n’est pas une option viable.
Common Dreams
Faire commun
CROSS FRUIT
Vivre le Rhône: le podcast, partie 01
Audio
Un projet audio qui retrace l’expérience de celleux qui se sont rapproché•es du fleuve en marchant.
Vivre le Rhône

Un monde sous-optimal
Texte
Un entretien avec Olivier Hamant, auteur du livre «La troisième voie du vivant» .
Common Dreams
CROSS FRUIT
Faire commun

La sagesse du myxomycète
Texte
Même les organismes les plus simples peuvent proposer de nouvelles façons de penser, d’agir et de collaborer.
Common Dreams
Peau Pierre
Faire commun
CROSS FRUIT
Arpentage
d’un champ à l’autre / von Feld zu Feld
Reporter la catastrophe
Texte
Si la fin est proche, pourquoi ne parvenons-nous pas à nous intéresser sérieusement au réchauffement global?
Common Dreams
Vivre le Rhône
Arpentage
d’un champ à l’autre / von Feld zu Feld
Un sentiment profond de devoir agir
Texte
Entretien avec Myriam Roth, militante pour le climat.
Vivre le Rhône
Vivre le Rhône: partie 1
Vidéo
Rencontrez le Rhône et le Natural Contract Lab.
Vivre le Rhône

Common Dreams Panarea: Flotation School
Vidéo
La vidéo du projet Common Dreams Panarea: Flotation School.
Common Dreams
GLOSSAIRE DE LA TRANSITION (T — T) par Ritó Natálio
Texte
Une fiction spéculative collective éco-transféministe.
Peau Pierre
Optimisme cruel
« Une relation d’optimisme cruel se crée lorsque ce que l’on désire devient, en réalité, un frein à notre épanouissement. Cela peut être la nourriture, une forme d’amour, un fantasme de vie idéale ou encore un projet politique. Parfois, c’est quelque chose de plus banal, comme une nouvelle routine censée permettre de nous améliorer. Ces attachements ne sont pas cruels en eux-mêmes. Ils le deviennent lorsque l’objet de notre désir entrave activement le but qui nous attirait vers lui au départ. »
C’est par ces mots que s’ouvre Optimisme cruel, un ouvrage de la théoricienne Lauren Berlant, devenu, ces dernières années, une référence incontournable pour celleux qui s’interrogent sur les affects, le désir et la précarité.
Qui n’a jamais cru, au moins une fois, que travailler plus que de raison nous ferait avancer ? Qu’une relation toxique valait toujours mieux que la solitude ? Ou que l’engagement politique, à lui seul, pouvait suffire à transformer le monde ? Toutes ces promesses finissent par grincer. Et derrière ce grincement, Lauren Berlant met en lumière un sentiment plus profond, qui traverse bien des vies contemporaines : l’impasse – cette condition où l’on avance sans savoir vraiment vers quoi, où l’on survit plus qu’on ne vit, où le changement est à la fois désiré, redouté et sans cesse remis à plus tard.

Dessin: Anaëlle Clot.
Mais Lauren Berlant ne se contente pas d’un simple constat. Iel nous invite à porter attention aux micro-tactiques par lesquelles les individus tentent de survivre dans cette impasse. Iel les appelle « formes d’auto-interruption » : des gestes infimes, comme manger de façon anarchique, scroller de façon compulsive, enchaîner les épisodes d’une série, procrastiner – des comportements souvent perçus comme négatifs ou nuisibles. Mais dans la lecture de Lauren Berlant, ces gestes sont aussi des respirations, des pauses volées au temps de la performance, de petits refuges où le sujet se met à l’abri. Des actes qui, sans prétendre changer le monde, traduisent malgré tout un désir de persister – et qui, justement pour cela, portent en eux une forme de puissance politique.
Dans un monde épuisant, réussir – ne serait-ce qu’aujourd’hui – à ne pas sombrer, c’est déjà une forme de résistance.
Peut-être pourrions-nous alors nous inspirer de cette posture : être plus indulgent·e·x·s envers nous-mêmes, nous accorder du repos, de l’espace, de la suspension. Accepter de ne rien faire, de temps en temps, peut être un vrai geste de soin. Et c’est aussi une manière de désirer un monde plus vivable.
Le nid
Nous proposons ici un extrait de La Poétique de l’espace de Gaston Bachelard, philosophe français du XXᵉ siècle. Dans cet ouvrage, Bachelard explore les lieux de l’intimité humaine — maison, tiroir, coin, nid — en les abordant non pas comme des objets physiques, mais comme des espaces vécus, habités par l’imaginaire. Le passage présenté est une méditation sensible et poétique sur le nid, vu comme un refuge essentiel, un centre d’univers à la fois réel et rêvé.
C’est cependant le nid vivant qui pourrait introduire une phénoménologie du nid réel, du nid trouvé dans la nature et qui devient un instant — le mot n’est pas trop grand — le centre d’un univers, la donnée d’une situation cosmique. Je soulève doucement une branche, l’oiseau est là, couvant les œufs. C’est un oiseau qui ne s’envole pas. Il frémit seulement un peu. Je tremble de le faire trembler. J’ai peur que l’oiseau qui couve sache que je suis un homme, l’être qui a perdu la confiance des oiseaux. Je reste immobile. Doucement s’apaisent — je l’imagine ! — la peur de l’oiseau et ma peur de faire peur. Je respire mieux. Je laisse retomber la branche. Je reviendrai demain. Aujourd’hui, une joie est en moi : les oiseaux ont fait un nid dans mon jardin.
Et le lendemain, quand je reviens, marchant dans l’allée plus doucement que la veille, je vois au fond du nid huit œufs d’un blanc rosé. Mon Dieu ! Qu’ils sont petits ! Comme c’est petit un œuf des buissons !
Voilà le nid vivant, le nid habité. Le nid est la maison de l’oiseau. Il y a longtemps que je le sais, il y a longtemps qu’on me l’a dit. C’est une si vieille histoire que j’hésite à la redire, à me la redire. Et pourtant, je viens de la revivre. Et je me souviens, dans une grande simplicité de la mémoire, des jours où, dans ma vie, j’ai découvert un nid vivant. Comme ils sont rares, dans une vie, ces souvenirs vrais !
Comme je comprends alors la page de Toussenel qui écrit :
« Le souvenir du premier nid d’oiseaux que j’ai trouvé tout seul est resté plus profondément gravé dans ma mémoire que celui du premier prix de version que j’ai remporté au collège. C’était un joli nid de verdier avec quatre œufs gris-rose historiés de lignes rouges comme une carte de géographie emblématique. Je fus frappé sur place d’une commotion de plaisir indicible qui fixa pendant plus d’une heure mon regard et mes jambes. C’était ma vocation que le hasard m’indiquait ce jour-là. »
Quel beau texte pour nous qui cherchons les intérêts premiers ! En retentissant, au départ, à une telle « commotion », on comprend mieux que Toussenel ait pu intégrer, dans sa vie et dans son œuvre, toute la philosophie harmonique d’un Fourier, ajouter à la vie de l’oiseau une vie emblématique à la dimension d’un univers.
Mais dans la vie la plus coutumière, chez un homme qui vit dans les bois et les champs, la découverte d’un nid est toujours une émotion neuve. Fernand Lequenne, l’ami des plantes, se promenant avec sa femme Mathilde, voit un nid de fauvette dans un buisson d’épine noire :
« Mathilde s’agenouille, avance un doigt, effleure la fine mousse, laisse le doigt en suspens…
Tout à coup je suis secoué d’un frisson.
La signification féminine du nid perché à la fourche de deux rameaux, je viens de la découvrir. Le buisson prend une valeur si humaine que je crie :
— N’y touche pas, surtout, n’y touche pas. »

Dessin: Anaëlle Clot.
La « commotion » de Toussenel, le « frisson » de Lequenne ont la marque de la sincérité. Nous y avons fait écho dans notre lecture, puisque c’est dans les livres que nous jouissons de la surprise de « découvrir un nid ». Poursuivons donc notre recherche des nids en littérature.
Nous allons donner un exemple où l’écrivain augmente d’un ton la valeur domiciliaire du nid. Nous empruntons cet exemple à Henry-David Thoreau. Dans la page de Thoreau, l’arbre entier est, pour l’oiseau, le vestibule du nid. Déjà l’arbre qui a l’honneur d’abriter un nid participe au mystère du nid. L’arbre est déjà pour l’oiseau un refuge.
Thoreau nous montre le pivert prenant tout un arbre pour demeure. Il met cette prise de possession en parallèle avec la joie d’une famille qui revient habiter la maison longtemps abandonnée :
« Ainsi, lorsqu’une famille voisine, après une longue absence, rentre à la maison vide, j’entends le bruit joyeux des voix, les rires des enfants, je vois la fumée de la cuisine. Les portes sont grandes ouvertes. Les enfants courent dans le hall en criant. Ainsi le pivert se précipite dans le dédale des branches, perce ici une fenêtre, en sort en caquetant, se jette ailleurs, aère la maison. Il fait retentir sa voix en haut, en bas, prépare sa demeure… et en prend possession. »
Thoreau vient de nous donner à la fois le nid et la maison en expansion. N’est-il pas frappant que le texte de Thoreau s’anime dans les deux directions de la métaphore : la maison joyeuse est un nid vigoureux — la confiance du pivert à l’abri dans l’arbre où il cache son nid est une prise de possession d’une demeure.
Nous dépassons ici la portée des comparaisons et des allégories. Le pivert « propriétaire » qui apparaît à la fenêtre de l’arbre, qui chante au balcon, correspond, dira sans doute la critique raisonnable, à une « exagération ». Mais l’âme poétique saura gré à Thoreau de lui donner, avec le nid à la dimension de l’arbre, une augmentation d’image.
L’arbre est un nid dès qu’un grand rêveur se cache dans l’arbre. On lit dans les Mémoires d’Outre-tombe cette confidence-souvenir de Chateaubriand :
« J’avais établi un siège, comme un nid, dans un de ces saules : là, isolé entre le ciel et la terre, je passais des heures avec les fauvettes. »
En fait, dans le jardin, l’arbre habité par l’oiseau nous devient plus cher. Si mystérieux, si invisible que soit souvent le pic tout de vert vêtu dans la feuillée, il nous devient familier. Le pic n’est pas un habitant silencieux. Et ce n’est pas quand il chante qu’on pense à lui ; c’est quand il travaille. Tout le long du tronc d’arbre, son bec, en des coups retentissants, frappe le bois. Il disparaît souvent, mais toujours on l’entend. C’est un ouvrier du jardin.
Et ainsi, le pic est entré dans mon univers sonore. J’en fais pour moi-même une image salutaire. Quand un voisin, dans ma demeure parisienne, plante trop tard des clous dans le mur, je « naturalise » le bruit. Fidèle à ma méthode de tranquillisation à l’égard de tout ce qui m’incommode, je m’imagine être dans ma maison de Dijon et je me dis, trouvant naturel tout ce que j’entends : « C’est mon pic qui travaille dans mon acacia. »
Tout coule
Dans le cadre du projet Faire commun, qui explore les conditions d’une écologie partagée au Parc Rigot, least vous propose une réflexion sur les rythmes qui traversent les vivants, les lieux, et le temps lui-même. « Faire commun », c’est aussi faire « temps ensemble » : chercher comment nos existences s’accordent – ou se désaccordent – avec les cycles de ce qui nous entoure. Ce texte invite à écouter les pulsations multiples du monde pour imaginer de nouvelles formes de cohabitation sensible.
Au parc Rigot, des étudiant·e·x·s, chercheur·euse·x·s et artistes se sont rassemblés pour entrer en résonance avec le territoire : une exploration sensible et interdisciplinaire visant à révéler les rythmes propres au paysage, à ses vivants, à ses usages. En observant les chênes centenaires, les passant·e·x·s ou encore la pièce d’eau, ils et elles ont mis en lumière la manière dont chaque élément du parc vibre à son propre tempo – parfois régulier, parfois chaotique – composant une partition collective.
Le mot rythme vient du verbe grec rhéô, qui signifie « couler ». Dans la philosophie grecque, l’expression panta rei – littéralement « tout coule » – résume la pensée d’Héraclite d’Éphèse, philosophe du changement perpétuel : tout est en constante transformation, comme un fleuve dont l’eau s’écoule sans arrêt, si bien qu’on ne peut jamais se baigner deux fois dans la même eau.
L’eau, justement, est au cœur de notre première expérience du rythme. Avant même la naissance, nous percevons les sons à travers le liquide amniotique : les battements du cœur, le souffle, la circulation du sang. Seuls les sons graves et rythmés traversent ce milieu fluide. Après la naissance, une part de cette eau demeure en nous : l’oreille interne, encore emplie de fluides, capte les vibrations du monde. Cette eau originelle inscrit en nous une mémoire intime du rythme et du temps. C’est peut-être pour cela que l’étang de Rigot, niché au bas du parc, agit comme un aimant sensoriel : il capte le regard, attire la faune et devient un point de repère où les rythmes des humains et non-humains se rencontrent au fil des heures.
L’humanité a très tôt cherché à mesurer le temps. L’un des premiers instruments connus est une clepsydre à eau, datant du XIVᵉ siècle av. J.-C., découverte dans le temple de Karnak en Égypte. Deux récipients, reliés par un petit orifice, permettaient de quantifier l’écoulement régulier du temps. À Rigot, ce sont les chênes, plantés à l’ouest de la parcelle, qui jouent ce rôle de mesure silencieuse : année après année, ils inscrivent la mémoire du temps dans leur écorce.
Dans les environnements sonores peu marqués par les activités humaines, la majorité des sons suivent des rythmes prévisibles. Le chant d’un oiseau, le bruissement du vent dans les feuillages, le ressac discret de l’étang, autant de motifs récurrents que les êtres vivants identifient sans alarme. Cette régularité apaise, stabilise. À l’inverse, les sons brusques – les travaux, les foules, les véhicules – perturbent les équilibres sensoriels et déclenchent des réactions de panique. La régularité des rythmes sonores constitue ainsi un facteur fondamental de stabilité.
Le rythme est ainsi essentiel à la perception auditive de chaque espèce. Les neurones de l’oreille et du cerveau ne s’activent que si la fréquence des sons correspond à un rythme de référence. Dans les années 1960, le chercheur hongrois Péter Szőke a ralenti les chants d’oiseaux pour en révéler la complexité, inaudible à l’oreille humaine. Cette attention au détail, à l’invisible, guide les démarches sensibles menées au parc Rigot : écouter, ralentir, observer ce qui, à première vue, échappe à la perception.
Chez les vivants, le temps se construit sur trois niveaux : un rythme interne, une synchronisation avec les cycles environnementaux et une coordination entre individus. Le rythme interne est affiné par des signaux extérieurs, appelés zeitgebers (« donneurs de temps ») : la lumière, la température ou la saisonnalité. Chez les oiseaux migrateurs, la mémoire de la fonte des neiges, la durée du jour et l’observation des comportements d’autres espèces participent à synchroniser le départ vers les lieux de reproduction.

Dessin: ©Anaëlle Clot.
Ainsi, le temps n’est pas qu’une affaire individuelle : il se construit aussi socialement. Chez les abeilles, les nourrices maintiennent un rythme constant dans la ruche, pendant que les butineuses adaptent leur activité aux horaires d’ouverture des fleurs. La coordination de ces horloges internes génère un temps collectif – un rythme partagé.
Les sociétés humaines, elles aussi, entretiennent des rapports multiples et hétérogènes au temps. Dans de nombreuses cultures autochtones, le temps est lié aux rythmes locaux de la terre, des animaux ou des paysages. Chez les éleveur·euse·x·s de rennes sámi, par exemple, le concept de jahkodat affirme que chaque année est unique : la migration dépend de multiples facteurs comme la fonte des neiges ou l’état des pâturages. « Une année n’est pas la sœur de la suivante », dit un proverbe sámi. Chaque cycle impose une attention fine et une adaptation constante.
Aujourd’hui, la mondialisation a affaibli cette sensibilité à la saisonnalité. Pourtant, la saisonnalité elle-même n’est pas universelle. Certaines régions connaissent quatre saisons, d’autres une alternance sèche-humide. Dans Nagori, Ryoko Sekiguchi rappelle qu’au Japon, l’année est traditionnellement divisée en 24 saisons, voire 72 micro-saisons. Cette perception subtile du temps se reflète dans le langage, où des mots et des haïkus sont liés à des moments précis, tissant un lien entre culture, climat et expression.
Mais le temps « objectif » est aussi une construction. Dans Austerlitz, W.G. Sebald raconte que le temps, bien qu’ancré dans les astres, repose sur des conventions humaines. Même le jour solaire varie : pour stabiliser nos horloges, l’humanité a inventé un « soleil moyen », un astre fictif dont le mouvement régulier sert de référence.
Cette normalisation du temps s’est intensifiée au XIXᵉ siècle avec le développement du chemin de fer. Pour coordonner les trajets, on impose les fuseaux horaires, brisant la diversité des temps locaux. Le monde entre alors dans une ère de synchronisation stricte, une standardisation qui coexiste aujourd’hui avec les dissonances écologiques et temporelles que nous traversons.
La vie repose donc sur une synchronisation fine entre les rythmes du vivant et les cycles de la Terre. La crise climatique actuelle vient bouleverser ces équilibres. À Rigot comme ailleurs, le décalage des saisons, les températures qui grimpent, les floraisons et les migrations désynchronisées perturbent profondément les horloges biologiques. Cette rupture menace la reproduction, l’alimentation et la survie de nombreuses espèces. Quand le temps du vivant se désaccorde de celui de la Terre, c’est l’équilibre même de la vie qui vacille.
Ainsi, face aux désaccords grandissants entre les temps humains et ceux du vivant, Faire commun invite à une réorientation sensible : ralentir, écouter, cohabiter. Le parc Rigot devient alors un terrain d’apprentissage partagé où l’on expérimente d’autres manières d’habiter le temps – ni linéaire ni productiviste, mais cyclique, poreux, accordé à ce qui pousse, se transforme ou disparaît. En réconciliant les multiples temporalités de la Terre, ce projet esquisse les prémices d’un avenir habitable.
Marcher à Tarente
Ce texte a été écrit par l’artiste Martin Reinartz, dans le cadre du programme de résidences de recherche de least en Europe du Sud. Ce programme vise à créer un dialogue entre artistes, chercheur·euse·x·s et communautés autour des enjeux écologiques et sociaux, à travers des périodes d’immersion sur des territoires fortement marqués par les conséquences de la crise environnementale. La résidence de Martin Reinartz à Tarente, rendue possible grâce à notre collaboration avec le collectif local Post Disaster, s’inscrit dans cette démarche.
Novembre 2024.
Je vais à Tarente en tant qu’artiste invité du collectif d’architectes et urbanistes Post Disaster. Je ne connais rien de la ville, sinon les récits que l’on m’en a faits. Je demande à ne rien savoir de plus, à ne rien prévoir.
On pensera peut-être que c’est injustifiable, quelqu’un qui vient sans projet. Je me rassure. Mon projet, c’est cette absence totale de projet. Je veux simplement leur demander, à celles et ceux qui m’accueillent, que nous allions marcher ensemble dans leur ville. À deux. Qu’ils ou elles m’emmènent dans un endroit qui leur semble important, qu’ils ou elles aiment. Peu importe s’il s’agit d’aller au lavomatic ou de nous rendre chez des ami.e.s pour boire un verre.
Marcher est pour moi un moyen d’aller à la rencontre de la ville. Il n’y a rien de productif, en apparence, dans cet acte-là. Rien qui ne me distingue du reste du monde, rien qui dise : voilà quelqu’un qui est un artiste. Pas de technique particulière à exhiber, pas de maestria.
J’essaie de me glisser dans un quotidien. De me glisser dans la ville, et de me laisser entraîner par ses flux. Je ne cherche pas à produire un objet. Juste être là, éprouver l’espace et ce qu’il a à offrir.
Alors, est-ce du bluff pour autant ?
Est-ce encore possible de venir sans justification ? À partir de quand la dimension d’un projet intègre-t-elle l’idée de sa rentabilité ? Comment cette rentabilité oriente-t-elle les rapports de collaboration, entre artistes associés, entre artistes et structures ? J’essaie de repérer ces signaux. J’essaie de ruser. Comme on essaie de sortir d’une route déjà bien connue, trop souvent empruntée.
Peppe Frisino
« Are we meeting tomorrow in the morning time? I will be in old town at 8.30 and i could bring you with me in some meetings. We can meet at the bar Falanto, via duomo! They are my friends, but sometimes they aren’t nice people. »
Peppe Frisino est urbaniste. Il est le seul membre du collectif à vivre encore dans la ville. Il vit avec sa famille dans la vieille ville de Tarente.
Il est neuf heure, il m’emmène « chez un ami », un homme au crâne rasé, en survêtement. Peppe me présente comme étant son associé. Je le connais depuis cinq minutes à peine.
Nous montons dans un appartement au carrelage blanc, sur le sol, sur les murs. Le canapé est blanc, la table est d’un bois clair. Et à part ça, il n’y a rien dans ce séjour.
L’homme explique à Peppe qu’il doit l’aider à monter un cadre en bois. Un immense cadre d’un mètre sur soixante centimètres, sur lequel sera agrafée une photo de son fils, prise le jour de sa communion.
Peppe, je le comprendrais plus tard, a un rôle particulier dans ce quartier.
La vieille ville de Tarente est bâtie sur une petite île. Si on la qualifie de centre historique, c’est bien parce qu’en dépit de son apparence actuelle, elle a été et reste l’un des centres importants de la ville.
Dans ce quartier, tous le monde connaît Peppe. C’est son terrain de jeu. Il m’explique qu’il y passe quatre vingt dix pour cent de son temps, quand d’autres n’y mettent jamais les pieds. Trop sale. Trop délabré. Trop dangereux.
Peppe marche vite. Il a un vélo cargo pour aller chercher ses enfants à l’école, hors de l’île. Comme s’il fallait ne pas s’échapper trop longtemps.
Lorsqu’il traverse la via Duomo, au coeur de l’île, Peppe prend son temps. On l’arrête, il prend des nouvelles, il lance des blagues, il me présente, on me sourit, on me parle italien.
Je me demande ce qu’il fait exactement dans la vie. Ce qui le définit. Impossible de comprendre ce que signifie pour lui être urbaniste, mais je pressens que sa pratique est profondément liée à sa manière d’être en relation avec cet espace là. Avec chaque être dont les rues grouillent.
« Mercredi. Peppe a quelque chose du « trickster ». Insaisissable, il traverse la vieille ville de Tarente avec une aisance déconcertante. Urbaniste, certes, mais ce titre ne suffit pas. Il est un voisin, un complice. À peine arrivé, il me présente comme l’un des siens, brouillant les identités et les rôles. Il navigue entre les habitants, glisse d’une conversation à l’autre, multiplie les détours. Chez lui, la relation prime sur la fonction. Comme le trickster, il ne se conforme pas aux attentes. Il joue, improvise, détourne. En aidant un homme à monter un cadre pour une photo de communion, en échangeant des nouvelles au détour de la via Duomo, il façonne l’espace sans le revendiquer. Il est de ces figures qui n’existent pas tant par ce qu’elles font que par la manière dont elles habitent le monde. »

Dessin: ©Anaëlle Clot.
Gabriella Mastrangelo
Gabriella vit à Massafra, en périphérie de Tarente. Je la rejoindrai en bus, vendredi matin, pour qu’elle m’emmène dans des endroits dont elle ne m’a rien dit. Je ne cherche pas à savoir. Ma proposition de réaliser des marches personnelles fait son chemin donc. Je trouve ça rassurant.
Gabriele Leo
Gabriele est venu me chercher dans le centre historique, en voiture. Il m’explique qu’il est arrivé tôt ce matin-là de Venise où il développe une thèse de doctorat. Son sujet de thèse : l’émergence des imaginaires issus de la catastrophe environnementale. Son implication dans le collectif Post Disaster est au coeur de sa réflexion.
« Post Disaster, c’est le nom de l’association. Ça vient de Timothy Morton, théoricien américain de la Dark Ecology. Il développe l’idée que dans les discours dominants, on parle beaucoup de la catastrophe à venir, alors que dans certains endroits comme ici à Tarente la catastrophe est déjà là. Nous vivons dans la catastrophe à venir, dans le Post Disaster. »
Gabriele veut m’emmener à Mottola, ville en périphérie de Tarente dans laquelle il a en partie grandit. Il n’est pas attaché à Tarente, me dit-il. Pas comme Peppe. Il dit avoir un rapport plus complexe à cette ville, d’attraction-répulsion. J’ai pas choisi de vivre ici. J’ai rarement choisi mes lieux de vies. Aujourd’hui, à Venise, je me sens bien.
À Mottola, nous grimpons l’une des rues principales, déserte, et nous arrivons sur un belvédère qui donne sur l’un des points de vue les plus élevés de la région. Face à nous, à quelques dizaines de kilomètres, Ilva et les autres usines.
Aujourd’hui, on ne discerne pas tellement le nuage de pollution au-dessus des usines. C’est très changeant. En fonction des conditions climatiques.
Les gens ne viennent pas ici. On ne regarde pas Tarente. On regarde Bari. On regarde Lecce. Tarente, on lui tourne le dos.
« Il y a des villes qui deviennent le reflet d’un pays, de ses transformations, de ses nœuds irrésolus, de ses échecs, de ses chutes, mais aussi de ses aspirations à la rédemption. Tarente est l’une de ces villes : un laboratoire urbain singulier, pris entre les cheminées d’Ilva et la mer qui s’étend devant ses palais, emblème du développement industriel du XXe siècle et de sa dérive vers une crise profonde.
Tarente est une ville à strates. Une ville où les plans historiques, temporels et sociologiques s’entrelacent, souvent en s’occultant les uns les autres. Son passé de capitale de la Grande-Grèce, de port méditerranéen traversé par les brassages culturels et les dominations étrangères, n’est qu’une de ces strates. C’est une couche de plus en plus difficile à saisir, engloutie dans les méandres de l’Histoire et souvent ramenée à la surface sous forme de rêve ou d’impulsion cachée. Mais la ville que nous connaissons aujourd’hui, s’étirant comme une langue de béton grisâtre sur plusieurs kilomètres au sommet du golfe qui porte son nom, est fondamentalement une création du XXe siècle, marquée par la grande industrie et les politiques de développement qui l’ont façonnée.
Vers la fin du XIXe siècle, juste après l’Unité italienne, Tarente comptait un peu plus de trente mille habitants, résidant principalement dans l’ancienne île qui constitue la vieille ville. La construction de l’Arsenal militaire marqua le début d’un développement économique et urbain chaotique qui allait caractériser Tarente tout au long du XXe siècle. Sur les ruines de ce complexe militaro-industriel s’est ensuite édifié le rêve sidérurgique, la nouvelle industrie d’État qui fit de Tarente la ville la plus ouvrière du Mezzogiorno. Mais ce n’est que bien plus tard qu’on a pu mesurer l’étendue des dégâts laissés par cette forge prométhéenne implantée sur les rives de la mer Ionienne. » (Alessandro Leogrande, Fumo sulla città, Fandango Libri, 2013)
La « vie » des objets
La relation entre les êtres humains et les objets, entre le sujet et la matière, est traditionnellement envisagée en termes d’utilisation, voire de domination. La philosophie occidentale, hormis quelques exceptions, a généralement opéré une distinction stricte entre le monde humain et le monde des choses, attribuant au premier une primauté absolue en matière de capacité d’action et d’intentionnalité.
Pourtant, dans notre expérience quotidienne, cette séparation entre nous et le monde des objets se révèle bien plus nuancée, dynamique et interactive. D’un point de vue pragmatique, il suffit de penser à la myriade de technologies qui nous entourent – de la fourchette aux réseaux informatiques – et qui influencent nos existences. Sur le plan symbolique, les objets jouent également un rôle fondamental dans la construction des identités individuelles et collectives, participant activement à la formation des représentations culturelles, affectives et sociales. Dans cette perspective, la distinction stricte entre sujet et objet s’estompe, laissant place à un réseau d’interactions mutuelles plus complexe.
Dans ce contexte, la penseuse Jane Bennett propose le concept de « matière vibrante » : la matière ne devrait pas être conçue comme passive et inerte, mais comme dotée d’une vitalité intrinsèque. Les objets et la matière ne se réduisent pas à de simples instruments soumis à la volonté humaine, mais exercent une capacité d’action qui leur est propre, influençant les humains et participant activement à la construction du monde social et politique. Selon Bennett, la réalité doit être appréhendée comme une série d’« assemblages », où matière vivante et inerte, animaux et objets, particules, écosystèmes et infrastructures concourent à parts égales à la production d’effets. Parmi les exemples analysés dans le livre Vibrant Matter, figure la panne d’électricité majeure qui a frappé le réseau nord-américain en 2003, plongeant des millions de personnes dans l’obscurité – un événement qui montre à quel point une entité supposément dénuée de pouvoir d’agir peut exercer une influence déterminante sur les humains. Comme elle l’écrit : « Pour le matérialiste vitaliste, le réseau électrique doit être compris comme un mélange volatil de charbon, de sueur, de champs électromagnétiques, de programmes informatiques, de flux d’électrons, d’intérêts économiques, de chaleur, de modes de vie, de combustibles nucléaires, de plastique, de fantasmes de maîtrise, de statique, de lois, d’eau, de théories économiques, de fils et de bois – pour ne citer que quelques actants. » En analysant la chaîne des causes ayant conduit à cette panne, Bennett met en lumière son caractère émergent, qui remet en question les concepts traditionnels de responsabilité et de causalité, ainsi que la distinction entre sujet et objet. Si une telle approche se manifeste évidemment dans un événement de grande ampleur, elle peut être étendue à l’ensemble de notre expérience du monde.
Par ailleurs, sur le plan scientifique, les distinctions classiques entre matière vivante et non-vivante, organique et inorganique, tendent à s’estomper. Des matériaux considérés comme inertes se révèlent capables de croissance, d’auto-organisation, d’apprentissage et d’adaptation à l’environnement. L’idée selon laquelle l’intelligence serait une propriété exclusivement humaine est désormais obsolète et trompeuse : c’est sur ce postulat que repose Parallel Minds de la chimiste et théoricienne Laura Tripaldi. Dans ce livre, elle s’attarde notamment sur le concept d’interface, que nous associons souvent aux technologies numériques, mais qui, en chimie, désigne un espace tridimensionnel doté de masse et d’épaisseur, où deux substances distinctes entrent en contact. Dans cet espace d’interaction, les matières adoptent des comportements singuliers : Laura Tripaldi prend l’exemple de l’eau qui, au contact d’une surface lisse, adopte la forme d’une goutte.

Dessin: ©Anaëlle Clot.
Plus qu’une notion technique, l’interface nous invite à repenser notre relation à la matière : « L’interface est le produit d’une relation réciproque, dans laquelle deux corps en interaction fusionnent pour former un matériau hybride, distinct de ses composantes initiales. Encore plus significatif, l’interface n’est pas une exception : elle constitue l’essence même de notre expérience matérielle. Nous ne touchons jamais qu’une surface, mais il s’agit d’une surface tridimensionnelle et dynamique, qui pénètre à la fois l’objet et notre propre perception. »
L’acte de « toucher » est également au centre de la pensée de la philosophe et physicienne Karen Barad. Dans son ouvrage On Touching – The Inhuman That Therefore I Am, Barad explique que, du point de vue de la physique classique, le toucher est souvent décrit presque comme une illusion : en effet, les électrons qui composent les atomes de nos mains et des objets que nous touchons ne se rencontrent jamais réellement, mais se repoussent en raison de la force électromagnétique. Cela signifie que toute expérience de contact se produit toujours à une distance minimale, défiant ainsi notre intuition sensorielle.
Barad va encore plus loin en analysant la question à travers la théorie quantique des champs, qui introduit la possibilité que la matière ne soit pas quelque chose de statique et défini, mais plutôt un enchevêtrement continu de relations et de possibilités. La séparation, qui nous semble évidente, entre un corps et un autre s’efface, car les frontières entre le « moi » et l’« autre » sont continuellement redéfinies, dans un processus que Barad appelle intra/action et qui constituerait l’essence même de notre réalité – une réalité où tout est constamment co-produit et co-déterminé. Ce principe implique que l’identité n’est pas quelque chose de préétabli, mais le résultat d’infinies variations et transformations, selon un modèle queer et non binaire.
Ces approches nous invitent à repenser notre rapport aux objets du quotidien et à la matière en général. Si la matière possède une capacité d’action propre, nous devons reconnaître notre appartenance à un système complexe et interconnecté, avec des implications philosophiques, politiques et écologiques. Accepter que la matière nous modèle autant que nous la modelons suppose une responsabilité accrue quant à notre impact technologique et environnemental, et, in fine, envers nous-mêmes, en habitant les assemblages, les interfaces, les intra/actions.
Urgence et cocréation
Antonella Vitale est une architecte qui a consacré une partie de sa carrière à la conception de camps de réfugiés. Aujourd’hui, parler de personnes déplacées et d’espaces temporaires ne signifie pas seulement s’intéresser aux crises humanitaires, mais aussi réfléchir plus largement à ce que signifie habiter et cohabiter dans un monde marqué par l’instabilité et les crises environnementales. L’expérience acquise dans ces contextes d’urgence montre qu’il est possible de répondre aux besoins fondamentaux du logement même avec des ressources limitées, en impliquant directement les communautés et en expérimentant des solutions plus flexibles et adaptées. Dans les camps de réfugiés, émergent des pratiques de cocréation et des stratégies d’adaptation qui peuvent inspirer une approche plus générale de la conception architecturale. À une époque marquée par les crises écologiques et les migrations forcées, comprendre comment assurer des conditions de vie dignes en situation de précarité revient à interroger les vulnérabilités de nos propres villes et à repenser les modalités d’implication des communautés dans la construction des espaces de vie.
Quel lien existe-t-il entre crise écologique et migration ?
Les problèmes écologiques, tels que la rareté des ressources naturelles, la désertification et les catastrophes environnementales, sont souvent étroitement liés aux conflits et aux migrations. La construction de camps de réfugiés comporte également son lot de défis. Par exemple, un effet secondaire de leur présence est la déforestation, car les personnes déplacées ont besoin de bois pour cuisiner et, dans certains cas, leurs installations s’étendent. Il faut savoir que ces personnes vivent souvent pendant des années dans des tentes et construisent des structures temporaires, de manière autonome, en autogestion.
De quelle durée parlons-nous ?
La durée moyenne passée dans un camp est de 17 ans. C’est pourquoi la culture humanitaire a évolué au fil du temps : autrefois, on se contentait de fournir de la nourriture, de l’eau et un logement temporaire. Aujourd’hui, l’objectif est de proposer une vie aussi normale que possible. Plutôt que de fournir des logements provisoires, l’idée est de loger les personnes déplacées chez les habitants ou dans des structures réaffectées, si les autorités locales l’autorisent. Les camps de réfugiés ne facilitent pas l’intégration car ils créent des ghettos ; ils sont désormais considérés comme un dernier recours.
Quel type de structures sont généralement mises à disposition de ces populations ?
Les tentes et les containers font partie des options les plus coûteuses dans les contextes extra-européens, ne serait-ce que pour leur transport. Les tentes, notamment, sont très précaires et inconfortables, et selon le climat, elles n’ont une durée de vie que de six mois. Par ailleurs, les campements sont souvent installés sur des terrains marginalisés, et s’ils n’ont pas encore été construits, c’est généralement pour une bonne raison : ils sont sujets aux inondations, sont trop chauds ou impossibles à cultiver. En général, il reste crucial de passer le plus rapidement possible de la phase de réponse d’urgence à une phase transitoire, puis vers une stabilité accrue.
Dans votre travail, avez-vous vécu des expériences de ce type ?
Lors de ma mission au Mozambique, j’ai participé à l’extension d’un camp de réfugiés afin d’accueillir 5 000 personnes supplémentaires. J’ai repris le projet après le départ de mon prédécesseur, qui avait rencontré de nombreuses difficultés de gestion. L’un des problèmes principaux était les incendies, allumés en guise de protestation par les habitant·e·x·s du camp. À mon arrivée, la situation était complexe et les règles de sécurité étaient très strictes : je devais respecter un temps limité dans le camp et revenir à ma base avant le coucher du soleil. C’était l’une de mes premières expériences, et je me suis retrouvée face à un défi de taille, sans directives claires sur la façon de procéder et avec peu de ressources.
Quelle approche avez-vous décidé d’adopter ?
J’ai choisi de maximiser le temps passé dans le camp, en commençant à interagir avec les différentes communautés. Le camp abritait des groupes venus de la région des Grands Lacs africains, des personnes marquées par des conflits profonds entre clans. J’ai cherché à comprendre leur situation et à les impliquer dans le processus décisionnel, leur confiant la tâche de signaler les problèmes et les besoins essentiels. Si je n’avais pas agi ainsi, il y aurait probablement eu de l’opposition, car involontairement, par exemple, nous aurions exacerbé des inimitiés entre les clans, en intervenant dans des histoires que nous ne pouvions comprendre et en alimentant les tensions.
Quelles stratégies avez-vous utilisées pour impliquer les habitants du camp ?
Le moment clé a été celui du lancement de la phase de conception et de planification. J’ai laissé les habitant·e·x·s me faire part de leurs besoins, aspirations et préférences concernant la disposition des logements. Pour moi, l’essentiel était de respecter le nombre de personnes à loger, tandis que la distribution des espaces leur revenait. Cette approche a eu un impact très positif sur la faisabilité du projet. Ma présence constante dans le camp a aussi permis de déconstruire le préjugé selon lequel les travailleurs humanitaires internationaux sont distants, enfermés dans leurs bureaux climatisés ou leurs jeeps. En montrant ma disponibilité à écouter, j’ai favorisé un climat de confiance.
Comment avez-vous surmonté l’obstacle de la langue ?
Pour faciliter la communication et la compréhension mutuelle, j’ai choisi d’afficher les dessins du projet à des endroits visibles du camp. Cela a suscité la curiosité des habitant·e·x·s, qui s’approchaient pour s’informer et participer activement aux rencontres. Grâce à cette méthode, nous avons pu définir au mieux la répartition des espaces de vie en fonction des besoins réels de la communauté. En fin de compte, l’élément clé de cette expérience n’a pas été l’aspect technique, mais la capacité à écouter et à répondre aux besoins des gens, en initiant un processus de cocréation qui a rendu le projet plus efficace.

Dessin: © Anaëlle Clot.
Comment êtes-vous intervenue dans les espaces publics ?
Le camp comportait des zones vides qui servaient de points de rassemblement naturels, comme celles autour des pompes à eau, souvent situées sous de grands arbres. L’un de ces points était proche du centre d’alimentation thérapeutique pour les enfants de moins de cinq ans et non loin de l’école. J’ai analysé ces synergies existantes et les ai intégrées à la création d’un terrain de sport, stratégiquement positionné pour encourager les activités physiques et le mouvement.
De plus, dans cette zone, j’ai introduit un système de communication plus structuré, en utilisant un arbre comme point d’affichage pour les commentaires, suggestions et plaintes de la communauté. Bien que les critiques aient été plus nombreuses que les louanges, ce système a permis d’établir un canal de communication direct et clair. Mon objectif était de faciliter les échanges entre les opérateurs et la communauté, en recueillant des retours utiles pour améliorer la gestion du camp. Quand il y a participation, cocréation ou au moins échange d’idées, les gens sont prêts à s’impliquer, surtout si cela touche aux constructions ou à l’utilisation des espaces.
Quels marges de liberté y avait-il pour l’auto-conception des bâtiments ?
Au Mozambique, nous avons impliqué les gens dans la construction de maisons avec des matériaux locaux : roseaux, terre et paille. La quantité de matériaux fournie à chaque famille était la même, et chacune pouvait ensuite décider comment l’utiliser en s’appropriant le projet. Il s’agissait de passer des tentes à des maisons très simples mais permanentes, selon les standards du Mozambique. Cela doit aussi être pris en compte : lorsqu’on offre une solution d’urgence à une population qui vient de l’extérieur, il ne faut pas aller au-delà de ce que les habitant·e·x·s les plus défavorisés de la société locale ont, afin de ne pas alimenter les tensions.
Y a-t-il d’autres niveaux de cocréation souhaitables dans ce contexte ?
La population déplacée, avant de quitter son pays d’origine, avait un métier, des occupations, des passions. Cartographier ces compétences est une richesse à exploiter pleinement, d’une part pour insérer ces personnes dans le monde du travail et les rendre autonomes, d’autre part pour contribuer aux programmes d’aide aux personnes déplacées. Les ressources étant limitées, tirer parti des compétences locales est une grande opportunité. Ce n’est pas toujours facile, cela prend du temps, il faut aller à la rencontre des gens, mais cela apporte énormément à la communauté qui se sent respectée, et non marginalisée.
Y a-t-il des pratiques spontanées dans l’espace public qui aident à créer de la cohésion ?
La nourriture est un outil important d’identité culturelle, surtout dans des contextes de grande désorientation. La possibilité de cultiver des aliments traditionnels ne se limite pas à fournir un moyen de subsistance, elle permet aussi de maintenir un lien avec la culture d’origine et de la partager avec la population locale. Cette pratique crée des opportunités d’échanges culturels, par exemple à travers de petits points de restauration où les habitant·e·x·s des camps peuvent faire découvrir leur cuisine. De plus, cela peut faciliter l’échange de techniques agricoles ou culinaires utiles à la fois à la communauté réfugiée et à celle d’accueil.
Quel est le rapport entre urgence et planification ?
L’urgence et la planification sont presque antagonistes, car en situation d’urgence, par définition, il n’y a pas de temps ni de possibilité de planifier. Cependant, il ne faut pas non plus tomber dans le piège de l’urgence continue, car cela serait naïf, coûteux et politiquement dangereux. Dans l’urgence, on doit déroger à de nombreuses règles. La législation nécessite du temps, des processus stricts, de la cocréation, mais c’est aussi le seul moyen d’avancer.
Que pouvons-nous apprendre de l’habitat dans les contextes d’urgence ?
Dans les contextes d’urgence, on apprend que retarder l’action réduit progressivement les options disponibles, jusqu’à ce qu’il n’en reste plus aucune. Les polycrises actuelles, y compris celle liée à l’environnement, nous enseignent qu’il est essentiel d’agir à temps, même en Europe, où, malgré les ressources, les villes ne sont pas prêtes à affronter les défis climatiques actuels et futurs.
Dans certaines zones du monde, les impacts environnementaux rendent progressivement des régions entières inhabitables. Le problème ne réside pas seulement dans l’augmentation des températures, mais dans la disparition des ressources vitales, ce qui pousse les gens à migrer. Cependant, l’attention mondiale se concentre plus souvent sur la protection contre les flux migratoires que sur des interventions à long terme pour prévenir les crises.
Un sol vivant
Même si nous le foulons quotidiennement et qu’il est indispensable à notre sécurité alimentaire, nous réfléchissons rarement à l’importance du sol dans nos vies. Quels rôles cruciaux le sol joue-t-il dans le maintien de l’équilibre des écosystèmes ? Comment le protéger ? Et en quoi les pratiques artistiques peuvent-elles être utiles ?
Ci-dessous, un entretien avec Karine Gondret, pédologue et géomaticienne de formation, collaboratrice scientifique HES-SO et enseignante à la Haute école du paysage, d’ingénierie et d’architecture de Genève (HEPIA). Ses recherches portent principalement sur l’évaluation de la qualité des sols et leur cartographie.
Qu’est-ce que la pédologie ?
La pédologie est l’examen des sols, c’est-à-dire l’étude des interactions entre le vivant, le minéral, l’eau et l’air qui ont lieu sous nos pieds. En pédologie, on se concentre sur tout ce qui se trouve entre la surface et la couche de minéraux purs, soit environ 1,50 m de profondeur sous nos latitudes. Au-delà, lorsque seuls les minéraux sont présents, on entre dans le domaine de la géologie. Le rôle du pédologue est aussi de cartographier les sols.
Qu’entend-on par un sol de bonne qualité ?
Grossièrement, un sol de bonne qualité est un sol qui est capable d’assurer les fonctions nécessaires à la survie de l’ensemble des êtres vivants et de leur environnement. Plusieurs fonctions sont très importantes, au-delà de la plus évidente, celle de production alimentaire ou de production de biomasse. Le sol assure des fonctions d’infiltration, d’épuration et de stockage de l’eau ou encore de recyclage des nutriments et des matières organiques. Il y a aussi la fonction de réserve génétique, qui est encore très peu étudiée. La clovibactine, par exemple, est un potentiel nouvel antibiotique qui a été découvert dans le sol. Il est donc crucial de protéger cette ressource.
Quels paramètres faut-il prendre en compte pour évaluer la qualité d’un sol selon ses fonctions ?
En général, on constate que plus la teneur en « matières organiques » d’un sol est élevée, plus il est capable d’assurer ses fonctions. On entend par « matières organiques » tous les êtres vivants (vers de terre, microorganismes, bactéries…) et toutes les composés riches en carbone issus du vivant (cadavres, excréments, racines, feuilles mortes, compost, exsudats racinaires et bactériens…). Un sol qui fonctionne, c’est un sol vivant, mais pas que! Il existe plusieurs autres paramètres essentiels, comme la profondeur du sol, le pH, la texture, la porosité… Selon la fonction à protéger, certains paramètres seront plus ou moins importants. Par exemple, la fonction de support des infrastructures humaines (routes, bâtiments, etc.) va inévitablement nuire à la fonction production de biomasse. C’est pour ça que les politiques doivent faire des choix dans les fonctions qu’ils souhaitent protéger.
Pourquoi la présence de matière organique dans les sols est-elle importante ?
Les matières organiques constituent la base de l’alimentation de la faune et des micro-organismes du sol. Elles sont continuellement décomposées par la vie du sol en nutriments accessibles aux végétaux via l’eau du sol. De plus, les matières organiques améliorent la porosité du sol. La porosité est essentielle au bon développement de la vie car elle permet à l’eau riche en nutriments, à l’air et aux racines de circuler. Sans cette porosité, les échanges se font beaucoup moins bien, et par conséquent, les fonctions sont beaucoup moins bien rendus.
De plus, les matières organiques sont capables d’augmenter la capacité du sol à stocker l’eau, et d’atténuer des épisodes d’inondation dans les villes qui se situent en aval. Elle peut aussi, par ses propriétés électriques, retenir des nutriments et des polluants. De plus, les matières organiques qui sont stabilisées dans le sol renferment environ 60% du carbone de la planète. Plus il y a de matière organique dans le sol, plus on limite le réchauffement climatique, car tout le carbone qui n’est pas stocké dans les sols part dans l’atmosphère sous forme de CO2. Pour finir, par rapport à il y a une cinquantaine d’années, la plupart des sols agricoles ont vu leur teneur en matière organique diminuer de moitié. Ce qui signifie que ces sols-là vont de moins en moins bien assurer les fonctions qu’ils nous rendent.
Nous avons parlé de ce qu’est un bon sol pour les humains, mais qu’en est-il du monde « plus qu’humain » ?
Dans la définition de l’Organisation mondiale pour l’alimentation et l’agriculture (FAO), le sol assure des fonctions indispensables à l’homme. Mais en vérité, ces fonctions sont indispensables au bon fonctionnement des écosystèmes et les humains en bénéficient simplement. Par exemple, de nombreux pollinisateurs ont une partie de leur cycle de vie dans le sol. Ces pollinisateurs permettent d’obtenir des fruits et de nourrir la faune, ce qui est bénéfique pour les milieux naturels. Mais ces fruits vont aussi profiter aux humains au sein des infrastructures agricoles et économiques, lorsqu’ils seront vendus. Les humains et l’environnement sont profondément interconnectés, bien que nous ayons tendance à l’oublier.
Images: Thierry Boutonnier, Comm’un sol, 2024. Photo: ©Eva Habasque.
Dans le cadre du projet de recherche Faire commun, l’artiste Thierry Boutonnier a imaginé une méthode pour évaluer de manière sensible la qualité des sols du Parc Rigot. Il a organisé un pique-nique sur une longue nappe en coton biologique, qui a ensuite été découpée en morceaux et enterrée dans différentes zones du parc. Après quelques mois, la nappe a été déterrée, et la quantité de tissu consommé grâce à la bioactivité du sol a fourni des informations concrètes sur ses caractéristiques. Qu’avez-vous observé ?
Nous n’avons pas encore terminé d’effectuer les analyses dans le parc Rigot, mais nous avons observé la capacité du sol à dégrader la matière organique à travers cette expérience. Dans le sol, les micro-organismes libèrent des enzymes qui dégradent la matière organique (ici la nappe en coton). Et nous avons observé que ces micro-organismes n’ont pas tous eu la même activité : certaines zones du parc ont été capables de dégrader la matière organique de manière très efficace, tandis que d’autres zones ont été beaucoup plus lentes. Cela signifie que dans ces zones, il y a moins de nutriments disponibles pour les plantes qui y poussent.
Souvent, on ne se rend pas compte qu’il y a une diversité de sols, même sur de petites surfaces. En ville, comme à Rigot, cette diversité est encore plus marquée, car l’homme a eu un impact très fort sur les sols. Il y a eu de nombreuses interventions – des zones ont été complètement renaturées, d’autres décapées ou ajoutées artificiellement – et cela a conduit à une juxtaposition de sols très différents. Le défi est d’identifier les zones qui fonctionnent vraiment et de les protéger.
Est-ce possible d’améliorer la qualité d’un sol ?
Quand un sol n’a pas la qualité nécessaire par rapport à une fonction, on peut intervenir pour l’améliorer, en apportant par exemple, de la matière organique ou en le décompactant (dans le respect du règlement de L’Osol en Suisse). Mais la qualité d’un sol ne s’améliore que très lentement, il faut parfois atteindre plusieurs générations humaines, parfois l’amélioration est impossible. En fait, il faut considérer que le sol est une ressource non renouvelable, car il met très longtemps à se créer : on dit qu’il augmente de 0,05 millimètre par an en moyenne. Dans les endroits très pentus, il devient même de plus en plus mince.
Il peut par ailleurs se détériorer rapidement. Il paraît solide, on le pense immuable, mais rien n’est moins vrai. Même lorsqu’on cherche à améliorer sa qualité, il faut être très précautionneux, car chaque intervention sur un sol entraîne une détérioration. C’est un processus délicat qui ne fonctionne pas toujours, on est dans l’expérimentation. Le sol, c’est l’intersection entre la physique, la biologie et la chimie. C’est un monde complexe duquel on ne sait de loin pas tout. C’est d’autant plus important de le protéger, car c’est là que se trouvent tous les nutriments des végétaux, qui en se développant forment la base de l’alimentation de tous les mammifères. Le sol est vraiment le lieu de la création de la vie.
Clôture et Pouvoir
« Nous supplions Votre Grâce afin qu’aucun seigneur d’un quelconque domaine ne puisse considérer les terres communes comme une propriété exclusive.
Nous demandons que tous les propriétaires libres ainsi que ceux qui détiennent des terres en concession puissent jouir pleinement des terres communes, en exerçant leurs droits sur celles-ci, et que les seigneurs ne puissent ni les utiliser ni en tirer profit.
Nous prions pour que les rivières restent libres et accessibles à tous pour la pêche et la navigation.
Nous demandons qu’il ne soit pas permis aux seigneurs d’acquérir des terres libres pour ensuite les relouer (…) en tirant de grands avantages personnels au détriment de vos pauvres sujets. »
Nous sommes le 6 juillet 1549. Les paysans de Wymondham, une petite ville du Norfolk en Angleterre, se révoltent. Ils traversent les champs pour abattre les haies et les clôtures des fermes et des pâturages privés, y compris le domaine de Robert Kett, qui, de manière surprenante, se joint aux protestations, donnant ainsi son nom à cette rébellion. Au fil de leur marche, ils sont rejoints par des ouvriers agricoles et des artisans venant de nombreuses autres villes et villages. Le 12 juillet, 16 000 insurgés campent à Mousehold Heath, près de Norwich, et rédigent une liste de revendications adressées au roi, comprenant celles mentionnées plus haut. Ils résisteront jusqu’à fin août, moment où plus de 3500 insurgés seront massacrés, et leurs chefs torturés et décapités. Mais qu’est-ce qui a provoqué cette insurrection ? Et pourquoi la répression a-t-elle été si sanglante ?
La soi-disant rébellion de Kett est une réaction à la pratique des « enclosures », c’est-à-dire la suppression des droits d’usage sur les terres communes. Ces terres, d’une grande importance économique et sociale, étaient gérées selon des règles et des limites établies par les communautés elles-mêmes, garantissant un équilibre entre leurs membres. Ces parcelles étaient utilisées pour le pâturage, la collecte de bois et de plantes sauvages, la fauche du foin, la pêche ou encore le passage, et incluaient même des terres agricoles partagées, où les paysans cultivaient de petites portions de terre réparties de manière éparse dans une division collective. Le système des terres communes contribuait donc à la subsistance des communautés et, en particulier, des plus démunis.
Avec les enclosures, les terres communes furent réorganisées pour créer de grands champs unifiés, délimités par des haies, des murs ou des clôtures, et réservés à l’usage exclusif des grands propriétaires ou de leurs locataires. Ce processus progressif d’appropriation des terres ne fut pas une exclusivité anglaise, mais un phénomène à grande échelle, généralisé sous diverses formes dans toute l’Europe (et encore plus violemment dans ses colonies) à partir du XVe siècle. C’est le phénomène que Karl Marx décrit dans Le Capital comme « l’accumulation primitive » : les travailleurs agricoles, privés de leurs moyens de production (la terre), sont contraints de travailler pour un salaire, ne possédant rien d’autre que leur force de travail. C’est l’un des éléments qui a conduit à l’émergence du capitalisme, un processus impliquant violence, expropriation et rupture des liens sociaux traditionnels.

Dessin: ©Anaëlle Clot.
Un autre aspect significatif des enclosures est leur impact sur le rôle des femmes. Jusqu’au Moyen Âge, une économie de subsistance prévalait en Europe, où le travail productif (comme le travail des champs) et reproductif (comme les soins) avaient une valeur équivalente. Avec le passage à une économie de marché, seul le travail produisant des marchandises fut considéré comme digne d’être rémunéré, tandis que la reproduction de la force de travail fut jugée dénuée de valeur économique. De plus, comme cela a été démontré, la perte des droits d’usage sur les terres communes a particulièrement affecté les catégories déjà discriminées, comme les femmes, qui trouvaient dans ces terres non seulement un moyen de subsistance, mais aussi un espace de relations, de savoirs et de pratiques collectives.
La chercheuse féministe Silvia Federici, dans son célèbre ouvrage Caliban et la sorcière : Femmes, corps et accumulation primitive, réfléchit au lien entre la privatisation des terres et l’aggravation de la condition féminine : « Dans l’Europe précapitaliste, la subordination des femmes aux hommes était atténuée par le fait qu’elles avaient accès aux biens communs et à d’autres ressources collectives (…). Dans la nouvelle organisation du travail, chaque femme devint un bien commun, car une fois les activités domestiques définies comme un non-travail, le travail féminin commença à être perçu comme une ressource naturelle, accessible à tous, tel l’air que nous respirons ou l’eau que nous buvons. (…) Avec ce nouveau contrat social et sexuel, les femmes prolétaires devinrent le substitut des terres que les travailleurs avaient perdues avec les enclosures, devenant ainsi leur principal moyen de reproduction. »
Les conséquences de cette exacerbation des rapports de force entre genres furent multiples : les femmes se retrouvèrent de plus en plus confinées à l’espace domestique, dépendantes économiquement et socialement de l’autorité masculine, et contrôlées dans la gestion de leur corps par des politiques démographiques indispensables à une société dépendante des flux de force de travail. Le contrôle du corps féminin, par la condamnation de la contraception et des savoirs traditionnels liés aux soins, devint central dans la société capitaliste naissante. La chasse aux sorcières, qui frappa des milliers de femmes en Europe et en Amérique, s’inscrit dans ce contexte de répression et de contrôle.
Dans les colonies européennes, des processus analogues d’expropriation et de violence furent justifiés par une rhétorique de domination des « sauvages ». Ce schéma, basé sur l’extraction de ressources et de travail à faible coût, se poursuit encore aujourd’hui : pensons à l’appropriation des terres indigènes dans le Sud global pour l’exploitation des ressources naturelles. Capitalisme et oppression sont les deux faces d’une même médaille.
Jean-Jacques Rousseau, dans son Discours sur l’origine de l’inégalité, écrivit : « Le premier qui ayant enclos un terrain s’avisa de dire : Ceci est à moi, et trouva des gens assez simples pour le croire, fut le vrai fondateur de la société civile. Que de crimes, de guerres, de meurtres, que de misères et d’horreurs n’eût point épargnés au genre humain celui qui, arrachant les pieux ou comblant le fossé, eût crié à ses semblables : Gardez-vous d’écouter cet imposteur ; vous êtes perdus si vous oubliez que les fruits sont à tous et que la terre n’est à personne ! »
La pensée de Rousseau dans ce livre n’est pas exempte de problématiques et alimentera, entre autres, le dangereux mythe du « bon sauvage », qui justifiera en partie le colonialisme. Pourtant, ces mots représentent un avertissement et un espoir, nous invitant à remettre en question les fondements mêmes de la société : les structures, les institutions, les systèmes économiques ne sont pas immuables. Le changement est toujours possible, à condition d’avoir le courage de l’imaginer.
L’automne du jardinier
Le jardinier, les mains plongées dans la terre et en contact constant avec les plantes, pourrait sembler avoir un métier idyllique face aux tracas urbains. Mais, selon Karel Čapek, rien ne pourrait être plus éloigné de la réalité. Dans son livre L’année du jardinier (1929), Čapek décrit une psychologie du jardinier pleine de problèmes, de tribulations, face au gel, à la sécheresse et aux ambitions démesurées des petits jardins urbains. Son récit, merveilleusement écrit et imprégné d’ironie, offre une réflexion sur la complexité de la nature humaine, non sans une pointe d’humour et de légerté. Nous vous proposons un bref extrait de ce livre ci-dessous.
On dit que le printemps est l’époque du bourgeonnement ; en réalité l’époque du bourgeonnement, c’est l’automne. Si nous regardons la nature, il est vrai que l’automne est la fin de l’année ; mais il est presque encore plus vrai que l’automne est le début de l’année. C’est une notion commune que les feuilles tombent en automne et je ne puis vraiment pas le nier ; je me contente de soutenir que, dans un certain sens, plus profond, l’automne est, à proprement parler, le moment où les feuilles poussent. Les feuilles se dessèchent parce que l’hiver arrive ; mais elles se dessèchent aussi parce que le printemps arrive, parce que de nouveaux bourgeons se forment, petits comme des capsules explosives qui libéreront le printemps. C’est une illusion d’optique qui nous fait voir les arbres et les arbustes dénudés, car ils sont parsemés de tout ce qui se révélera et se développera en eux au printemps. C’est une illusion d’optique que de voir les fleurs fanées en automne, car elles sont, au contraire, en train de naître. Nous disons que la nature se repose alors qu’elle va de l’avant sans voir ni entendre. Seulement elle a fermé sa boutique et tiré les rideaux ; mais derrière cette façade, elle déballe de nouvelles marchandises et les rayons se remplissent, jusqu’à plier sous le poids. Bonnes gens, c’est maintenant le vrai printemps ; ce qui n’est pas à point maintenant ne le sera pas non plus en avril. L’avenir n’est pas devant nous, car il est déjà sous les espèces de ce germe ; il est déjà parmi nous, et ce qui n’est pas à présent parmi nous n’y sera pas non plus dans l’avenir. Nous ne voyons pas les germes parce qu’ils sont sous la terre ; nous ne connaissons pas l’avenir parce qu’il est en nous. Parfois, il nous semble que nous sentons la pourriture, encombrés que nous pouvions voir tous les rejets gros et blancs qui se frayent un chemin à travers cette vieille terre de civilisation qui s’appelle « aujourd’hui », toutes les graines qui germent en secret, tous les vieux plants qui se rassemblent et se ramassent pour former un germe vivant, qui un jour éclatera pour créer une fleur vivante, si nous pouvions voir ce fourmillement caché de l’avenir au milieu de nous, il est sûr que nous dirions que notre mélancolie et notre scepticisme sont de grandes sottises et que le meilleur de tout, c’est d’être un homme vivant, je veux dire un homme qui croît.
Image: Natália Trejbalová, Few Thoughts on Floating Spores (detail), 2023.
Courtesy of the artist and Šopa Gallery, Košice. Photo: Tibor Czitó.

Comme la petite pierre est heureuse
Dans cette brève composition poétique, Emily Dickinson célèbre le bonheur d’une vie simple et indépendante, représentée par une petite pierre qui erre librement. Loin des soucis et des ambitions humaines, la pierre trouve le contentement dans son existence élémentaire. Écrit au XIXe siècle, le poème reflète la désillusion croissante face à l’industrialisation et à l’urbanisation, qui ont conduit beaucoup à aspirer à une vie plus modeste et significative.
Comme la petite pierre est heureuse,
Qui vagabonde seule sur les chemins,
Sans se soucier de sa carrière
Et sans craindre les lendemains ;
Sa robe d’un brun élémentaire
Offerte par un univers éphémère ;
Indépendante comme le soleil,
À d’autres elle s’unit ou seule étincèle,
Accomplissant son destin absolu
Dans une simplicité résolue.

Image: Altalena.
Ô noble Vert
Ô noble Vert, enraciné dans le soleil
et brillant d’une sérénité limpide,
dans le cercle d’une roue tournante
qui ne peut contenir toute la magnificence de la terre,
vous Vert, vous êtes enveloppé d’amour,
embrassés par le pouvoir des secrets célestes.
Tu rougis comme la lumière de l’aube
tu brûles comme les braises du soleil,
Ô nobilissima Viriditas.
Ce magnifique hymne à la puissance créatrice du vert est une réponse écrite et mise en musique à l’œuvre de l’un des esprits les plus brillants de l’Europe médiévale: Hildegarde de Bingen, une sainte et mystique chrétienne qui vivait en Rhénanie au début du XIIe siècle. Dixième fille d’une famille noble, Hildegarde est très tôt secouée par des visions et des migraines, raison pour laquelle elle est destinée au couvent dès l’âge de treize ans. Ce n’est qu’à l’âge de quarante-trois ans qu’elle avouera et décrira publiquement ses visions, poussée par un ordre divin; quelques années plus tard, elle fondera le monastère de Bingen, dont elle sera l’abbesse.
Les mérites d’Hildegarde sont innombrables: elle est la première compositrice occidentale dont nous ayons un témoignage écrit, et son œuvre musicale est la plus substantielle de l’époque à laquelle elle a vécu à nous être parvenue. Elle fut une excellente naturaliste: son puissant traité Physica comprend 230 chapitres sur les plantes, 63 chapitres sur les éléments, 63 chapitres sur les arbres, et bien d’autres sur les pierres, les poissons, les oiseaux, les reptiles ou encore les métaux, enrichis d’indications sur leurs propriétés médicinales: pour cette raison, certains la considèrent comme la fondatrice de la naturopathie. Ses homélies et ses discours, empreints d’un vitalisme révolutionnaire inconnu de la pensée ecclésiastique de l’époque, ont été encouragés et même publiés avec le soutien de puissants papes et prélats tels que Bernard de Clairvaux – un fait tout à fait exceptionnel dans le contexte profondément misogyne de l’Europe médiévale.
Hildegarde rencontre cependant une difficulté dans la description de ses visions: «Dans mes visions, on ne m’a pas appris à écrire comme les philosophes. De plus, les mots que je vois et que j’entends ne sont pas comme les mots du langage humain, mais sont comme une flamme brûlante ou un nuage qui se déplace dans l’air clair.» Comment transmettre l’indicible? Comment donner voix à des concepts nouveaux, inconnus des théologiens et des sages de l’époque? Comment critiquer la structure même de la pensée actuelle? Hildegarde ne choisit pas la facilité, mais décide d’inventer une véritable nouvelle langue, à laquelle elle donne le nom d’Ignota Lingua et qui est considérée comme l’une des premières «langues artificielles» jamais créées (Hildegarde est d’ailleurs considérée comme la patronne des locuteurs de l’espéranto). Il s’agit d’un glossaire de 1011 mots, pour la plupart transcrits en latin et en allemand médiéval avec l’aide d’un scribe.

Image: Hildegarde de Bingen, La hiérarchie des anges, Manuscrit de la sixième vision des Scivias.
Parmi de nombreuses inventions linguistiques merveilleuses, le concept de viriditas revient dans ses écrits. L’universitaire Sarah L. Higley tente une traduction: «La viriditas, “verdure”, “pouvoir verdoyant” ou même “vitalité”, est associée à tout ce qui participe de la présence vivante de Dieu, y compris la nature en fleurs, la sève même (sudor, “sueur”) qui remplit les feuilles et les pousses. Il est (…) étroitement associé à l’humiditas, l’humidité. Hildegarde écrit (…) que “la grâce de Dieu brille comme le soleil et envoie ses dons de manière variée : une manière en sagesse (sapientia), une autre en viridité (uiriditate), une troisième en humidité (humiditate)». Dans sa lettre à Tenxwind, elle compare la beauté virginale de la femme à la terre, qui exhale (sudat) la verdure ou la vitalité de l’herbe. L’aridité, en revanche, représente l’incrédulité, le manque de spiritualité, l’abandon des vertus dans leur verdeur: ce qui se fane et se consume au moment du Jugement.
Pour le regard intérieur de la mystique naturaliste, capable de scruter l’invisible dans le visible, toute la création est un flux de sève verte divine et jaillissante. Hildegarde attachait une grande importance à la couleur verte, symbole de vigueur, de jeunesse, de puissance de création, d’efflorescence, de fructification, de fécondation et de régénération. Célébrer le vert pour Hildegarde, c’est reconnaître que nous faisons partie d’un tout, sans séparation, et sert à maintenir la cohésion entre l’âme et le corps. Cette pensée radicale nécessite de nouveaux mots, de nouvelles façons de penser: inventer une langue est un geste qui permet de croire que tout peut être remis en question, tout peut être imaginé à partir de nouveaux postulats.
Voici une sélection du chapitre sur les arbres de l’Ignota Lingua: une invitation à tout (re)penser, en commençant par les mots les plus courants.
Lamischiz — SAPIN
Pazimbu — NÉFLIER
Schalmindibiz — AMANDE
Bauschuz — ÉRABLE
Hamischa — AULNE
Laizscia — TILLEUL
Scoibuz — BUXE
Gramzibuz — CHÂTAIGNIER
Scoica — CHARME
Bumbirich — NOISETIER
Zaimzabuz — COING
Gruzimbuz — CERISE
Culmendiabuz — CORNOUILLER
Guskaibuz — CHÊNE D’HIVER
Gigunzibuz — FIGUE
Bizarmol — FRÊNE
Zamzila — HÊTRE
Schoimchia — ÉPICÉA
Scongilbuz — FUSAIN
Clamizibuz — LAURIER
Gonizla — ARBUSTE?
Zaschibuz — PISTACHIER LENTISQUE
Schalnihilbuz — GENÉVRIER
Pomziaz — POMME
Mizamabuz — MÛRIER
Burschiabuz — TAMARIS
Laschiabuz — SORBIER
Golinzia — PLATANE
Sparinichibuz — PÊCHE
Zirunzibuz — POIRE
Burzimibuz — PRUNE
Gimeldia — PIN
Noinz — ÉPINE DU CHRIST
Lamschiz — SUREAU
Scinzibuz — GENÉVRIER SABINE
Kisanzibuz — COTONNIER
Vischobuz — IF
Gulizbaz — BOULEAU
Scoiaz — SAULE
Wagiziaz — SAULE
Scuanibuz — MYRTE
Schirobuz — ÉRABLE
Orschibuz — CHÊNE
Muzimibuz — NOYER
Gisgiaz — CROIX-DE-MALTE
Zizanz — ÉGLANTIER
Izziroz — ARBRE À ÉPINES
Gluuiz — ROSEAU
Ausiz — CIGÜE
Florisca — BAUME
La multiplicité des communs
Les domaines de recherche du philosophe suisse Yves Citton vont de la littérature à la théorie des médias, en passant par la philosophie politique. Nous l’avons rencontré dans le cadre de notre projet Faire Commun pour discuter d’un thème central de nos recherches : celui des biens communs. Vous trouverez ci-dessous la transcription d’une partie de son intervention.
J’aimerais présenter les « communs » en essayant de nuancer une certaine image, qui n’est pas fausse mais très partielle, des biens communs comme préexistant à l’appropriation humaine. Dans le récit classique, la Terre et ses biens étaient partagés par tous les animaux et tous les bipèdes sans plume comme nous. Ensuite, selon le deuxième discours de Rousseau, l’appropriation des territoires par l’humain devient la source de tous les maux.
Cela signifie que les communs sont donnés tels quels par la nature. Il est vrai que l’air qu’on respire, par exemple, n’a pas été créé par les humains pour qu’ils ne meurent pas asphyxiés : sur Terre, il y a de l’air, et nous, les humains, en bénéficions. Il s’agit d’une certaine couche des communs qui nous est naturellement donnée, même sans savoir exactement ce que la nature signifie.
Ensuite, si on passe de l’air à l’eau, on peut se dire que ce sont des communs similaires. Sur Terre, il y a de l’eau salée et non salée, qui est potable. Sauf que si on réfléchit à la réalité de l’eau aujourd’hui, l’eau que on boit est une eau plus ou moins naturelle. On sait qu’elle peut contenir du chlore, qu’il y a des tuyaux pour la faire venir. De fait, l’eau, à mon sens, n’est pas du tout un commun naturel. C’est le résultat d’une infrastructure, qui peut être publique, privée ou associative ; elle peut être démocratique ou soumise au capitalisme. Une médiation est effectuée par la collectivité ou les institutions publiques. Afin de distinguer les biens communs, publics et privés, j’appellerais ce cas de figure plutôt le public – un État est intervenu, fait des réglementations et finance les tuyaux.
Il s’agit toujours d’un commun, mais qui a été construit par les humains, les législations, les processus politiques. La plupart du temps quand on parle de commun aujourd’hui, ces éléments y sont forcément mêlés. Même les forêts ne ressemblent plus à ce qu’elles étaient avant que les humains y amènent des espèces domestiquées, des technologies. Il me semble donc plus réaliste de dire que les communs sont toujours liés à une dimension d’artificialisation humaine, et de préservation. Nous n’avons pas forcément besoin de prendre soin de l’air, il suffit de ne pas le polluer, mais nous devons préserver l’eau, les tuyaux, les infrastructures.
Il est intéressant de considérer un autre modèle un peu différent de communs : la langue. La langue ne précédait pas les humains, il n’y avait pas de langue française il y a 300 000 ans ; ce n’est pas une institution, ni une infrastructure réglementée par un État qui en prend soin et l’entretient. Le français réside à la fois dans nos têtes et entre nos têtes. À mes yeux, c’est le modèle le plus bizarre et extraordinaire du commun, qui n’existe que parce que nous le possédons : si tous les gens qui parlent français venaient à disparaître, il n’y aurait plus de français. (Si on ne prend toutefois pas en compte les livres écrits en français qui, eux, resteraient.) Savoir où se situe un commun, s’il est artificiel ou public, n’est pas une tâche aisée. Pour moi, ce que la langue met en évidence des communs, c’est le fait qu’elle peut exister sans régulation officielle. Ce n’est pas l’Académie française qui crée la langue française. La langue se reproduit par la culture, par le fait que les enfants parlent aux parents. C’est un commun : elle n’est ni totalement publique, ni totalement privée.

Image: Mattia Pajè, Il mondo ha superato se stesso (again), 2020
La langue française, l’air et l’eau sont des éléments nécessaires à notre survie, et nous sommes reconnaissants qu’ils soient à notre disposition : nous pouvons les définir comme des communs positifs. Il existe en revanche les communs négatifs, qui sont une continuation et une inversion de ces derniers. Les chercheurs Alexandre Monnin, Diego Landivar et Emmanuel Bonnet proposent le terme de commun négatifs pour parler des déchets nucléaires, pour ne citer que l’exemple le plus parlant. Qu’une centrale nucléaire ait un statut public ou privé ne change rien au fait que les déchets qui en résultent deviennent un problème collectif pour les centaines de milliers d’années qui suivent. Il est évident que les déchets nucléaires sont un commun, tout comme le plastique et le climat aujourd’hui. Le climat est en effet en train de devenir comme l’eau, un élément qu’il va falloir entretenir pour qu’il reste vivable. Certains communs négatifs se mêlent donc aux communs qui étaient traditionnellement vus comme positifs. Ces communs négatifs posent un problème majeur : ils permettent de nourrir nos existences (la centrale nucléaire nourrit mon ordinateur qui me permet de communiquer) mais pourrissent nos milieux de vie. Nourrir et pourrir, comme les deux faces d’une même pièce, d’un seul et même geste. L’énergie nucléaire me nourrit en électricité mais pourrit les générations à venir par la production de radioactivité.
En développant cette idée, on peut envisager la finance comme un bon exemple de commun négatif : la finance nourrit nos investissements, nourrit le budget de l’État, mais pollue nos environnements en poussant à maximiser les profits aux dépens des considérations environnementales. Comment s’en sortir ? Comment démanteler la finance ? Il est en outre encore plus intéressant de se demander si l’université n’est pas un commun négatif : il y a des connaissances, des recherches qui se font, mais son fonctionnement peut être toxique, comme avec des professeurs qui profitent de leur pouvoir sur leurs étudiants, par exemple. Ou alors toute la bureaucratie qui nous empêche de faire du bon travail en même temps qu’elle encadre ce travail et le structure. Il y a des éléments toxiques qu’il est nécessaire de démanteler, mais ce n’est pas chose aisée car ces derniers nous nourrissent. Il est donc particulièrement révélateur de faire l’exercice intellectuel de projeter une hypothèse de commun négatif sur différents sujets.
Il existe par ailleurs le concept de sous-communs, un terme défini par le poète et philosophe afro-américain Fred Moten et l’activiste et chercheur Stefano Harney. Ce terme, Undercommons en anglais, se base sur les idées politiques de la Black Radical Tradition aux États-Unis. La surreprésentation des personnes noires, en particulier des hommes noirs dans les prisons aujourd’hui aux États-Unis est dramatique, et on observe une continuité entre l’esclavage d’il y a quelques siècles et la domination raciale dans ce pays aujourd’hui. Les personnes qui sont sorties de la cale esclavagiste n’ont jamais été considérées comme des individus à part entière. Elles ont alors dû développer d’autres modes de socialité, d’alternatives à la socialisation individualiste de l’homo economicus, du petit chef d’entreprise, du bourgeois blanc. Les communautés qui ont subi des menaces de lynchage jusqu’à il y a quelques décennies et qui sont victimes aujourd’hui de violences policières, vivent dans des conditions de marginalisation ou ne jouissent en tout cas pas de la socialisation dont vous et moi, en tant que Blanc en Suisse ou en France, avons pu bénéficier. Ces personnes ont donc développé une forme de socialisation alternative, souterraine, dans une incarnation de communs très riche : une sorte de solidarité paralégale ou à moitié légale, car la loi est faite par les Blancs pour les Blancs. Au lieu d’envisager cette solidarité comme illégale, elle peut s’envisager comme une autre forme de solidarité, soustraite à la loi, qu’il est intéressant d’étudier, de respecter. Elle permet des formes de vie qui nourrissent les communs, même si elles sont moins visibles. Et elle pourrait s’avérer cruciale pour nous tous : il se peut que les infrastructures qui nourrissent nos luxes et nos formes d’individualisation économique et sociale, telles qu’on les connaît aujourd’hui, ne durent pas indéfiniment. On aurait ainsi intérêt à se familiariser avec les solidarités de survie que proposent les sous-communs. Et bien entendu, avant cela, il est important de dénoncer et de lutter contre les formes persistantes d’oppression qui pèsent sur les populations marginalisées.
J’ai eu l’occasion de travailler avec Dominique Quessada, qui a eu l’idée de jouer avec le terme de commun en proposant de l’écrire comme-un : sa réflexion étant que le commun appartient à tout le monde et à personne à la fois. Le fait même de parler de commun présuppose peut-être que le terme fait partie du discours, qu’il y a des gens qui envisagent le commun, et que derrière la dissolution de l’identité et de la propriété, les communs sont quelque chose auquel chacun peut participer : c’est le pluriel, ce n’est ni à moi, ni à toi. Surtout, écrire comme-un, c’est suggérer que l’unité (d’un certain peuple, d’une communauté) qui est souvent profilée à l’horizon des communs n’est peut-être qu’un « faire-comme-si nous étions un ». Face à des communs, nous agissons « comme-un » mais nous restons divers, différents, et parfois antagonistes entre nous.
Derrière les communs se cachent toujours deux notions. Il y a tout d’abord un principe d’unité : qui sont ceux qui parlent de « commun » ? Sur quoi se basent-ils ? En réalité, ils peuvent défendre un commun uniquement parce qu’ils sont déjà unis, que ce soit de l’extérieur ou de l’intérieur. Ensuite, le commun est toujours une fiction collective : appeler quelque chose un « commun » fait qu’on l’envisage en tant que tel et qu’il développe ainsi des propriétés de commun. Un parc public est un parc public, parce qu’on décrète que c’en est un. Avec cette étiquette de bien commun, il est possible de faire dans ce parc des choses qui auraient été impossibles autrement. Mais cela reste une fiction temporaire (un « comme-si ») : un changement de régime, une vente, une occupation du lieu est toujours possible. En résumé, écrire « comme-un » avec un trait d’union, revient à poser deux questions. Premièrement, quelle est l’unité, aussi disparate soit-elle, qui nous permet de dire qu’il y a un commun ? Et deuxièmement, quelle est la part de fiction, la dynamique qui nous permet de forger un concept qui n’existe pas ? La dimension imaginaire du commun reste toujours centrale dans sa défense.
L’expérience du paysage
Dans le langage courant, le terme «paysage» englobe diverses notions : il peut désigner un écosystème, un panorama, voire une ressource économique. Il est cependant possible de mieux cerner et aborder la complexité de ce terme en se fondant sur le concept «d’expérience».
En effet, l’expérience nous met en contact avec un dehors, une altérité : dans ce contexte, le paysage n’est plus considéré comme un objet, mais plutôt comme une relation entre la société humaine et l’environnement. De plus, l’expérience nous touche émotionnellement; elle nous bouscule et nous transforme. Une telle perception du «paysage» permet de réaliser combien il donne du sens à nos vies individuelles et collectives, au point que sa transformation ou sa disparition entraîne l’effacement de repères sensibles de l’existence dans la vie de ses habitant·e·x·s. L’expérience peut également être vue comme une forme de connaissance pratique ou de sagesse. C’est le type de savoir que l’on acquiert en vivant dans un endroit, qui fait que les personnes qui habitent un paysage en deviennent les expert·e·x·s. Enfin, l’expérience, c’est aussi une forme d’expérimentation : c’est l’aspect actif de notre relation avec le monde, qui nous permet de découvrir et de créer de nouvelles connaissances et de matérialiser ce qui n’est encore que potentiel.
On peut pousser ces réflexions encore plus loin et soutenir que les êtres humains vivent de paysage—une affirmation qui peut sembler hyperbolique, mais qui prend tout son sens si on y prête attention. En effet, le paysage est la source de notre alimentation : nous habitons dans le paysage et ce dernier active en nous des représentations et des émotions. Nous entretenons une relation dynamique avec le paysage : en le modifiant, nous nous transformons aussi. Il est donc impossible d’éviter d’entrer en relation avec le paysage. Le choix même d’ignorer ou de ne pas «faire l’expérience» d’un paysage a des conséquences pratiques et symboliques.
C’est à partir de ces observations que Jean-Marc Besse a écrit «La nécessité du paysage» : un essai sur l’écologie, l’architecture et l’anthropologie, mais aussi une invitation à remettre en question nos modes d’action «paysagistes». Le philosophe français nous y met en garde contre toute action sur le paysage : une attitude qui nous place «à l’extérieur» dudit paysage, ce qui, comme mentionné ci-dessus, n’est tout simplement pas plausible. Agir sur un paysage signifie le fabriquer, c’est-à-dire partir d’une idée préconçue qui ne tient pas compte du fait que le paysage est un système vivant et non un objet inerte. «Agir sur met donc en œuvre un double dualisme, séparant d’une part le sujet et l’objet et, d’autre part, la forme et la matière».
Comment alors échapper à ce paradigme productif et falsifiant? Jean-Marc Besse propose un changement de perspective : il s’agit de passer de l’action sur à l’action avec, reconnaissant «dans la matière une sorte d’animation» et l’envisageant «comme un espace de propositions potentielles et de trajectoires possibles». Le but, dans ce cas, est d’interagir «de manière adaptative et dynamique», de pratiquer la transformation plutôt que la production. Agir avec signifie mettre en œuvre une négociation continue, rester ouvert à l’indétermination du processus, être en dialogue avec le paysage : en un mot, collaborer avec ce dernier.

Georg Wilson, All Night Awake, 2023
Agir avec le sol
La dimension «abiotique» du sol est abordée, entre autres disciplines, par la topographie, la pédologie, la géologie et l’hydrographie. Cependant, d’un point de vue philosophique, le sol n’est autre que le support matériel sur lequel nous vivons. Nous y construisons les bâtiments dans lesquels nous habitons et les routes que nous empruntons et c’est le sol qui rend possible l’agriculture, l’une des manifestations fondamentales, les plus anciennes et les plus complexes, de l’activité humaine. Ce sol «banal» est donc en réalité le foyer de toute une série de questions politiques, sociales et économiques primordiales et, en tant que tel, il soulève des questions essentielles. De quel type de sol, d’eau ou d’air veut-on? Les catastrophes environnementales liées à la crise climatique et à l’érosion des sols ou les conséquences de la perte de fertilité des terres agricoles et forestières imposent des réponses collectives qui mobilisent à la fois les connaissances scientifiques et les compétences techniques, ainsi que de nombreux aspects politiques et éthiques.
Agir avec les vivants
Les paysages que nous habitons, traversons et modifions (y compris le sol et le sous-sol) sont à leur tour habités, traversés et modifiés par d’autres êtres vivants, animaux et végétaux. Le philosophe Baptiste Morizot, dans son essai «Sur la piste animale», nous invite à cohabiter «dans la grande ‘géopolitique partagée’ du paysage» en essayant d’emprunter le point de vue «des animaux sauvages, des arbres qui communiquent, des sols vivants qui travaillent, des plantes alliées du potager permacole, pour voir par les yeux et se rendre sensible à leurs us et coutumes, à leurs perspectives irréductibles sur le cosmos, pour inventer des milliers de relations avec eux». Pour interpréter correctement un paysage, il est nécessaire de prendre en compte la «puissance agissante des êtres vivants» avec leur spatialité et temporalité et d’intégrer notre relation avec eux.
Agir avec les autres humains
Le paysage est une «situation collective» qui concerne également les relations interhumaines dans leurs différentes formes. Le paysage est lié aux désirs, aux représentations, aux normes, aux pratiques, aux histoires, aux attentes et il mobilise des émotions et des positions aussi diverses que le sont les volontés, les expériences et les intérêts des personnes. Agir avec les autres êtres humains signifie agir avec un ensemble complexe qui inclut des individus, des communautés et des institutions; mobiliser le champ pratique et symbolique — dans une négociation et une médiation continue.
Agir avec l’espace
Considéré à travers les outils de la géométrie, l’espace est une entité objective : on peut décrire de manière satisfaisante ses dimensions, ses proportions ou ses limites. Cependant, l’espace du paysage ne peut être défini par de simples critères de mesurabilité. En réalité, il s’agit d’un espace intrinsèquement hétérogène : «les localisations, les directions, les distances, les morphologies, les façons de les pratiquer et de les investir économiquement et émotionnellement n’y sont pas équivalentes spatialement ni qualitativement». Interpréter correctement l’espace du paysage signifie donc se rappeler que les mesures «numériques» ou «géométriques» sont nécessairement fallacieuses et que l’ensemble de géographies (économique, sociale, culturelle ou personnelle) qui le composent ne sont ni neutres, ni uniformes, ni fixes dans le temps.
Agir avec le temps
Lorsqu’on pense à la relation entre le paysage et le temps qui passe, la première image qui vient à l’esprit est celle de la croûte terrestre et des couches géologiques qui la composent ou celle de ruines archéologiques enfouies sous la surface. En somme, on imagine une sorte de «palimpseste» ordonné d’un temps passé, avec lequel toute relation est close. Le temps du paysage, cependant, doit être interprété selon des logiques plus complexes : il suffit de penser à la persistance des pratiques et des expériences dans son contexte et au fait que la destruction du paysage n’est jamais totale : il s’agit toujours d’une transformation. De plus, le temps du paysage comprend également des échelles de temps non humaines, qui demeurent incommensurables à nos yeux, telles que la géologie, la climatologie, la végétation : des temporalités auxquelles nous sommes néanmoins étroitement liés. Ainsi, le paysage reste en réalité en tension constante entre passé et présent.
«Notre époque», conclut Jean-Marc Besse, «est celle d’une crise de l’attention. […] Le paysage semble être, dans cette époque de crise de la sensibilité et de l’expérience, l’un des ‘lieux’ où la perspective d’une ‘correspondance’ avec le monde peut être retrouvée […]. En d’autres termes, le paysage […] peut être envisagé comme un dispositif d’attention au réel, et donc comme une condition fondamentale de l’activation ou de la réactivation d’une relation sensible et significative avec le monde environnant» : une fois de plus, la nécessité du paysage.
Heidi 2.0
En 1668, Johannes Hofer décrivait, dans sa thèse de médecine à l’université de Bâle, un curieux trouble physique et mental qui affectait les mercenaires suisses au service du roi de France Louis XIV. À cette affection, dont les symptômes étaient des pensées noires, des crises de larmes, de l’anxiété, des palpitations, de l’anorexie, de l’insomnie et un désir obsessionnel de retour dans son pays natal, le médecin alsacien donnait le nom de «nostalgie» : un néologisme inventé en combinant les mots grecs nostos (retour à la maison) et algìa (douleur). Dans des études ultérieures, l’origine de la nostalgie était attribuée à de prétendues lésions cérébrales causées par le son des cloches sur le cou des vaches en pâture ou à l’effet de l’écoute de chants de montagne qui plongeaient les jeunes Suisses éloignés de leur terre natale dans un état prostrant de delirium melancholicum.
Le fait que des gardes suisses soient à l’origine de l’invention du mot «nostalgie» n’est pas une coïncidence : en effet, les vallées alpines ont subi de multiples vagues d’émigration et de dépeuplement depuis l’Antiquité, avec une intensité et des causes différentes selon la période. Ce n’est toutefois qu’après la Seconde Guerre mondiale que le phénomène migratoire devient habituel, se transformant même en véritable hémorragie. Les villes offrent des emplois plus stables, indépendants des conditions climatiques et des saisons, ainsi qu’une gamme de services et d’opportunités sans commune mesure avec la vie dans les vallées et les maigres revenus tirés des produits de la montagne. Les administrations locales ne voient pas d’autres solutions: il faut investir dans des infrastructures hôtelières rentables, en lien avec le tourisme et le ski, ou accepter ce dépeuplement. Or, le tourisme hivernal s’accompagne d’un processus rapide d’urbanisation qui remodèle le paysage montagnard.
Dès les années 1960, les stations de ski, les hôtels et les résidences secondaires prolifèrent donc de façon incontrôlée, répondant à la demande de consommation et de loisirs des classes moyennes urbaines. Et c’est précisément cette relation entre une vie urbaine de moins en moins vivable et une représentation idéalisée des Alpes qui est à l’origine de ce mouvement : la Suisse se présente déjà sous cet angle aux premiers touristes britanniques et américain·e·x·s au XIXe siècle, incarné par l’atmosphère arcadienne de «Heidi», le roman de Johanna Louise Spyri, publié en 1880 et voué à marquer l’imaginaire alpin jusqu’à nos jours. Alors que le roman de Johanna Louise Spyri tente de problématiser de manière complexe le changement des modes de vie dans les Alpes résultant de l’industrialisation, la narration dominante autour de la figure de Heidi se concentre sur une tension non résolue entre la ville et la montagne, représentant la vie de Heidi comme saine et «naturelle» par rapport à celle de sa cousine Klara, malade et piégée dans l’artificialité des habitudes urbaines. Cette interprétation erronée témoigne d’une distinction entre nature et culture qui nuit profondément à la capacité d’aborder de manière réaliste les modèles de développement des Alpes.
Parallèlement aux infrastructures hôtelières, de nouvelles routes asphaltées se dessinent, réduisant ainsi la mobilité capillaire qui, pendant des siècles, a uni les petites localités des vallées entre elles. Comme le raconte Marco Albino Ferrari dans son «Assalto alle Alpi» (L’Assaut sur les Alpes), «la voiture, paradoxalement, a rendu les montagnes moins habitables et plus éloignées. Le domaine dans lequel vivait de nombreuses espèces s’est retrouvé comprimé le long des axes du système routier principal, dans une forme d’urbanisme linéaire où tout doit être à portée de moteur. […] Le centre devient le fond de la vallée, à côté de la rivière canalisée pour éviter toute inondation et réduire les zones inutilisables des plaines inondables. Et c’est dans cette géographie mentale inversée par rapport aux siècles précédents que les versants des vallées deviennent de plus en plus sauvages, inconnus et éloignés de tout. La montagne se divise intérieurement et perd ces versants; ces espaces de moyenne altitude qui, dans l’expérience indigène, constituaient le cœur du système montagneux deviennent synonymes de terres de haute altitude, où la neige permet une consommation ludique du territoire à la verticale.»
Une cinquantaine d’années plus tard, on se rend compte que la redistribution espérée des opportunités et des richesses entre les communautés locales est en fait un mirage destiné à s’inverser en l’espace de quelques années. Les capitales du ski qui polarisent le regard du grand public ne sont qu’une partie minoritaire des 6 100 communes des Alpes : une poignée de noms parmi une multitude souvent inconnue de villes et de villages marqués par l’isolement et l’oubli. Le dépeuplement que l’on voulait éviter a pris de l’ampleur, se transformant en véritable exode. Dans certaines vallées intérieures, la naissance d’un enfant ou l’emménagement d’un jeune couple devient un fait marquant.

EPFL, École polytechnique fédérale de Lausanne, Modèle des Alpes, Lausanne, Suisse. Extrait du film Alps. ©Armin Linke, 2001.
D’autre part, même les stations de ski les plus célèbres ne sont plus en sécurité. La masse glaciaire des Alpes a diminué de 50 % depuis le début du XXe siècle, les chutes de neige sont de plus en plus rares et les températures augmentent. Le déplacement de la ligne d’enneigement a laissé les petites stations de ski de basse altitude dans un état d’abandon et de dépression, auquel elles réagissent par des travaux palliatifs, en déplaçant les remontées mécaniques quelques centaines de mètres plus haut ou en multipliant les canons à neige artificielle. Si de telles opérations ne sont que des palliatifs destinés à colmater les brèches pour quelques saisons supplémentaires, on en arrive même à des gestes grotesques comme le creusement d’une piste de ski dans un glacier, comme ce fut le cas récemment pour le glacier du Théodule à Zermatt à l’occasion de la Coupe du monde de ski. On répond à la crise de l’industrie du ski par un acharnement thérapeutique plutôt qu’en proposant des alternatives.
Depuis deux décennies, l’économie fondée sur les sports d’hiver et l’or blanc est en crise, comme le sont les modèles de consommation urbains qui la sous-tendent. Une nouvelle approche de la montagne est en train de naître, celle du «minimalisme alpin», qui privilégie la frugalité du refuge de montagne et le «slow tourism», comme une solution antimoderniste à la station d’altitude. Si cette nouvelle transformation a le mérite d’éviter les dysfonctionnements liés à la coupure nette entre haute et basse saison, il s’agit là encore d’une déformation. Avec l’apparition de vieux outils agricoles sur les façades des chalets (pas toujours d’origine locale), de chaudrons de cuivre suspendus dans les restaurants ou de vêtements traditionnels pour habiller les serveur·euse·s est né ce que l’anthropologue Annibale Salsa appelle «l’exotisme de proximité», soit une forme d’authenticité posturale et anti-technologique— Heidi en version 2.0, en d’autres mots.
Cette approche est paradoxale, même à première vue. Dans «Fragments d’une montagne», Nicolas Nova décrit le paysage de Conches, dans le Haut-Valais : «Dans ce coin des Alpes où le Rhône n’est encore qu’une petite rivière proche de sa source, une quantité de réseaux parcourent la vallée : câbles électriques aériens, routes, tunnels et voie sommitale accessible uniquement en été, voie ferrée du Matterhorn-Gotthard Bahn (qui transporte autant les passagers que les véhicules en ferroutage pour éviter le col de la Furka), pistes de ski de fond ou de raquettes constellées de panneaux orange Swissgas rappelant la présence du gazoduc souterrain. Impression d’observer une montagne-machine, avec cette ossature technique qui convertit l’environnement en infrastructure productive. Hybridation façon Victor Frankenstein, faite de géologie et de pylônes électriques, de cavités, de rails, de barrages, de bunkers plus ou moins vigoureux, de téléphériques, de tuyaux, de routes, d’antennes de téléphonie mobile ou de rivières au cours rectifié. La montagne-machine, un motif récurrent dans les Alpes, avec les cours d’eaux, les fonds de vallée, les reliefs recouverts de tout cet appareillage».
L’anthropisation des Alpes n’est pas un phénomène nouveau : pendant des milliers d’années, l’espèce humaine a habité cette chaîne de montagnes, s’accommodant ingénieusement de la rareté des ressources et des complications de la vie sur les pentes, trouvant des solutions spécifiques pour coexister en symbiose avec les autres espèces de son écosystème. Aujourd’hui, en raison de la disparition des pratiques traditionnelles d’agriculture et d’élevage au profit du tourisme, les étendues sauvages dans les Alpes sont aussi importantes qu’elles l’étaient au Moyen-Âge. Malgré cela, l’équilibre du passé s’est rompu, si l’on accepte que le récit public est au service de ceux qui sont convaincus que les Alpes doivent être «valorisées» et qu’elles ne sont pas une valeur en soi. Comment retrouver un regard honnête et réaliste sur la montagne ? Comment revenir à l’habiter au lieu de l’exploiter ? Si un sentier n’est pas parcouru, il disparaît en peu de temps. La dégradation des sentiers n’est pas due à la sur-fréquentation, mais à l’oubli.
Écouter le levain
Un entretien sur les pratiques coopératives et la façon d’inclure le plus-qu’humain avec Marie Preston, artiste et maîtresse de conférences à l’université Paris 8 Vincennes-Saint-Denis (Laboratoire TEAMeD / AIAC). Son travail artistique prend la forme d’une recherche visant à créer des œuvres et des documents d’expérience avec des personnes qui ne sont pas, a priori, des artistes. Ces dernières années, ses recherches ont porté sur la pratique boulangère, les écoles ouvertes et les pédagogies libertaires et institutionnelles, ainsi que sur les femmes travaillant dans le secteur du soin et de la petite enfance.
Qu’apportent les pratiques cocréatives par rapport à la participation politique ou sociale ?
Selon la philosophe Joëlle Zask la participation en politique devrait être une combinaison entre prendre part, apporter une part et recevoir une part. Les pratiques artistiques coopératives ouvrent des espaces propices aux échanges et au partage d’expériences et d’opinions, ce qu’on retrouve aussi dans les pratiques politiques par ailleurs. Cependant, la participation politique vise un but explicite, contrairement à beaucoup de pratiques artistiques coopératives qui débutent de manière «indéterminée». Leurs visées ne cessent de se transformer au fil des rencontres. C’est bien là la dimension plastique des formes relationnelles qui sont inventées dans ces pratiques.
Ensuite, le fait de rendre compte de ces expériences communes par une forme artistique sensible est évidemment la différence centrale par rapport à la participation exclusivement politique ou sociale. Il y a cependant une autre singularité notable : les groupes sont hétérogènes et la pratique fonctionne véritablement quand la singularité de chacune des voix qui constituent le collectif émerge et rend compte de la complexité. C’est une vraie richesse par rapport à d’autres formes de participation.
Pourquoi avez-vous choisi d’utiliser les termes «pratiques coopératives» ?
La cocréation est une forme de participation selon laquelle des participant·e·x·s, qui constituent un collectif, dirigent un projet artistique de manière coopérative et définissent dès l’origine ce qu’iels vont faire ensemble. L’artiste ne joue pas un rôle spécifique dans la définition de l’action, alors que, dans les pratiques coopératives, l’artiste est à l’origine de la proposition avant même l’implication des subjectivités réelles des participant·e·x·s. En vérité cependant, ce n’est jamais si simple : les deux modes de participation sont étroitement imbriqués.
Comme ce sont des processus qui s’étendent sur le temps long, avec différents niveaux d’implication, on passe parfois d’une phase où l’artiste porte le projet à une autre où le groupe s’autonomise et ainsi de suite. Il y a une certaine mobilité entre les différentes formes de participation. Je parle donc plutôt de coopération, qui laisse les diverses voix et subjectivités se mettre en avant à différents moments, plutôt que de cocréation, qui laisse moins de place à la mobilité des places et des fonctions.
Comment la nouvelle prise de conscience des subjectivités plus qu’humaines influence-t-elle les pratiques coopératives ?
Prenons l’exemple de «Levain», un projet de recherche participative dans lequel je suis impliquée en tant qu’artiste et qui réunit des scientifiques, des paysan·e·x·s boulanger·ère·x·s, des artisan·e·x·s qui ne produisent pas leur blé et des formateur·trice·x·s en boulangerie.
Ce groupe se réunit afin d’identifier l’impact de l’environnement et de l’histoire du fournil sur la biodiversité des levains. On savait au préalable que le levain des paysan·e·x·s boulanger·ère·x·s était d’une grande richesse biologique, une richesse alimentée notamment par les outils et les mains des boulanger·ère·x·s qui le manipule. Il y a là une relation véritablement sympoïétique pour reprendre Donna Haraway. La recherche consiste à savoir jusqu’où le levain se nourrit pour acquérir cette importante diversité microbienne.

Image: Fournil La Tit Ferme, 2022 © Marie Preston
Dans cette recherche, la question s’est-elle posée de savoir comment recueillir la voix du levain ?
Tout à fait. Cependant, avant cela, il y a eu tout un travail de réflexion sur la construction d’un langage commun entre scientifiques, paysan·e·x·s, boulanger·ère·x·s ou artistes – qui s’expriment chacun avec un vocabulaire particulier. Après cela, nous avons tenté de définir nos modalités de relation à cette entité vivante. Nous étions touxtes conscient·e·x·s que celle-ci nécessite un entretien particulier. Cependant, on s’est vite rendu compte que le levain nous entretient également, c’est-à-dire que sans le levain, le pain que l’on mange n’aurait pas la qualité qu’il a. La réciprocité – ce soin mutuel en quelque sorte – est donc très importante.
Ensuite, il nous est apparu qu’on ne pouvait pas faire parler le levain – il n’est pas doué de parole. En revanche, on a essayé de se projeter : si le levain était un animal ou une plante, quel serait-il? En répondant à cette question, chacun·e·x raconte ce qu’iel projette sur son propre levain. Les exemples cités révèlent des rapports très différents : de domestication pour certain·e·x·s, de cohabitation ou d’amitié pour d’autres. Se projeter conduit également à des formes d’anthropomorphisation, ce qui réduit la distance même si cela peut apparaître problématique à certains égards.
Enfin, il y a la question de la qualité d’écoute et d’observation. Dans le monde animal, on parle d’éthologie pour étudier les comportements, mais on peut aussi parler d’éthologie végétale, qui implique ici une attention particulière aux réactions du levain. Ce type d’écoute s’intéresse à la pratique du vivant, la pratique boulangère ici. Le travail scientifique consiste à mettre en place des protocoles d’expérimentation qui permettent de comprendre ce que certain·e·x·s boulanger·ère·x·s savent intuitivement. On ne cherche donc pas à faire parler le levain mais on tente activement de l’inclure dans la recherche.
L’intérêt croissant pour les pratiques participatives ou cocréatives est-il lié au besoin de nouveaux imaginaires ? Dans un monde en transition, quel est le rôle des pratiques cocréatives ?
Les pratiques artistiques coopératives permettent d’aborder des questions sociétales et politiques de façon différente, d’ouvrir des imaginaires et de le faire collectivement. Cet acte collectif permet également de lutter contre l’angoisse que génère le fait d’être seul chez soi face à la crise climatique ou à la disparition des espèces et de devenir acteur·trice·x plutôt que simple spectateur·trice·x.
Qu’en est-il de l’intérêt manifesté par les institutions ?
L’intérêt de ces pratiques par les institutions est assez présent dans la critique des pratiques coopératives, par le fait qu’elles contribueraient à légitimer le désengagement des États vis-à-vis des services publics.
Les associations ou centres d’art qui accompagnent ces pratiques peuvent proposer une réponse à cette question d’instrumentalisation qui permettrait de la minimiser, voire de la prévenir en suggérant que le groupe soit lui-même en situation «d’inventer institutionnellement». En d’autres termes, on peut y travailler en proposant des «contre-institutions» pour la transformer. Je pense que les pratiques artistiques coopératives – parce qu’elles sont en réflexion constante sur leur propre modalité relationnelle – peuvent aussi agir sur la structure qui leur permet d’exister, si elles en ont l’envie.

Image: Bermuda, 2022 © Marie Preston
Le soutien du public aux pratiques participatives, jugées en termes éthiques plutôt qu’esthétiques, est souvent justifié en termes d’impact social. Quels sont les risques sous-jacents de cette perspective ?
En 2019, nous avons coordonné un livre, «Cocréation» avec Céline Poulin et Stéphane Airaud, dans lequel nous dédions un chapitre entier à la question de l’évaluation de ces pratiques. Ce n’est pas parce qu’un projet est financé pour avoir un impact social ou pour être exclusivement artistique qu’il ne faut l’évaluer qu’à travers ces filtres. Bien entendu, les artistes vont chercher à faire de l’art, les chercheur·euse·x·s vont vouloir trouver des réponses scientifiques, une personne de la société civile va vouloir se divertir, faire de l’art ou trouver des réponses scientifiques : il est essentiel de trouver des manières d’évaluer ces pratiques au regard des implications de celleux qui composent le groupe, c’est-à-dire qu’en fin de compte, l’évaluation se fait en aval et non en amont. Encore une fois, cela soulève la question de l’indétermination du projet lui-même mais aussi des limites de son instrumentalisation.
Quelles sont les questions les plus importantes à se poser avant de développer une œuvre ou une pratique cocréative ? Quelles sont les questions à se poser avant d’y participer ?
Le pédagogue Fernand Oury disait que la première question à se poser quand on intègre un groupe, c’est: «qu’est-ce que je fais là?» La coopération met à l’épreuve sa propre vulnérabilité : la personne est-elle prête à remettre en cause ses habitudes, ses façons de faire, à être bousculés par le collectif ainsi que par les affects qui vont charrier ce collectif. Est-elle prête à se laisser porter par ce qui va se passer ? À accepter l’improvisation ? À lâcher la part de contrôle qu’on veut parfois garder quand un sujet nous tient à cœur ou quand il s’agit d’un projet artistique dans lequel on est investi émotionnellement.
Comment mettre en place une pratique cocréative et située au sein d’une communauté ou d’un territoire différent du sien ?
Je m’intéresse beaucoup à l’anthropologie réflexive, c’est-à-dire une forme d’anthropologie qui se pose des questions sur ses propres méthodes d’investigation et ses rapports aux personnes qu’elle rencontre et, surtout, qui intègre la subjectivité des chercheur·euse·x·s. L’essentiel, quand il s’agit de travailler dans un territoire nouveau, avec des gens dont on ne connaît pas les pratiques, c’est d’écouter, d’observer, d’être avec les gens et d’être respectueux·euse·x de leurs différences, dans une approche éthique et scrupuleuse.
Enfin, il faut s’impliquer et accepter la contradiction, ce qui renvoie à ce que nous disions précédemment sur les questions qu’il faut se poser. Il est également important à mes yeux de ne pas arriver les mains vides : il faut être généreux·euse·x dans son implication et à tous points de vue.
La vie minérale
Pendant des siècles, l’hypothèse implicite selon laquelle le monde minéral fonctionne indépendamment du monde végétal ou animal a perduré, créant, comme dans de nombreux domaines de la connaissance, une dichotomie artificielle: dans ce cas, entre les roches, les minéraux et les cristaux (qui relève de la géologie) et le vivant (qui relève de la biologie). Cependant, dès la découverte de l’origine des fossiles au XIXème siècle, les frontières entre les deux disciplines se sont brouillées, provoquant une révolution à la fois scientifique et philosophique.
Au-delà du remplacement progressif de la matière organique par des minéraux à l’origine des fossiles, nous savons aujourd’hui que les molécules qui composent les roches, notre corps et tous les êtres vivants sont en fin de compte les mêmes et nous pensons que la vie est née d’un processus géochimique rendu possible par un mélange d’eau, d’air, de minéraux et d’énergie. Au cours des deux dernières décennies, des chercheur·euse·x·s tel·le·x·s que le géologue Robert Hazen ont mis en évidence la coévolution de la vie et des minéraux sur notre planète. Bien que les roches soient perçues comme des entités fixes et immuables, surtout si on les compare à la nature variable des êtres vivants, l’émergence de la vie sur notre planète a en fait contribué à de profonds changements géologiques. En effet, la Terre se caractérise par une géo-diversité étonnante, estimée à environ dix fois celle des autres planètes du système solaire et la vie a joué un rôle essentiel dans les processus qui ont conduit à cette différenciation.
Une première avancée majeure a eu lieu il y a 2,5 milliards d’années avec l’apparition d’une forme de photosynthèse dans le métabolisme des algues visqueuses, libérant de l’oxygène et transformant l’atmosphère en un environnement oxydant. L’oxygène est un gaz corrosif qui a provoqué des changements majeurs dans les minéraux de notre planète: des milliers de spécimens, dont la turquoise et la malachite par exemple, se sont formés dans les couches superficielles de la croûte terrestre à la suite d’interactions entre des eaux riches en oxygène et des minéraux préexistants. Avant l’augmentation de la concentration en oxygène, de telles réactions n’auraient pas pu se produire et ces changements ont donné naissance à de nouvelles niches écologiques, contribuant à la naissance et à l’évolution de nouvelles formes de vie.
Le processus de biominéralisation a également été une étape cruciale: il y a environ 580 millions d’années, au cours d’une évolution encore mal expliquée, certains animaux ont acquis la capacité de développer des sections solides leur permettant de se protéger en exploitant des minéraux tels que le carbonate de calcium ou la silice: en quelques dizaines de millions d’années, les carapaces, les dents, les griffes, les épines, les coquillages et les coraux se sont répandus et ont été stratifiés dans les roches sédimentaires qui couvrent aujourd’hui une grande partie de la surface de la Terre.“

Image: Marina Cavadini, Oyster, 2022, digital print. Courtesy: the artist and The Address Gallery.
Enfin, parmi les nombreux autres exemples, mentionnons encore la formation des combustibles dits fossiles, qui résultent de la transformation naturelle, au cours de millions d’années, de la matière organique enfouie dans le sous-sol au fil des ères géologiques en des formes progressivement plus stables et plus riches en carbone. Le pétrole, le méthane et le charbon ont en effet indirectement mis en lumière l’imbrication de la biologie et de la géologie, en raison du rôle fondamental qu’ils jouent dans l’Anthropocène, l’ère géologique que nous vivons actuellement. Le terme «Anthropocène» met l’accent sur les changements qu’une espèce vivante, à savoir l’être humain, a provoqués et continue de provoquer dans les cycles de la planète, à tel point qu’elle a laissé son empreinte sur le registre géologique avec une rapidité et une gravité inédite jusqu’à présent.
Au cours des dernières décennies, l’interaction entre biologie et géologie a pris une nouvelle dimension, en particulier dans le contexte de la production technologique et de l’extraction des terres rares. La demande de ces éléments critiques, essentiels à la fabrication des appareils de haute technologie qui ont pénétré notre vie quotidienne, a conduit à de vastes opérations minières qui ont un impact important sur l’équilibre écologique: l’acte d’écrire ou de lire cette lettre d’information, par exemple, est lié à la notion d’extractivisme, une pratique et une approche associées à la dégradation de l’environnement et aux préoccupations en matière de droits de l’homme. De plus, des véhicules électriques aux panneaux solaires, les technologies qui sont proclamées comme des solutions incontestablement vertes à la crise écologique reposent sur l’exploitation à nouveau abusives de composants: qu’il soit vert ou non, le paradigme capitaliste perpétue un cycle d’exploitation enraciné dans l’hyperconsommation et la notion de croissance perpétuelle qui lui est inhérente. C’est pourquoi certain·e·x·s chercheur·euse·x·s préfèrent le terme de Capitalocène à celui d’Anthropocène: une perspective critique qui interroge la manière dont le système économique dominant structure notre rapport à la planète.
Réfléchir à l’équilibre entre la vie et les minéraux qui a façonné l’histoire de la Terre révèle des dynamiques qui dépassent les limites géologiques et biologiques traditionnelles, englobant l’économie et la société dans le récit plus large du Capitalocène: une manière d’affronter les répercussions de l’extraction des ressources minérales et les implications de notre rôle dans le façonnage de notre planète. La reconnaissance de l’enchevêtrement de notre trajectoire collective avec les processus géologiques incite à réévaluer notre relation avec la Terre, exigeant un recalibrage de notre existence avec les forces dynamiques de la géologie, reconnaissant que l’héritage que nous forgeons dépend d’une compréhension profonde de l’interconnexion des écosystèmes, où les frontières entre le vivant et l’inerte fluctuent.
Repenser la transition
Denise Medico (elle, el) est psychologue clinicienne, sexologue et professeure au Département de sexologie de l’UQAM. Elle mène des travaux de recherche sur la subjectivité, la corporéité et le genre ainsi que sur le développement d’approches inclusives et affirmatives en psychothérapie. Elle est co-fondatrice de la Fondation Agnodice qui œuvre pour le développement de ressources pour les jeunes personnes trans et leur famille. Ainsi que de Centre 3, un centre de formation et de psychothérapie féministe ouvert à touxtes. Denise Medico fait partie du groupe de recherche de projet Peau Pierre de least, dans le cadre duquel nous l’avons interviewée.
- Récemment, le terme «transition», que l’on utilise pour décrire le parcours d’une personne transgenre, a été remis en question. Pensez-vous également que ce terme est inadapté? Et, si oui, pourquoi?
Il y a une vingtaine d’années, on parlait de «métamorphose» plutôt que de «transition» et, avant cela, on parlait même de pathologie: les personnes transgenres étaient considérées comme souffrant de problèmes mentaux dont il fallait les guérir. La métaphore de la transition introduit l’idée d’un parcours entre deux genres, considérés comme deux lieux. Il s’agit d’une métaphore «géographique» qui parle à de nombreuses personnes, y compris à certaines personnes transgenres. À l’époque, les personnes concernées étaient essentiellement des femmes transgenres qui avaient entamé leur processus de transition assez tard dans la vie et qui avaient grandi avec des référents binaires, voire «naturalisants». En résumé, avec le concept de transition, il s’agissait donc de passer d’un genre à un autre. En y réfléchissant aujourd’hui, d’un point de vue plus queer ou post-butlérien*, c’est une idée que l’on commence aussi à déconstruire. Les genres sont des lieux sociaux, des grammaires, des systèmes de pensée. L’idée de «l’incongruence de genre» postule que le «rôle » qui vous a été assigné ne correspond pas au ressenti d’une identité. Toutefois, si le genre n’est pas binaire, l’idée de transition s’en trouve changée, car la transition implique inévitablement un point de départ et un point d’arrivée. Certaines personnes vivent leur transition de cette manière, mais les parcours sont généralement plus fluctuants. Une personne qui a entamé ce processus, qui est dans le changement, peut à tout moment changer de direction: c’est le processus qui compte et non le point d’arrivée. En outre, sur un plan politique, à l’heure où les mouvements anti-trans sont très forts, un angle d’attaque qui revient souvent repose sur l’idée de «changer de genre». Il vaut donc mieux parler «d’affirmation» ou de «parcours de genre», notamment parce que nous affirmons touxtes un genre, qu’il soit binaire ou non binaire, neutre, stable ou fluide.
En quoi la création d’un vocabulaire qui englobe les personnes transgenres est-elle importante? Pouvez-vous me donner un exemple d’un mot qu’il serait bon que tout un chacun intègre dans son vocabulaire?
Si la pensée ne repose pas uniquement sur le vocabulaire, il joue un rôle fondamental. Pour se penser soi-même, il faut avoir les mots pour le faire. Le mot «non-binaire», par exemple, a eu un impact significatif. Il y a toujours eu des gens qui ne se sentaient ni homme ni femme, ça, ce n’est pas nouveau, mais, jusqu’à présent, ces personnes n’avaient pas la possibilité de se penser ainsi. Ne pas pouvoir se penser soi-même est une expérience douloureuse qui conduit à des sentiments dépressifs et négatifs. C’est une souffrance silencieuse. Quand ces personnes vous racontent comment leur vie a changé au moment où elles ont pu se penser avec un mot, elles en parlent comme d’une épiphanie: il y a un avant et un après. Le mot «non-binaire» est un bon exemple, mais c’est un mot politiquement chargé, car il remet en question le système de genre dans son ensemble et le caractère «naturel» de la hiérarchie homme-femme.
En quoi le féminisme contribue-t-il à l’élaboration d’un tel vocabulaire et à la santé sexuelle et mentale des personnes transgenres?
Il ne s’agit pas seulement des personnes transgenres: l’élimination de ces stéréotypes concerne tout le monde et, si vous êtes «différent·e·x», cela vous affectera davantage encore. Les choses ne seraient pas ainsi aujourd’hui sans le féminisme, sans Simone de Beauvoir ou Judith Butler. Certaines réalités existaient déjà, mais ce n’est qu’après avoir été conceptualisées qu’elles ont commencé à changer la société. En fait, je ne comprends pas pourquoi les TERF (féministes radicales trans-exclusives) ont un problème avec les personnes trans, car en partant d’une déconstruction progressive, de l’idée que le sexe n’est pas le genre, on produit une critique beaucoup plus radicale et efficace du système qui oppresse les femmes en structurant la société sur un mode hiérarchique.
Les technologies médicales sont souvent perçues comme neutres, tout comme la science, alors qu’il s’agit en fait de processus qui font entrer l’expérience privée des personnes dans la sphère publique de la connaissance scientifique et du pouvoir politique et qui renforcent parfois des formes d’oppression. Comment les technologies médicales influencent-elles la construction du corps trans, y compris au niveau de l’imaginaire? Comment développer des technologies et des processus médicaux plus efficaces pour les personnes trans?
C’est une question complexe. Sans la médicalisation, il n’y aurait pas de personnes trans, car c’est la médecine et la recherche biomédicale qui ont permis de conceptualiser et d’étudier les hormones. L’idée qu’il y a peut-être quelque chose dans le corps qui détermine le sexe masculin ou féminin, le concept d’hormone donc, remonte au XIXe siècle. L’histoire du mouvement transgenre est liée à l’endocrinologie, mais aussi à la psychiatrie, toutes deux reposant sur une vision binaire et jouant un rôle de «sentinelle». De nos jours, la perspective médicale est moins binaire, mais la question demeure complexe: l’hormonothérapie, par exemple, offre aujourd’hui trois possibilités, soit obtenir les caractéristiques d’un genre, supprimer les caractéristiques de l’autre ou bloquer les hormones qui développent ces caractéristiques. La médicalisation des processus d’affirmation du genre fait l’objet de débats depuis vingt ans et les personnes trans ne sont pas toutes du même avis. Pour l’instant, la position du maintien de la médicalisation pour des raisons économiques l’emporte: si l’on veut être remboursé par les compagnies d’assurance, il faut se plier à la logique de la santé et du diagnostic. De plus, les partis d’extrême droite et certains mouvements anti-trans veulent empêcher la médicalisation plutôt que la contrôler. Sans parler du monde médical où la formation n’est pas critique, théorique ou épistémologique, mais essentiellement technique.
La prise en charge du genre implique une approche transdisciplinaire. Quelles sont les disciplines qu’il est important de mettre en dialogue et comment cette interdisciplinarité est-elle gérée?
Différentes disciplines de soin sont impliquées, même si cela dépend des pays: en Suisse, par exemple, les parcours d’affirmation du genre sont généralement suivis par un psychothérapeute, surtout depuis qu’ils sont remboursés par les assurances, qui a pour rôle d’accompagner les personnes et parfois de faire un rapport à l’endocrinologue·x ou au chirurgien·ne·x. Les endocrinologues sont responsables de l’hormonothérapie. Une spécialisation qui a pris beaucoup d’importance ces dernières années, c’est la chirurgie dite de torsoplastie qui, avec ou sans hormonothérapie, reste le traitement le plus populaire. Contrairement aux croyances usuelles, les chirurgies génitales ne sont plus la pierre angulaire des parcours d’affirmation de genre. Au-delà de la médecine, la sociologie critique est une discipline importante, car pour travailler avec les personnes transgenres, il est important de remettre en question ce que l’on pense être «naturel».

Aurore Favre, How to crochet a mask, 2023. ©Aurore Favre.
D’après votre expérience, s’agit-il d’une bonne pratique ou devrait-on impliquer ou donner davantage de place à d’autres spécialistes?
Cela dépend: il y a différentes voies qui nécessitent différentes approches. Si le sexe féminin vous a été assigné à la naissance et que vous vous sentez non binaire, vous pouvez vivre sans hormonothérapie, mais vous pouvez aussi prendre des hormones, souvent en microdoses et pour cela vous consulterez un·e·x endocrinologue·x. Vous aurez peut-être besoin de chirurgie. En effet, si vous ne supportez pas vos seins, vous devrez porter un binder (veste de compression), mais ils sont aussi assez inconfortables, ils compressent la cage thoracique, entravent la respiration et augmentent le sentiment d’anxiété. Si, au contraire, vous voulez devenir un homme transgenre, vous prendrez de la testostérone. Cela changera le ton de votre voix et votre «passing» (les situations où une personne transgenre est reconnue comme une personne cisgenre dans les environnements où elle évolue) sera totalement masculin. Après une année d’hormonothérapie la plupart ont déjà des changements notables. En revanche, si le sexe masculin vous a été assigné à la naissance et que vous avez déjà passé la puberté, les changements induits par la testostérone ne seront pas réversibles: par exemple, votre voix, si vous avez déjà mué, ne remontera pas et vous pourriez ressentir un plus grand besoin d’interventions chirurgicales. En outre, à l’heure actuelle, en raison des événements politiques, on agit avec plus de prudence: l’une des stratégies des mouvements anti-trans est de faire peur aux clinicien·ne·x·s, parfois par des menaces directes, parfois en engagent des poursuites et des dénonciations aux autorités afin de saturer notre temps.
Comment cela est-il possible? Avec quelles motivations?
On peut vous dénoncer pour pratique abusive, par exemple. Même si cela s’avèrera faux, vous aurez mis une énergie considérable à gérer cette situation.
Le discours transgenre est peu visible, voire invisible dans le discours public. La pratique du «passing» elle-même contrecarre et invisibilise l’identité trans.
C’est vrai, mais en même temps il ne faut pas penser que le mouvement trans n’est constitué que de personnes qui ont une fibre politique et pour qui être visible, affirmer une identité et critiquer les structures sociales est possible et souhaitable. Les personnes trans ne sont pas toutes comme ça et celles qui ne le sont pas ne sont pas visibles, parce qu’elles n’écrivent pas et ne manifestent pas. De plus, elles ont souvent un grand sentiment de transphobie intériorisé: elles cherchent donc à rester aussi discrètes que possible, puisqu’elles vivent dans la peur. Il existe un mouvement trans non binaire très actif, notamment dans le monde de l’art, qui est très sensible à ces questions, mais qui ne représente pas toutes les réalités trans.
J’imagine que les questions de classe sociale ou d’origine, entre autres, jouent un rôle à cet égard.
L’éducation et la classe sociale jouent un rôle. Le monde politique trans est beaucoup plus présent dans les universités et les arts que dans d’autres contextes. Ensuite, cela dépend aussi du genre: de nombreuses personnes transgenres qui font leur coming out plus tard sont des personnes à qui le sexe masculin a été assigné à la naissance, qui ont subi des traumatismes dans leur enfance et qui ont connu un parcours très difficile avant d’oser s’affirmer. Elles ont donc une peur viscérale des actes de violence, parce qu’elles les connaissent bien. Elles rêvent donc d’un «passing» parfait, ce qui est alors encore plus difficile, car si elles ont cherché à s’affirmer tardivement, elles ont déjà été masculinisées par la puberté et le «passing» n’en est que plus difficile. Il y a aussi des personnes qui ont des structures de personnalité différentes, qui fonctionnent différemment, cognitivement parlant, ou qui sont neurodivergentes. Certaines personnes, qui sont sur le spectre de l’autisme comme il est souvent dit, ont tendance à penser de façon plus rigide et il est donc très important pour elles d’être perçues comme «normales». Même si le genre n’est pas quelque chose qui leur «parle» en soi, elles voient «comment les choses se passent» dans la société et cherchent à faire la même chose.
Quelle est l’importance du savoir situé dans le discours de la technologie médicale et de la construction des parcours? En quoi l’osmose des connaissances entre les personnes trans et le monde des personnes qui s’occupent de leur santé sexuelle et mentale joue-t-elle un rôle significatif?
Il y a de plus en plus de personnes trans parmi nous. Nous ne sommes pas un groupe cis, mais un groupe très mixte et nous avons beaucoup travaillé pour permettre aux personnes transgenres d’accéder à l’université. Lorsqu’on travaille dans une perspective trans, on applique une politique de sélection positive. L’intentionnalité est importante. En tant que société, moins on ressent d’obligation de correspondre aux normes, moins on aura de parcours qui seront déterminés, de façon obsessionnelle, par un «passing» réussi. Au lieu de cela, on aura une société dans laquelle même un corps trans ou non binaire peut exister sans d’innombrables opérations chirurgicales. Il y a des personnes trans, par exemple dans le monde de l’art, qui mettent en scène leur vrai corps, tout comme il y a des personnes trans dont le passing est tout à fait réussi, mais qui continuent à se faire opérer. Peut-être parce qu’elles ne sont pas satisfaites de leur corps et elles sont prêtes à endurer des opérations extrêmes et risquées, à des fins esthétiques par exemple. C’est aussi pour cela qu’il est important pour certaines personnes de suivre une psychothérapie, parce qu’elles n’atteindront jamais cet idéal: un idéal qui n’existe pas.
Avez-vous constaté des expériences différentes en fonction des contextes, des paysages, des environnements dans lesquels les gens vivent? J’ai lu un livre de Jules Gill-Peterson intitulé Histories of the Transgender Child et j’ai été frappée par le fait que, dans certaines régions rurales des États-Unis, même très petites, à des époques où la médicalisation n’était pas envisageable, des personnes transgenres parvenaient à mener une vie qui, d’une certaine manière, représentait leur genre.
On ne peut pas séparer l’idée de «passing» de l’idée de violence sociale; un «passing» réussi, c’est être invisible pour ne pas être en danger. L’opposition ville-campagne est vraie, mais il y a de nombreuses exceptions: dans certaines petites communautés, il existe des personnes, des «personnages» comme on les appelle, qui peuvent se permettre d’affirmer leur genre. Nous avons d’ailleurs mené une étude dans une région rurale du Québec sur les couples dans lesquels une personne est passée par un processus d’affirmation du genre. Presque toutes les études portent sur des couples de personnes assignées femmes à la naissance. Ce sont les seules études ou presque dont nous disposons dans ce sens. Elles sont généralement réalisées dans des contextes très politisés, dans des villes, avec des personnes qui vont à l’université, qui étudient les études de genre. L’immigration est aussi un facteur important. Par exemple, au Canada, il y a un phénomène d’immigration LGBTQIAP+, mais c’est compliqué: prenons, par exemple, une femme trans qui arrive de la campagne turque, où la vision est extrêmement binaire et où l’importance du «passing» est dictée par la peur, qui débarque à Montréal, une ville queer et non-binaire. Une telle personne aura l’impression d’être totalement inadaptée à la société montréalaise. On ne peut pas parler d’intersectionnalité sans penser aux questions ethniques, mais aussi d’immigration, d’origines sociale et géographique et aux perspectives d’avenir.
*Dans le contexte du genre, le «passing» se réfère à la capacité d’une personne à être considérée, en un seul coup d’œil, comme une personne cisgenre (Wikipédia).
*Judith Butler est unx philosophe et unx spécialiste des études de genre dont les travaux ont influencé la philosophie politique, l’éthique et les domaines du féminisme de la troisième vague, de la théorie queer et de la théorie littéraire. Iel est surtout connux pour ses livres Gender Trouble: Feminism and the Subversion of Identity (1990) et Bodies That Matter: On the Discursive Limits of Sex (1993), dans lesquels iel remet en question les notions conventionnelles et hétéronormatives de genre et développe la théorie de la performativité du genre.
CROSS FRUIT (ex Verger de Rue)
CROSS FRUIT (ex Verger de Rue) est un projet artistique d’écologie urbaine, créé par Thierry Boutonnier et Eva Habasque, qui implique des citoyen·ne·x·s dans la conception, la création et l’entretien d’un verger à Onex (Genève). Dans cette vidéo, le réalisateur Simon David rassemble des images des premières étapes de ce projet.
Vivre le Rhône: partie 3
Gardien·ne·x·s du fleuve
En juillet 2023, dans le cadre du projet Vivre le Rhône, NLC et least ont organisé à Geneve une série d’evénements sur trois jours pour élargir une communauté légitime qui pourrait agir au nom du fleuve. Une vidéo de Carlos Tapia retrace le processus.
Cliquez ici pour la partie 1.
Cliquez ici pour la partie 2.
Voix de:
Maria Lucia Cruz Correia - artiste
Marine Calmet - avocate des droits environnementaux
Floriane Facchini - artiste, metteure en scène
Vinny Jones - scénographie sensorielle
Felix Küchler - médecin, activiste pour le climat
Emma-Louise Lavigne - activiste Association id-eau
Gilles Mulhauser Canton de Genève - Office cantonal de l’eau
Laurence Piaget-Dubuis - éco-artiste, graphiste, photographe
Zone de sacrifice
«Un jour, alors que nous nous baladions près de l’Ironbound Community Corporation, nous avons senti une odeur âcre. C’était une odeur que je connaissais bien, car où que vous alliez dans le quartier d’Ironbound, il n’y a que des colonnes de fumée. Mes collègues ont néanmoins tout de suite dit qu’il fallait appeler le département de la protection de l’environnement. C’est à ce moment-là que j’ai réalisé que j’avais senti cette odeur toute ma vie, mais que je ne l’avais jamais perçue comme étant problématique. C’est pourtant cette odeur qui m’a fait prendre conscience de la différence entre des quartiers comme Newark et les banlieues, où les arbres sont nombreux et l’air est propre. La question de la justice raciale a toujours fait partie de ma vie, mais c’est à ce moment-là que j’ai réalisé à quel point le racisme environnemental était insidieux». Ces mots sont ceux de Maria Lopez-Nuñez, une activiste hondurienne-américaine qui se bat depuis des années pour la justice environnementale dans le quartier d’Ironbound, à Newark, dans le New Jersey. Ce quartier est tristement célèbre pour son «couloir chimique», un tronçon d’un kilomètre qui «passe devant une usine de gaz naturel, une station d’épuration, une usine d’équarrissage de graisses animales et une série de conteneurs de stockage de produits chimiques à l’aspect menaçant, situés derrière des hectares de clôtures. Des avions survolent le quartier toutes les deux minutes, leurs moteurs faisant trembler les fenêtres, tandis qu’une odeur putride s’échappe des bassins à ciel ouvert de la station d’épuration». La zone est habitée par des populations portugaises, brésiliennes, centraméricaines, afro-américaines et blanches à faibles revenus: leur lutte pour «briser le cycle des communautés de couleur pauvres qui servent de dépotoirs à notre société de consommation» est le sujet du documentaire The Sacrifice Zone: Life in an Industrial Wasteland (La zone de sacrifice: vivre dans une friche industrielle).
La notion de zone de sacrifice remonte à la guerre froide, lorsque la course aux armements nucléaires entre les États-Unis et l’URSS a laissé derrière elle une série de territoires – dont beaucoup étaient habités – contaminés par les essais nucléaires et l’extraction d’uranium. Ces dernières années, la notion de «zone de sacrifice» a circulé parmi les activistes de l’environnement au point d’être inclus dans un rapport majeur de l’ONU en 2022 «sur la question des droits humains liés à la jouissance d’un environnement sûr, propre, sain et durable». Dans ce document, les zones de sacrifice sont définies comme des «zones extrêmement contaminées où des populations vulnérables et marginalisées supportent de manière disproportionnée les conséquences sanitaires, légales et environnementales de l’exposition à la pollution et aux substances dangereuses». Mais pourquoi utiliser le terme de «sacrifice»? Et ces conséquences que les communautés doivent supporter sont «disproportionnées» par rapport à qui?
L’enjeu des zones de sacrifice n’est pas seulement la contamination des territoires habités, mais le fait que les communautés qui vivent dans ces zones paient le prix d’un consumérisme et de modes de vie auxquels elles n’ont pas accès et dont bénéficient des groupes privilégiés vivant dans d’autres zones sans avoir à en payer eux-mêmes les conséquences: un prix en termes de santé et de droits humains qui reflète les disparités de classe dans le monde globalisé. Des niveaux sans précédent de pollution dus au torchage du pétrole et du gaz dans le delta du Niger aux décharges non réglementées dans le monde entier, en passant par les émissions de l’aciérie Ilva à Tarente, le rapport de l’ONU décrit un phénomène généralisé et désolant qui sous-tend notre système économique.

Cette situation ne concerne pas seulement le Sud global, mais aussi les communautés les plus faibles du Nord global, que la marginalisation, la racialisation et le mépris des médias tiennent à l’écart de toute forme de protection. Les installations les plus polluantes et les plus dangereuses, notamment les mines à ciel ouvert, les fonderies, les raffineries de pétrole, les usines chimiques, les centrales électriques au charbon, les gisements de pétrole et de gaz, les aciéries, les décharges et les incinérateurs de déchets dangereux, ainsi que les regroupements de ces installations, ont tendance à se situer à proximité immédiate des communautés les plus pauvres et marginalisées: lorsqu’une industrie ayant un impact environnemental important recherche une zone pour la construction d’une usine, elle se heurte d’un côté au refus des communautés plus riches et plus influentes, mais, de l’autre, elle est susceptible d’être acceptée dans les zones économiquement défavorisées en raison de la promesse de création d’emplois et de développement.
Le fait que la contamination du sol, de l’eau et de l’air et son impact ne sont souvent pas immédiatement visibles n’aide pas celleux qui souhaitent s’opposer à ces pratiques d’exploitation. Comme dans le témoignage de Maria Lopez-Nuñez, certaines conditions ne sont pas perçues comme dangereuses, mais plutôt comme normales, et on ne s’en préoccupe pas. Parfois, ce n’est qu’après des années d’exposition aux risques environnementaux – lorsque les maladies liées à la pollution industrielle commencent à se propager – que les gens s’inquiètent réellement et il est souvent trop tard pour obtenir réparation. Dans son livre Sacrifice Zones: The Front Lines of Toxic Chemical Exposure in the United States, Steve Lerner décrit le sentiment d’impuissance de l’une de ces communautés: «une fois que les riverain·e·x·s commencent à poser des questions sur l’étendue de la contamination, iels signalent souvent qu’iels se heurtent à la résistance des autorités et qu’iels obtiennent rarement des réponses directes ou des informations complètes. Iels apprennent souvent par la suite que les membres du gouvernement et le personnel des entreprises a dissimulé des informations néfastes concernant l’étendue de la contamination par crainte de créer un mouvement de panique. Ce comportement trompeur et paternaliste empêche les habitant·e·x·s de la région de choisir en temps utile et en connaissance de cause de déménager immédiatement (s’ils en ont les moyens), d’arrêter de boire l’eau des puits, de garder les fenêtres fermées, d’envoyer leurs enfants vivre avec de la famille dans d’autres quartiers, d’interdire à leurs enfants de jouer à l’extérieur, d’éviter de jardiner, de manger des légumes cultivés dans leurs potagers ou de prendre d’autres mesures de protection».
La contradiction la plus dramatique réside en effet dans les options qui s’offrent aux travailleur·euse·x·s: conserver leur emploi et risquer leur vie et celle de leur famille ou choisir de manifester pour leurs droits, en risquant la délocalisation des industries toxiques vers d’autres zones, peut-être moins réglementées. Cependant, la santé et l’argent sont tous deux nécessaires pour survivre et ce chantage inacceptable se joue sur les épaules des plus faibles pour le bien-être des plus privilégié·e·x·s. Néanmoins, la désindustrialisation, c’est-à-dire la réduction progressive des effectifs employés, est un risque tangible, qui a laissé des territoires comme la Ruhr en Allemagne en proie à une faiblesse économique structurelle sans que des opérations efficaces de dépollution ou de redéveloppement ait été menées – un sort partagé par de nombreuses zones d’industrie lourde depuis les années 1980.
Finalement, le plaidoyer inlassable de Maria Lopez-Nuñez et les efforts collectifs de l’Ironbound Community Corporation ont permis de franchir une étape importante dans la lutte contre l’injustice environnementale. La loi S232, accueillie comme une mesure salutaire de justice environnementale, représente un progrès notable dans la protection des communautés confrontées à des charges environnementales intolérables. Toutefois, la lutte est loin d’être terminée, car la nature insidieuse et structurelle des disparités environnementales persiste à l’échelle mondiale. Comme le souligne le rapport des Nations unies, «les actionnaires des entreprises polluantes bénéficient de profits plus élevés, tandis que les consommateur·trice·x·s profitent d’une énergie et de biens moins coûteux. La prolongation des emplois des travailleur·euse·x·s des industries polluantes est utilisée comme une forme de chantage économique pour retarder la transition vers un avenir durable, tandis que le potentiel des emplois verts est injustement dévalorisé. Le maintien des zones de sacrifice est une tache sur la conscience collective de l’humanité».
La Recette du Gesamthof: Un Jardin Lesbien
Hedera est une observation collective du chevauchement entre les études postnaturelles et transféministes.
Chaque volume rassemble des idées liées à ces sujets sous la forme de conversations, d’essais, de fictions, de poésies et de contenus d’artistes. Hedera est une publication annuelle dont le premier volume présente «The Gesamthof Recipe: A Lesbian Garden» écrit par l’artiste Eline De Clercq.
Le Gesamthof est un jardin qui n’est pas centré sur l’humain. C’est un jardin qui suit le principe d’une écologie saine et qui évince l’idée d’un résultat final. Cette recette vise à partager notre façon de jardiner au Gesamthof.
Se reposer, observer.
Commencez par ne rien faire. Profitez d’un instant de quiétude avant de commencer. Se reposer, ici, signifie «ne pas encore agir». C’est une bonne façon de commencer qui m’a souvent semblé constructive. Lorsque je m’en vais travailler dans le jardin, je mets mes vieilles chaussures, je prends un panier avec des outils de jardinage et des graines à semer, j’ouvre le portail, je pénètre dans le jardin et, là, je m’arrête. Je n’agis pas tout de suite, mais j’attends un moment avant de commencer, ce qui me donne le temps de m’aligner avec la terre, les plantes, la température, les odeurs, les images et les bruits. Je regarde les oiseaux, un escargot, un scarabée sur une feuille. Je marche dans l’allée, tout en saluant les plantes et les pierres. Comme moi, qui m’octroie ce moment, il leur faut un instant pour savoir qui a pénétré dans le jardin. Je sais que les plantes me voient parce qu’elles perçoivent différents types de lumière et qu’elles poussent vers la lumière. Elles voient cette lumière froide lorsque je me tiens devant elles et que je projette mon ombre sur elles. Elles voient aussi la lumière du soleil revenir une fois que je me suis déplacée. C’est le premier rapport avec le jardin: penser comme un·e·x jardinier·ère·x qui rend visite. Donna Haraway écrit à propos de Vinciane Despret qui se réfère à «Juger: Sur la politique philosophique de Kant» de Hannah Arendt: «Elle entraîne tout son être, et pas seulement son imagination, selon les mots d’Arendt, à ‘rendre visite’» (tiré du livre «Vivre avec le trouble»). Parfois, c’est tout ce que je fais; le temps passe, une heure ou plus, je me sens vraiment en vie à écouter, ressentir, sentir et regarder. Je goûte la saison.
Vos sens et votre esprit.
Sentir et penser avec la nature. C’est peut-être le plus difficile à expliquer, mais c’est ainsi que j’ai appris à jardiner lorsque j’étais bénévole au jardin botanique de Gand. Il y a beaucoup de choses à apprendre et à retenir, mais la plupart du temps des ouvrages de référence sont disponibles à la consultation. En effet, il existe de nombreux livres sur les types de plantes et sur les conditions qui leur conviennent. Vous trouverez ce type d’informations facilement. Pour moi, l’explication rationnelle vient à la fin, comme un test décisif pour voir si une théorie fonctionne. J’aime commencer par l’expérience: sentir la texture d’une feuille, constater le changement de température lorsqu’il va pleuvoir, tester la terre en la frottant entre ses doigts, sentir le sol, les plantes, les champignons, etc. Les sens nous relient à toutes sortes de matières dans un jardin. Ils nous aident à faire partie de lui. Donna Haraway introduit le terme de «natureculture», un concept intéressant qui repense la façon dont nous faisons partie de la nature et qui postule que la dichotomie entre nature et culture n’est pas une contradiction réelle. Cet argument doit nous permettre de ne plus penser en tant que «simples humains» et de nous transformer en un ensemble vivant et stratifié. Il est dans notre intérêt de ressentir à nouveau la nature avec nos sens. En même temps, sachez que de nombreuses plantes sont toxiques et / ou douloureuses; elles peuvent vous blesser, alors ne vous fiez pas trop à votre instinct sans vous renseigner…
Gesamthof, un jardin qui n’est pas centré sur l’homme.
Cette parcelle de terre, ce jardin partagé, fait partie d’un univers de bactéries, de protistes, de champignons, de plantes et d’animaux, qui tous apprécient également le Gesamthof. J’essaie de donner aux champignons du bois mort à manger et je n’utilise pas d’herbicides ni de pesticides lorsque je m’occupe des plantes. C’est plutôt évident: ce sont les bases de l’éco-jardinage, mais cela concerne aussi le bénéfice de l’ensemble du jardin. La question importante est la suivante: qui en profite? Si je prends compte des oiseaux, des insectes, des plantes et des champignons et de leurs besoins pour survivre en ville, alors ce petit jardin profite à tous et l’artichaut pourri n’est pas vraiment une catastrophe: de nombreux «jardiniers», petits et grands, apprécient la présence de l’artichaut, de boire son nectar, de manger ses feuilles ou de tisser une toile entre ses tiges séchées. Le fait de penser à tout ce petit monde en train de jardiner ensemble change l’objectif du jardin, qui n’est plus seulement axé sur l’humain. Je vois souvent des mélanges de graines pour abeilles dans les jardineries, mais chaque jardin a une relation différente avec ses abeilles. Ce sont parfois des abeilles sauvages, solitaires, qui vivent d’une seule espèce de plante et qui n’ont aucun intérêt pour un mélange de graines, plein de fleurs colorées, sélectionné par l’homme. La question «qui en profite?» me permet de ne pas acheter des choses pour mon plaisir et m’apprend à me réjouir de l’établissement d’une écologie saine. Cette façon de penser m’a amené à m’interroger sur les plantes d’intérieur. Si elles avaient le choix entre vivre à l’intérieur d’une maison dans un pays froid ou être à l’extérieur dans un endroit chaud, ne préféreraient-elles pas sentir le coucher du soleil et le vent dans leurs feuilles? Est-ce que je garde des plantes dans ma maison pour mon propre bénéfice? Les plantes y pousseraient-elles si je ne les arrosais pas et si je ne m’occupais pas d’elles? Dois-je mettre des plantes dans des endroits où elles ne pousseraient pas de façon naturelle? J’ai décidé de ne plus acheter de nouvelles plantes pour ma maison; je prendrai soin de celles avec lesquelles je vis le mieux possible. Le jardin s’arrête-t-il à notre porte ou est-ce que je vis moi aussi dans le jardin?

La diversité de la vie urbaine dans un jardin.
Le contraire d’une nature sauvage et locale n’est pas une plante étrangère, mais une plante cultivée. Le jardin regroupe des plantes indigènes de plusieurs continents. Je cultive des lys africains à côté de fleurs Stinzen et de plantes sauvages et locales. Ils et elles s’entendent bien. Je ne suis pas une puritaine qui ne cherche à cultiver qu’une seule couleur de fleurs ou que des plantes authentiques. Je vois le jardin comme une ville où l’on arrive de tous les coins du monde. Les plantes ne connaissent pas de frontières. Elles ne se soucient pas des nations. Si l’endroit leur plaît, elles pousseront avec bonheur. Cependant, les humains ne savent pas toujours ce qu’iels plantent; nous construisons énormément, nous éliminons des plantes et remplaçons le vert de nos jardins par d’autres variétés – souvent des cultivars qui n’interagissent pas avec les espèces locales. Un cultivar est l’opposé d’une plante sauvage: il est sélectionné pour une qualité appréciée par les humains et pas toujours pour des raisons écologiques ou de potentiel d’interaction avec les autres espèces. Certains cultivars sont d’excellentes plantes, fortes et belles, en symbiose avec le reste de la nature. Cependant, certains cultivars fleurissent au mauvais moment pour attirer les insectes ou ne contribuent pas à leur environnement naturel. En d’autres termes, ils sont plantés pour des raisons esthétiques et non pour contribuer à une nature saine. C’est à cause de ces cultivars que nous perdons autant de génomes authentiques de plantes importantes pour la préservation de la nature. Lorsque vous avez un jardin qui ne comporte que ce type de cultivars, vous n’invitez pas la nature à y pénétrer. Vous pourriez tout aussi bien y mettre des fleurs en plastique.
Le contraire propose de s’intéresser de près à la diversité d’une nature «de poche», à ce qui pousse dans une certaine poche du monde, et de rechercher les espèces anciennes spécifiques à cette région, celles qui existent depuis des milliers d’années et qui jouent un rôle durable et important pour l’écologie locale des insectes, des plantes, des champignons et des autres êtres vivants. Au Gesamthof, je laisse pousser les mauvaises herbes afin de nourrir les insectes qui dépendent de ces plantes, les oiseaux qui dépendent de ces insectes, les plantes locales qui dépendent de ces insectes et de ces oiseaux, et ainsi de suite. Les jardins urbains sont comme des corridors: ils relient les insectes, les plantes et les champignons en un réseau plus vaste qui est essentiel à la survie de ces espèces. Bien qu’il ait des murs et des haies autour de lui, bien qu’on puisse le considérer comme une île, le jardin fait partie d’un archipel vert bien plus vaste. Les murs n’arrêtent pas les plantes, les oiseaux, les insectes et autres. En vérité, chaque ville ne possède qu’un grand jardin, composé de myriades d’îlots verts situés à quelques rues les uns des autres. Il ne faut pas briser cette chaîne, cette nature connectée, et perdre tout intérêt pour les plantes sauvages et locales, souvent considérées comme de banales mauvaises herbes indésirables: en réalité, elles sont très importantes dans une biodiversité qui s’élargit avec chaque espèce vivante. Étant donné que nous traversons une époque d’extinction massive où de nombreuses espèces disparaissent chaque jour, chaque geste compte, comme celui de laisser entrer la nature dans son jardin. Parfois, j’achète des plantes locales bio à de petites pépinières pour soutenir leur effort en matière de conservation. Toutefois, peu d’argent est investi dans le Gesamthof. Quand j’ai commencé à travailler, j’ai reçu de nombreuses plantes, graines et boutures gratuitement. À mon tour, j’ai ensuite donné des plantes pour que le Gesamthof continue à vivre dans d’autres jardins. C’est ainsi que des plantes du monde entier sont devenues partie intégrante du Gesamthof, jouant un rôle très important pour la biodiversité du jardin. Nous avons des jacinthes espagnoles et une glycine chinoise qui ont été plantées par les moines du monastère il y a longtemps et qui ont survécu après des décennies de négligence, des primevères que le vent a probablement apportées des parcelles voisines et des tulipes colorées, sauvages ou cultivées, qui attirent toutes sortes de visiteur·euse·x·s humain·e·x·s et non-humain·e·x·s.
Le jardin vous aidera.
C’est particulièrement étrange, mais depuis que je travaille au Gesamthof, des plantes sont arrivées de toutes sortes d’endroits, qui m’ont souvent été données gratuitement. De même, du matériel de jardinage, des pots et des livres arrivent comme par magie, grâce à la générosité de divers·e·x·s donneur·euse·x·s. Je travaille au jardin non pas pour créer «mon» jardin – je le considère comme une entité à part entière et je ne suis que «la personne munie de bras et de jambes» qui peut aider là où c’est nécessaire. Beaucoup d’autres êtres vivants nous aident également. Les guêpes mangent les pucerons, le lierre terrestre (Glechoma hederacea) prévient les mauvaises herbes sur le chemin et les mésanges mangent les araignées qui font leur toile sur le chemin du jardin (merci, je n’aime pas marcher dans les toiles d’araignées). Je suis moi-même une «bestiole» dans ce jardin (un terme que j’emprunte à Donna Haraway – la bestiole fait moins référence à la «création» que le terme «créature») et j’aime voir les autres bestioles s’épanouir dans leur travail. Je ne suis pas seule. Même si je travaille beaucoup, je considère que cela fait partie de ma pratique artistique. Les jardins sont rarement considérés comme des œuvres d’art, mais le fait de mener des recherches, d’apporter une perspective différente, d’entrer en contact avec le sol, l’eau et les êtres vivants, de construire un lieu différent et de le partager en tant qu’œuvre publique correspond tout à fait à la façon dont je conçois le travail artistique. L’art ne se limite pas à fabriquer et à montrer des choses, il peut aussi prendre la forme d’une interaction, d’une prise de conscience et d’un partage. Le Gesamthof fonctionne sans structure financière. Il prospère grâce à l’aide de voisins généreux qui partagent leurs plantes, leurs graines et leurs connaissances. En fin de compte, le jardin donne plus qu’il ne coûte.
Ne planifiez pas votre jardin!
Cela peut sembler contrintuitif, mais, comme on est souvent dans le jardin, on devrait savoir ce dont il a besoin et cela devrait suffire en termes de planning. Le plan de jardin sert habituellement à mettre en forme un jardin idéal, avec une esquisse de ce qu’il faut planter et où, des couleurs à combiner, de l’emplacement du chemin et des matériaux à utiliser, etc. C’est se placer au-dessus de tout en tant que créateur·rice·x et se fixer un objectif à atteindre, avec à la clé un «beau jardin». Je ne pense pas qu’il faille «rendre» les jardins beaux, pas plus qu’il ne faut juger les femmes sur une échelle de beauté. Il s’agit là d’une opposition binaire, d’une façon de penser qui entraîne beaucoup de souffrances, tant à l’intérieur qu’à l’extérieur du jardin. Laissons plutôt le jardin prendre les devants. Vous avez une plante qui aime le soleil? Placez-la dans la partie ensoleillée du jardin: elle prospérera. Vous avez beaucoup de terre nue dans la partie ombragée du jardin et vous ne savez pas quoi en faire? Cherchez des plantes qui aiment l’ombre, choisissez une belle variété et laissez-la pousser dans votre jardin. Il vous faudrait un chemin entre les plantes? Ajoutez le matériau qui convient le mieux à cet endroit (par exemple, l’écorce d’arbre comme matériau forestier – les matériaux recyclés font d’excellents chemins). De cette façon, vous cultiverez un jardin sauvage qui sera beau par lui-même, comme l’est la nature. Faites preuve de créativité dans la façon dont vous disposez les pierres le long d’un chemin, dans la façon dont vous soutenez les plantes qui tombent, dans la façon d’ajouter des points d’eau et d’alimentation, dans la création d’étiquettes, dans la réalisation de dessins qui vous aideront plus tard à vous souvenir de ce que vous avez planté à tel ou tel endroit… Soyez créatif·ve·x!

Intersectionnalité et botanique.
Le lien entre les systèmes de classification botanique et les systèmes de classification des personnes illustre la façon dont un même mode de pensée s’applique à la fois à nos jardins et à nous en tant que personnes. La botanique comporte une importante dimension anthropocentrique et il vaut mieux en être conscient·e·x. Le jardin «lesbien» cherche, lui, à recadrer cette utilisation des jardins. Soudain, la norme invisible de celleux qui bénéficient habituellement des jardins change. Le terme «lesbien» ne signifie rien s’il n’est pas lié aux personnes racialisées, aux différences de classe, aux personnes handicapées, à l’âge et à tous les autres aspects que regroupe la théorie intersectionnelle de Kimberlé Crenshaw. La mise en pratique de l’intersectionnalité implique de poser la «question de l’autre»: à qui profite le jardin?
– Les abeilles ouvrent un dialogue sur les plantes indigènes, leurs génomes et la diversité dans le jardinage;
– les plantes ouvrent un dialogue sur le passé colonial, les systèmes économiques et sur ceux qui ont le «droit» d’extraire;
– un public qui visite des espaces d’art (le Gesamthof est accessible par le Kunsthal Extra City) pose la question de la classe, de l’invitation faite à «l’autre», des espaces accueillants pour la communauté LGBTQIAP+, etc.
– le moi pose la question de l’accès et de la responsabilité qui va de pair avec le privilège.
Poser cette «question de l’autre» signifie que nous sommes conscients des autres. Le Gesamthof est-il approprié pour les enfants? Devrait-il l’être? Faut-il supprimer les plantes toxiques, l’étang, l’hôtel à abeilles, etc., pour assurer la sécurité des enfants? Le Gesamthof est entouré d’une clôture qui empêchent les gens de s’y aventurer, car le jardin n’est certainement pas un lieu sûr pour tout le monde et les gens peuvent eux-mêmes représenter un danger pour le jardin.
Le jardinage atemporel.
Chaque lieu a un passé qui influe sur son avenir. Le passé n’est pas une île lointaine: il est bien là, dans ce « présent épais » (pour reprendre les mots de Donna Haraway, le «présent épais» est une forme de présence en «couches compostées»). Dans mon jardin, je ne veux pas être aveugle à ce qui vient d’un passé colonial. Découvrir comment tout cela est lié, comment l’histoire des jardins botaniques est liée à notre besoin de classification requiert des efforts. Les liens entre colonialisme et jardinage sont nettement moins évidents et compréhensibles que ceux qui lient les plantations et l’esclavage au coton et au café, par exemple. Un jardin est souvent bien plus qu’une collection de plantes dans un espace planifié et le passé colonial n’est pas un sujet facile dans les programmes de jardinage. Il faut visiter le passé pour découvrir ce qui existe aujourd’hui. Personnellement, pour cela, je suis allée au jardin botanique de Meise et j’ai regardé quelles plantes avaient été ramenées des colonies. J’ai également creusé dans le passé de l’emplacement du Gesamthof, dans le monastère: qui a jardiné ici avant moi? Comment puis-je travailler avec l’écologie en vue d’une meilleure compréhension?
Remarque: les gens souffrent de «cécité botanique» (cf. le livre de J. H. Wandersee et E. E. Schussler, «Preventing Plant Blindness, 1999»), ce qui signifie qu’ils ne voient pas les plantes qu’ils ne connaissent pas et qu’en organisant des visites de jardins, on peut sensibiliser à ce biais cognitif. Dans un jardin lesbien, le biais cognitif sonne comme un rappel, car sans représentation, les gens ont du mal à découvrir ce qui est différent chez elleux. De nombreuses lesbiennes ne savent pas qu’elles sont lesbiennes lorsqu’elles grandissent. Elles se voient à travers la norme d’une société hétérosexuelle alors qu’une partie de ce qu’elles sont reste vide pour elles-mêmes. Tout comme la cécité botanique, cette abstraction d’une norme peut être contrée en considérant les différences comme des caractéristiques positives.
Un changement continu.
Un jardin est une belle forme d’art et d’activisme. C’est une activité saine qui aide à soulager le stress et l’anxiété. C’est travailler au changement en s’éduquant soi-même et en éduquant les autres. C’est prendre conscience de la nature et changer notre façon de penser. C’est agréable au nez, à la vue, au toucher, à l’ouïe. C’est un endroit où il fait bon être. Je suis très consciente de l’instant présent quand je suis assise dans le Gesamthof. Le temps passe différemment pour touxtes les habitant·e·x·s et les visiteur·euse·x·s. Certain·e·x·s passent leur vie entière dans ce jardin (c’est le cas de la plupart des pigeons), alors que, pour moi, cela reste très temporaire. Le Gesamthof me manquera quand les nouveaux propriétaires arriveront au monastère. Cependant cela n’en vaut pas moins la peine. À plus grande échelle, le jardinage est synonyme de changement continu et on peut en apprécier chaque instant. Un jardin n’est jamais une chose fixe : il n’est jamais terminé, il n’a pas de «fin»; il se déplace simplement à d’autres endroits.
Images extraites de Gesamthof : A Lesbian Garden, Annie Reijniers et Eline De Clercq, 2022.

Peau Pierre: une capsule sonore
CORPS VOYAGEUR par Jonas Van
Dans une salle au cœur de Genève, en milieu d’après-midi, notre groupe d’artistes se réunit. Une grande quantité d’eau inonde le sol. Collectivement, nous essayons de déplacer cette eau avec nos corps. Mais elle se déplace à une vitesse que nous ne comprenons pas ; il nous est impossible de la transporter physiquement.
Le corps humain compte environ 100 000 kilomètres de vaisseaux sanguins, ce qui est suffisant pour faire deux fois et demi le tour de la Terre. Les vaisseaux sanguins sont constitués d’artères et de veines. « Veine » vient du latin « vena » : petit canal souterrain naturel d’eau. En fait, en prenant l’eau entre nos mains, nous imitons le mouvement circulatoire sanguin du corps, mais à l’extérieur de celui-ci.
L’eau sur le sol catalyse nos mémoires. Et lorsque nos peaux se touchent finalement, l’eau est l’intermédiaire de cette rencontre. C’est ainsi qu’une fissure temporelle s’ouvre dans cette salle au cœur de Genève. Nos peaux, imitant le mouvement du système circulatoire, se sont progressivement réchauffées jusqu’à produire un frottement suffisant pour que l’eau entraîne le corps dans un voyage à travers l’espace-temps. L’exercice suivant a été de parler de l’endroit où nous avions voyagé. Ces voyages ont pris la forme de capsules sonores.
Cette histoire spéculative fait partie du Glossaire de la Transition T-T, un outil conçu par Ritó Natálio pour développer une forme d’éducation environnementale qui encourage les pratiques artistiques comme moyen de comprendre et d’appliquer la théorie écologique aux défis sociétaux. Cette capsule sonore est une œuvre de Jonas Van Holanda, inspirée des ateliers du projet Peau Pierre, dont il a été l’artiste en résidence.
Peau Pierre: une capsule sonore par Jonas Van Holanda
Le pain sauvage
«Il pane selvaggio» (Le pain sauvage, 1980) est un essai du philologue, historien et anthropologue italien Piero Camporesi sur l’expérience de la faim en Europe à l’époque moderne. La faim dans l’hémisphère Nord peut sembler un problème lointain, mais l’accès à une alimentation adéquate, saine et abordable, connait toujours de profondes inégalités, tant à travers le monde qu’au sein des communautés.
Le «pain sauvage» mentionné dans le titre fait référence au pain des plus démunis qui, pour faire face aux pénuries de céréales en période de famine, ont commencé à moudre de la farine à partir de racines, de graines ou de champignons – tout ce qui pouvait remplir l’estomac et être cueilli ou ramassé librement sur les quelques terres non privées encore disponibles. Le produit final était un pain rassis, toxique et non nutritif, qui provoquait souvent des états hallucinatoires.
Les hommes instruits, riches et puissants qui relataient l’histoire des famines avaient la possibilité de ne pas rendre compte de l’expérience des personnes les plus fragiles. Piero Camporesi a donc retrouvé dans la littérature populaire les récits de celles et ceux qui n’ont jamais pu rêver d’un morceau de pain blanc sur leur table, comme le dit la chanson du XVIe siècle «Lamento de un poveretto huomo sopra la carestia» (Complainte d’un pauvre homme sur la famine).

Mauvaise chose est la famine,
Qui met l’homme toujours dans le besoin,
Et le fait jeûner contre son gré
Seigneur Dieu éloigne-la…
J’ai vendu mes draps,
J’ai mise en gage mes chemises
Et désormais c’est des chiffoniers
Que je porte le costume
Pour ma grand peine et douleur
Seul un morceau de toile à sacs
Couvre la chair qui est la mienne.
La douleur tant serre mon cœeur
Quand je cois mon enfant
Me dire souvent, heure après heure
«Papa, un peu de pain»:
Il me semble que mon âme s’en va
Quand je ne peux pas à ce malheureux
Donner du secours, oh maudit sort
Mauvaise chose est la famine.
Mais si je sors de ma maison
Et demande un sou pour l’amour de Dieu
Tous me disent «va donc travailler»
«Va donc travailler», ah! quelle adversité!
Je n’en trouve pas, je n’ai pas de chance:
Èt je reste tête baissée,
Ah! sort cruel et funeste
Mauvais chose est la famine.
A la maison je n’ai plus d’écuelles
J’ai vendu les marmites
Èt j’ai vendu les poêles
Je suis tout dépouillé…
Bien souvent des trognons de choux frisés
Me servent de pain,
Dans la terre je fais des trous
Pour trouver toutes sortes d’étranges racines
Nous nous en frottons le museau.
S’il y en avait tous le jours
Cela ne serait pas si mal
Mauvais chose est la famine.
Image: Luca Trevisani, Ai piedi del pane, 2022.
Oplà. Performing Activities, organisé par Xing, Arte Fiera, Bologne.
Vivre le Rhône: le podcast, partie 03
Vivre le Rhône: un podcast de Audrey Bersier et Martin Reinartz
Cher·e·x auditeur·rice·x,
Depuis juin 2022, le Natural Contract Lab et l’association least déploient des pratiques de marche accompagnée, de tissage collectif, de rituels de soins, d’expériences somatiques et de cercles réparateurs, autant de pratiques permettant de repenser la relation que les humains entretiennent avec le Rhône.
Ce que vous allez écouter est le dernier épisode d’un podcast en trois parties, retraçant l’expérience de celleux qui se sont rapproché·e·x·s du fleuve en marchant.
Cet épisode marque la fin d’un voyage collectif entre le Rhône et nous, il clôt une aventure.
Mais ce n’est pas un adieu, car l’eau n’a ni début, ni fin.
Pour l’écoute de ce podcast, j’aimerais vous inviter à vous connecter à l’eau. Rendez-vous au bord de votre rivière préférée, marchez sous la pluie, regardez la mer ou servez-vous un verre d’eau que vous boirez en conscience…
Le Rhône s’écoule en chacun·e·x de nous.

Vivre le Rhône: le podcast, ep.03
Écoutez la partie 01.
Écoutez la partie 02.
Vegetaltruite réalisée par Maud Abbé-Decarroux.
Avec des textes librement inspirés de Nos Cabanes de Marielle Macé
*Tous les efforts possibles ont été faits pour obtenir les autorisations nécessaires et pour retrouver les détenteur·trice·x·s de droits d’auteur·trice·x·s, mais nous serons heureux·se·x de prendre les dispositions utiles pour obtenir l’autorisation de reproduire le matériel contenu dans ce podcast auprès des détenteur·trice·x·s de droits d’auteur·trice·x·s qu’il n’a pas été possible de contacter.
Avec le soutien de la Fondation d’entreprise Hermès et de la Fondation Jan Michalski.
Vivre le Rhône: le podcast, partie 02
Vivre le Rhône: un podcast d’Audrey Bersier et Martin Reinartz
Cher·e·x auditeur·rice·x,
Depuis juin 2022, le Natural Contract Lab et l’association least déploient des pratiques de marche accompagnée, de tissage collectif, de rituels de soins, d’expériences somatiques et de cercles réparateurs. Autant de pratiques permettant de repenser la relation que les humains entretiennent avec le Rhône.
Ce que vous allez écouter est le deuxième épisode d’un podcast en trois parties, retraçant l’expérience de celleux qui se sont rapproché·e·x·s du fleuve en marchant.
J’aimerais vous souffler quelques conseils avant que vous vous lanciez dans l’écoute de ce podcast.
Si vous en avez la possibilité, rendez-vous à Vernier Village dans la campagne genevoise. Prenez de bons écouteurs avec vous et votre gourde avec de l’eau ou votre tisane préférée. Une fois arrivé·e·x, lancez la lecture de l’audio.
Vous pourrez ensuite marcher pour rejoindre le fleuve, puis emprunter la passerelle de Chèvres, comme indiqué sur la carte qui suit.

Vous pouvez aussi vous installez simplement dans un endroit qui vous est agréable. Et fermez les yeux.
Bonne écoute !
Vivre le Rhône: le podcast, ep.02
Écoutez la partie 01.
Écoutez la partie 03.
Carte réalisée par Maud Abbé-Decarroux.
*Tous les efforts possibles ont été faits pour obtenir les autorisations nécessaires et pour retrouver les détenteur·trice·x·s de droits d’auteur·trice·x·s, mais nous serons heureux·se·x de prendre les dispositions utiles pour obtenir l’autorisation de reproduire le matériel contenu dans ce podcast auprès des détenteur·trice·x·s de droits d’auteur·trice·x·s qu’il n’a pas été possible de contacter.
Avec le soutien de la Fondation d’entreprise Hermès et de la Fondation Jan Michalski.
Spillovers
«Spillovers» de Rita Natálio allie la performance à l’écriture, l’imagination à l’expérience somatique, via des outils tels que le transféminisme et l’écologie. Il s’agit d’un texte inhabituel, d’un manuel sexuel, d’un essai de science-fiction sur l’eau et le plaisir qui propose une réinterprétation de «Brouillon pour un dictionnaire des amantes» de Monique Wittig et Sande Zeig. «Spillovers», dont voici un extrait, présente un glossaire qui définit des protocoles sensoriels et chorégraphiques comme outils de décryptage et de compréhension des greffes humaines/non-humaines. Le mouvement est la matière qui forme son écriture etrassemble des archives d’images et de livres sur les théories et les pratiques écoféministes.
En 2020, un livre a été trouvé dans un puits. Ce puits, comme beaucoup d’autres cavités, était contaminé par des activités de monoculture intensive. Son eau, rendue insalubre, s’était alors tarie indéfiniment. C’est donc dans ce trou, asséché mais viscéralement marqué par le souvenir de l’eau, qu’a été retrouvée une traduction de «Brouillon pour un dictionnaire des amantes», écrit en 1976 par Monique Wittig et Sande Zeig. À l’époque, ce livre aurait pu être vu comme le manuel ou le texte fondateur d’un certain type de culte religieux ou de rituel spirituel. Bien plus tard, on a su qu’il s’agissait en fait d’un journal où étaient consignées les transformations fugaces d’un langage trans-corporel et élémentaire, ainsi que des archives de pratiques qui rassemblaient et reliaient des descriptions d’objets, de figures, de problèmes et de stratégies politico-affectives que la communauté des Spillovers (à l’époque appelées «amantes», ou «femmes lesbiennes», tout simplement) avaient tenté de mettre en œuvre dans leur quotidien face aux agressions croissantes du turbo-capital et de la science moderne de la division. Voir, par exemple, l’entrée du dictionnaire pour «Circulation»:
Circulation
Processus physique de mélange de deux corps. Si l’on considère deux corps chargés de chaleur et d’électricité qui sortent de la peau par les pores, et que ces deux corps s’étreignent, vibrent et commencent à se mêler, il se produit une réaction de conduction et de circulation qui fait que chaque pore absorbe l’énergie qu’il a exhalée précédemment mais sous une autre forme. La rapidité de ce phénomène, la transformation de la chaleur et de l’électricité en énergie produisent une irradiation intense des corps qui pratiquent la circulation. C’est ce que les amantes veulent dire quand elles disent «je te circule», «tu me circules».
Dans le livre, on comprend que les amantes se perçoivent comme des sortes de membranes, cherchant à entrer en relation les unes avec les autres par le biais de leur propre écologie de connexions et de ses limites. Pourtant, en 1976, beaucoup d’entre nous n’avaient que deux ans ou venaient d’apprendre à utiliser un anneau ou une baguette pour chercher de l’eau. Et le problème était que nous ne savions pas de qui nous parlions lorsque nous disions «nous», comme l’a dit l’un⋅e⋅x d’entre nous à l’époque(1). Le pronom personnel pluriel était une pratique qui nous permettait simplement de ne pas disparaître dans d’autres pronoms qui ignoraient nos vies, même si nous ne savions pas exactement qui nous étions.
«Lesbiennes» ou «femmes» étaient des mots-conteneurs qui nous semblaient inadéquats, mal adaptés. En 1976, nous ne savions pas grand-chose de la rabdomancie, de l’hydro-féminisme ou de l’écoulement de l’eau à travers différentes échelles, différents corps et différents genres. Se tenir en équilibre sur deux jambes était quelque chose que nous savions faire sans problème, tout comme la lecture, même si certaines contraintes de vision et de verticalité nous empêchaient d’aborder l’irradiation de l’énergie de manière plus complexe. La recherche de l’eau avec un bâton nécessitait une initiation, une attention particulière, et l’utilisation d’antennes communes aux réseaux d’amantes était une technologie qui n’était pas (encore) facilement accessible.

Le glossaire présenté ici propose une certaine continuité avec l’intuition de Monique Wittig et Sande Zeig, tout en spéculant sur les anneaux et la fiction-panier(2) que les Spillovers doivent toucher et tisser pour enchevêtrer les époques et produire de l’eau. Il ne faut pas craindre de se mouiller. Et encore moins de ressentir de la douleur en buvant de l’eau sale, ou en regardant un robinet d’eau s’embraser de méthane libéré par la fracturation hydraulique. Toutes ces dimensions, aussi pénibles soient-elles, organisent l’amour entre les Spillovers. Et bien que l’on puisse parfois se passer de la centralité des yeux et de la lecture, les images et les dialogues avec les pratiques cinématographiques indigènes, la poésie radicale et les philosophies contre-coloniales sont invoquées ici et ne requièrent que des choses plutôt simples: que les mondes soient d’abord expérimentés à partir de ces références, de Dionne Brand au Karrabing Film Collective, d’Astrida Neimanis à Ursula K. Le Guin. C’est le geste nécessaire et antihéroïque de 2020: oublier et couper toute communication avec les élites anthropocéniques, tout en portant de l’eau à celleux qui en ont besoin. Comme le dit un proverbe zen: «Avant l’illumination (…) portez de l’eau. Après l’illumination (…) portez de l’eau».
GLOSSAIRE
1. Spillovers
Être une amante signifie, toujours, être un⋅e⋅x Spillover. L’effet de «spillover» ou de débordement, qui provoque la fuite de liquides et d’intentions, est la condition première de la coopération amoureuse multi-espèces et intersexe, que ces liquides soient génitaux, lacrymaux, ou qu’ils jaillissent de parties du corps moins évidentes, comme les coudes ou les pieds. L’eau est produite à la rencontre de deux entités ou plus et, si elle est correctement placée dans des sacs, elle peut se transmuter en liquide amniotique, un liquide aux propriétés amnésiques où d’autres entités peuvent être mises en gestation. Il n’est pas courant de boire le liquide amniotique, à moins qu’il ne soit enterré dans la terre ferme, une pratique qui vise à générer de l’eau en période de pénurie ou de contamination. Les Spillovers sont touxtes celleux qui, dans une vie sans protagonistes, souhaitent déborder, se répandre et sortir d’elleux-mêmes, et franchir ainsi les frontières souples entre les peuples, les territoires et les paysages.
2. Sacs
Les sacs sont des technologies de spillover/débordement dotées d’une multitude de fonctions. Ils peuvent engendrer et porter des bébés et peuvent passer d’un corps à l’autre, quel que soit leur sexe. Ils peuvent transporter de l’eau. Ils transportent du liquide amniotique, mais aussi des idées ou des histoires. Ils sont auto-guérissant et biodégradables, mais il y a une limite à leur utilisation: ils ne sont pas jetables. Les sacs ne génèrent pas seulement des bébés humains, ils peuvent aussi créer une parenté végétale ou minérale et c’est ainsi qu’on parle parfois de bébé plante ou de bébé rocher. Les sacs servent également de stratégie de résilience en cas de contamination aigüe des eaux souterraines (comme le montre le film «Mermaids or Aiden in the Wonderland»), réalisé par le Karrabing Film Collective en 2018). Dans les situations d’urgence, ils peuvent franchir des frontières rigides, telles que celles qui divisent les États-nations actuels. Ce sont des outils de migration ou de transmigration des corps qui ont la capacité temporaire de désactiver les passeports.
3. Iris
On dit qu’il y a longtemps, les Spillovers ont expérimenté le transport d’eau, puis des mots dans les sacs susmentionnés, fournissant ainsi aux sociétés multi-espèces des liens inattendus et opaques. Depuis lors, chaque fois que l’eau touche un mot à l’intérieur d’un sac, celui-ci peut le scinder en plusieurs parties: c’est ce qu’il s’est passé, par exemple, avec les mots «clitoris» (clito-iris) et «iridescent» (iris-descent), des instruments de concentration et d’épanouissement émotionnels. Depuis lors, lorsqu’un⋅e⋅x ou plusieurs Spillovers parviennent à remplir et à transporter un sac rempli d’eau dans un territoire dominé par la pensée monoculturelle, leur iris se gonfle comme s’il s’agissait d’un clitoris, générant ainsi une pluie dorée hautement hydratante suivie d’un arc-en-ciel multicolore (un arc-en-ciel irisé) dans le ciel. Cet événement génère un plaisir intense, mais on ne peut le qualifier d’héroïque, ni le confondre avec la tendance masculine à vénérer des figures phalliques singulières. En effet, comme le dirait Spillover K. Le Guin, «[…] il est clair que le Héros ne fait pas bonne figure dans ce sac. Il a besoin d’une scène, d’un piédestal ou d’un pinacle. Vous le mettez dans un sac et il ressemble à un lapin ou à une pomme de terre»(3).
(1) Adrienne Rich, «Notes towards a politics of location», 1984.
(2-3) Ursula K. Le Guin, «The Carrier Bag Theory of Fiction», 1986.
Vivre le Rhône: partie 2
Qui a la légitimité de parler au nom du fleuve ?
Maria Lucia Cruz Correia, initiatrice du projet Vivre le Rhône, Marine Calmet, avocate en droit de l’environnement, et Martin Reinartz, artiste en résidence par least, parlent des droits de la nature et de la gouvernance du fleuve. Juin 2023.
Cliquez ici pour la partie 1.
Cliquez ici pour la partie 3.
Gardien·ne·x·s de la nature
Avocate de formation, Marine Calmet est une juriste spécialisée sur les questions de protection de l’environnement et des peuples autochtones. Elle est également présidente de l’association Wild Legal, qui a pour mission la reconnaissance des droits de la nature, et l’autrice du livre «Devenir gardiens de la nature», qui a inspiré ses combats en Guyane française contre les mines d’or illégales et les industries des hydrocarbures. Elle fait partie de l’équipe de Natural Contract Lab pour le projet Vivre le Rhône.
Lorsqu’on parle des droits de la nature, une question revient souvent: qui peut légitimement parler au nom d’un écosystème?
Je pense que c’est très lié à l’idée que, dans nos sociétés, nous avons des rôles et des statuts spécifiques. Personnellement, j’aime renverser la question. Il s’agit plutôt de se demander quelle est notre raison de vivre et quelle est notre mission dans notre société. Je pense que nous pouvons tous légitimement représenter des entités naturelles, tout simplement par la responsabilité que nous confère le fait d’habiter sur cette planète, d’habiter un milieu de vie et donc d’être en capacité d’avoir une relation plus ou moins forte avec une rivière, une forêt ou une montagne. Pour moi, la légitimité vient donc du lien d’empathie, d’amour même, qui existe entre nous et la nature dans laquelle nous vivons et avec laquelle nous interagissons. J’essaie de déconstruire ce mythe selon lequel nous ne serions pas légitimes et n’aurions pas la capacité de parler au nom de la nature en posant la question suivante: de quelle nature parle-t-on? N’y a-t-il pas des écosystèmes dont nous sommes si proche que nous ressentons la responsabilité de défendre leurs intérêts?
Quel est, selon vous, le rôle des droits de la nature dans la gouvernance des fleuves?
Le modèle des droits de la nature a pour ambition de sortir les éléments de la nature du statut d’objet, qui objective notre relation avec eux et nous conduit à considérer l’ensemble des êtres qui nous entourent comme des ressources et des biens exploitables que nous pouvons détruire ou dont nous pouvons bénéficier pour le progrès humain et pour nos sociétés. Le but est de remettre en question cette relation d’objectivation en considérant plutôt que nous avons autour de nous des sujets, des sujets juridiques même, qui bénéficient ou qui devraient bénéficier d’une protection due à leurs droits fondamentaux, inhérents à leur statut de sujets. C’est là que le droit vient éclaircir ou proposer une solution pour ces relations qui, en vérité, pour beaucoup d’entre nous, existent sans qu’elles n’aient jamais vraiment été clarifiées.
Le droit de la nature vient donc nous dire: «Nous sommes entourés de sujets auxquels nous devons aussi une certaine forme de respect et avec lesquels les interactions doivent être protégées pour que l’habitabilité des écosystèmes soit conservée et que cet espace de vie qui est le nôtre reste serein et harmonieux».
Dans cette gouvernance que nous appelons à instaurer, cette gouvernance du vivant, le but est donc d’intégrer les autres qu’humains, pour que, au lieu d’un dialogue strictement entre êtres humains, on puisse ouvrir le débat aux non-humains et les intégrer dans nos modèles de représentation. Ceci afin de nous permettre de sortir de ce qu’on appelle l’anthropocène, un anthropocène qui n’est autre qu’un entre-soi, entre humains, et d’intégrer les autres qu’humains dans cette gouvernance. Cela ne peut se faire qu’en reconnaissant la nature et l’ensemble de ses éléments comme des sujets à part entière et non comme des objets, parce qu’on ne peut pas dialoguer avec des objets.
En tant que juriste, vous collaborez avec des artistes: comment ces deux perspectives apparemment éloignées peuvent-elles se rencontrer de façon positive? Comment se bousculent-elles?
Ce que je trouve fascinant dans l’interaction entre l’art et le droit, c’est cet apport de similitudes. En tant qu’avocate, en tant que juriste, je travaille sur le droit qu’on appelle «droit prospectif», c’est à dire un droit d’anticipation sur l’avenir. J’écris du droit, j’invente du droit, en me basant sur ce que j’observe dans la nature et des besoins ou des crises que j’observe. En tant que juriste, je suis donc moi aussi dans une fiction, celle d’écrire quelque chose que j’imagine ou que je considère souhaitable. J’agis comme un·e·x artiste qui projette sa vision du monde sur une toile ou sur une scène, mais je le fais dans un cercle spécifique, celui du droit. Le droit, comme l’art, est donc un ensemble de fictions qui relèvent aussi bien d’une forme d’esthétisme. Je me considère d’ailleurs plus souvent comme une artiste que comme une juriste, parce que je suis dans la création, une forme de création libre qui me pousse à suivre mon instinct.
Ce que j’aime beaucoup dans mon travail avec Maria Lucia Cruz Correia et le Natural Contract Lab, c’est qu’elle m’indique souvent des pistes auxquelles je n’avais pas pensé ou que j’avais peut-être parfois tendance à envisager de façon trop juridique, trop centrée sur l’existant, sur ce qu’on appelle le droit positif, c’est à dire ce qui est déjà là, au lieu de penser en dehors de ce cadre, en m’inspirant et en créant différemment. Très souvent, cela me permet donc de faire des progrès gigantesques dans ce métier qui est le mien, parce qu’elle me permet d’ouvrir des portes que je n’avais pas imaginées.
C’est là qu’il y a un lien très fort. Tout comme les artistes sont capables de penser des choses jusqu’alors impensées, cela me permet, dans le monde juridique, de faire des progrès énormes, des bonds en avant. C’est aussi une manière de rendre le droit accessible à tout le monde, chose qui répond plutôt à la perspective artistique.
Ce qui est intéressant, c’est aussi de transmettre un message. Les gens voient alors ce qu’est le droit. Ils en ont parfois un peu peur, et l’utiliser dans une performance artistique est moyen intéressant de le rattacher à un contexte politique et à une vision, celle de la construction d’un nouvel idéal. Il y a donc vraiment, je trouve, des liens très intéressants, notamment au-travers des plaidoiries qu’on construit ensemble. La plaidoirie, c’est de l’art oratoire et l’art oratoire, c’est l’art de convaincre l’autre. Que ce soit dans le théâtre ou dans les tribunaux, nous sommes aussi là pour convaincre, d’une certaine manière, et pour transmettre un message. Il y a donc des liens inhérents, très forts, entre artistes et juristes, qui nous permettent de nous enrichir mutuellement.
Corps d’eau
Le passage de la vie aquatique à la vie terrestre est l’une des étapes les plus importantes de l’évolution de la vie sur Terre. Cette transition s’est déroulée sur des millions d’années, alors que les premiers organismes aquatiques s’adaptaient aux défis et aux opportunités présentés par l’environnement terrestre. Parmi ces défis, citons la nécessité de conserver l’eau: les êtres vivants devaient en quelque sorte «intégrer la mer en eux», même si l’eau biologique, bien que notre corps en soit principalement composé, ne représente en vérité que 0,0001 % de l’eau totale sur Terre.
L’eau est impliquée dans de nombreuses fonctions essentielles de notre corps, notamment la digestion, la circulation et la régulation de la température. Néanmoins, nos fluides corporels, qu’il s’agisse de la sueur, de l’urine, de la salive ou des larmes, ne sont pas seulement contenus dans nos corps individuels, mais font partie d’un système plus vaste qui inclut toute la vie sur Terre, brouillant les frontières entre notre corps et les corps plus qu’humains et nous reliant au monde qui nous entoure. Les spécialistes ont décrit cette idée sous le nom de hypersea: les fluides qui circulent dans notre corps sont liés aux océans, aux rivières et aux autres étendues d’eau qui composent la planète et font partie d’un système plus vaste qui relie tous les êtres vivants.
Reconnaître l’interconnexion de toutes les formes de vie sur Terre et le rôle que joue l’eau dans ce réseau interconnecté peut nous aider à mieux comprendre notre place dans le monde et l’importance de travailler ensemble pour protéger et préserver ce précieux élément. Cependant, pour saisir pleinement les conséquences de cette perspective, il est judicieux d’examiner certaines questions abordées par la spécialiste Astrida Neimanis, théoricienne de l’hydro-féminisme, dans son livre «Bodies of Water».
L’une des principales contributions de la pensée hydro-féministe au débat sur les étendues d’eau concerne la proposition de rejeter la notion abstraite de l’eau à laquelle nous sommes habitués. L’eau est généralement décrite comme un liquide inodore, insipide et incolore qui se raconte à travers un cycle schématique et déterritorialisé qui ne représente pas efficacement la réalité évolutive et pourtant située des étendues d’eau. L’eau est principalement interprétée comme une ressource neutre que nous devons gérer et consommer, alors qu’il s’agit d’un élément complexe et puissant qui affecte nos identités, nos communautés et nos relations. De profondes inégalités existent dans nos systèmes d’eau actuels, façonnés par des structures sociales, économiques et politiques.

Astrida Neimanis cite un exemple explicitement lié aux fluides corporels. Le projet «Mothers’ Milk», mené par la sage-femme mohawk Katsi Cook, a révélé que les femmes vivant dans la réserve mohawk d’Akwesasne présentaient une concentration de PCB supérieure de 200 % dans leur lait maternel, en raison du déversement de boue de General Motors dans des fosses situées à proximité. Les polluants tels que les POP (polluants organiques persistants) sont transportés par les courants atmosphériques et se déposent dans l’Arctique, où ils se concentrent dans la chaîne alimentaire et sont consommés par les communautés arctiques. En conséquence, le lait maternel des femmes inuites contient deux à dix fois plus de concentrations d’organochlorés que les échantillons prélevés sur les femmes des régions méridionales. Ce «fardeau corporel» présente des risques pour la santé et affecte le bien-être psychologique et spirituel des femmes allaitantes. Le déversement des PCB est une décision humaine, mais la perméabilité du sol, le tracé de la rivière et l’appétit des poissons sont pris dans ces courants, ce qui en fait un problème multi-espèces.
Ainsi, même si nous sommes tous dans la même tempête, nous ne sommes pas tous dans le même bateau. L’expérience de l’eau est façonnée par des facteurs culturels et sociaux, tels que le sexe, la race et la classe, qui peuvent affecter l’accès à l’eau potable et la capacité à participer à la gestion de l’eau. L’histoire des femmes inuites montre clairement que l’eau, même si elle fait partie d’un cycle planétaire unique, est toujours incarnée, tout comme les plans d’eau et leur interdépendance complexe. Si l’hydro-féminisme nous invite à rejeter une perspective individualiste et statique, il nous rappelle également que les différences doivent être reconnues et respectées. En effet, ce n’est que de cette manière que la pensée peut être transformée en action vers des relations plus équitables et durables avec toutes les entités.
Astrida Neimanis aborde également le rôle de l’eau en tant qu’élément gestationnel, une métaphore du pouvoir transformateur et mystérieux de cette substance qui donne la vie. À l’instar du liquide amniotique qui entoure et nourrit un animal en pleine croissance, l’eau peut soutenir et entretenir la vie, nourrir et protéger, et favoriser la croissance et le développement. En ce sens, l’eau peut être considérée comme un symbole d’espoir et de possibilité, une source de renouveau et de régénération qui peut nous aider à faire face aux défis et aux transitions de la vie. Comme un élément gestationnel, l’eau a le pouvoir de nettoyer, de guérir et de transformer. Alors que nous cherchons à trouver notre voie dans un monde en constante évolution, nous pouvons considérer l’eau comme une source intérieure de force et d’inspiration, un rappel de la résistance et de l’adaptabilité de la vie, ainsi que du potentiel qui réside en chacun de nous.
Image: Edward Burtynsky, Centrale géothermique de Cerro Prieto, Baja, Mexique, 2012. Photo © Edward Burtynsky.
Intimité entre étrangers
Couvrant près de 10 % de la surface de la Terre et pesant 130.000.000.000.000 tonnes – plus que l’ensemble de la biomasse océanique — ils ont révolutionné notre compréhension de la vie et de son évolution. Pourtant, peu de gens auraient parié sur cette espèce unique et néanmoins discrète: les lichens.
Il y a 410 millions d’années, les lichens étaient déjà présents et semblent avoir contribué, par leur capacité érosive, à la formation du sol de notre planète. Les premières traces de lichens ont été trouvées dans le gisement fossile de Rhynie, en Écosse, et datent du Dévonien inférieur — le stade le plus précoce de la colonisation des masses terrestres par des êtres vivants. Leur résistance a été testée au cours de diverses expériences: les lichens peuvent survivre sans dommage à un voyage dans l’espace, supporter une dose de radiation douze mille fois supérieure à une dose mortelle pour l’être humain, survivre à une immersion dans l’azote liquide à -195°C et vivre dans des zones désertiques extrêmement chaudes ou froides. Ils sont si résistants qu’ils peuvent même vivre pendant des millénaires: on a retrouvé un spécimen arctique de «lichen géographique» vieux de 8 600 ans, ce qui en fait le plus ancien organisme vivant découvert au monde.
Les lichens ont longtemps été considérés comme des plantes. Aujourd’hui encore, beaucoup les voient comme une sorte de mousse. Cependant, l’évolution technologique des microscopes au XIXe siècle a permis l’émergence d’une nouvelle découverte. Le lichen n’est pas un organisme unique, mais consiste plutôt en un système composé de deux êtres vivants différents, un champignon et une algue, unis au point d’être essentiellement indissociables. Peu de gens savent que le mot «symbiose» a été inventé précisément pour faire référence à l’étrange structure du lichen. Aujourd’hui, on sait que les lichens sont bien plus qu’une simple alliance entre un champignon et une algue. Il existe, en fait, une importante diversité d’êtres impliqués dans le mécanisme symbiotique, qui comprend fréquemment d’autres champignons, des bactéries ou des levures. Il n’est plus question d’un seul organisme vivant, mais bien d’un biome tout entier.
La théorie de la symbiose a longtemps été contestée, car elle mettait à mal la structure taxonomique de l’ensemble du règne du vivant telle que Charles Darwin l’avait décrite dans «De l’origine des espèces», c’est-à-dire un système «arborescent» composé de branches progressives. L’idée que deux «branches» (appartenant, de surcroît, à des règnes différents) puissent se croiser remettait tout en question. De façon significative, le fait que la symbiose fonctionne comme une coopération mutuellement bénéfique bouleversait l’idée selon laquelle tout processus d’évolution se fonde sur la compétition et le conflit.
La symbiose est loin d’être une condition minoritaire sur notre planète: 90 % des plantes, par exemple, sont caractérisées par la «mycorhize», un type particulier d’association symbiotique entre un champignon et les racines d’une plante. Parmi celles-ci, 80 % ne survivraient pas si elles étaient privées de leur association avec un champignon. De nombreuses espèces de mammifères, dont l’humain, vivent en symbiose avec leur microbiome: un ensemble de micro-organismes qui évoluent dans le tube digestif et permettent l’assimilation des nutriments. Il s’agit là d’une relation symbiotique très ancienne et spécifique: chez l’humain, la différence génétique du microbiome entre une personne et une autre est plus grande encore que leur différence génétique cellulaire. Pourtant, le succès évolutionnaire des relations symbiotiques ne se limite pas à ces données extraordinaires: il est essentiel à l’émergence de la vie telle que nous la connaissons, dans un processus que la biologiste Lynn Margulis a nommé «symbiogenèse».
La symbiogenèse postule que les premières cellules sur Terre sont issues de relations symbiotiques entre des bactéries, qui se sont développées en organites responsables du fonctionnement cellulaire. Plus précisément, les chloroplastes — les organites capables d’effectuer la photosynthèse — sont issus de cyanobactéries, tandis que les mitochondries — les organites responsables du métabolisme cellulaire — proviennent de bactéries capables de métaboliser l’oxygène. La vie, semble-t-il, a évolué à partir d’une série de rencontres symbiotiques et, malgré de nombreux changements catastrophiques liés à la géologie, à l’atmosphère et aux écosystèmes de la planète à travers le temps profond, elle s’écoule sans interruption depuis près de quatre milliards d’années.
Plusieurs scientifiques tendent à interpréter la symbiose chez les lichens comme une forme de parasitisme de la part du champignon, car ce dernier retirerait davantage de la relation que les autres organismes. Ce à quoi le naturaliste David George Haskell, dans son livre «The Forest Unseen», répond: «Comme une agricultrice qui s’occupe de ses pommiers et de son champ de maïs, un lichen est une fusion de vies. Une fois l’individualité dissoute, le tableau des vainqueurs et des victimes n’a plus guère de sens. Le maïs est-il opprimé? La dépendance de l’agricultrice vis-à-vis du maïs fait-elle d’elle une victime? Ces questions sont fondées sur une séparation qui n’existe pas.» La coopération multi-espèces se trouve au centre même de la vie sur notre planète. Des lichens aux organismes unicellulaires en passant par notre vie quotidienne, la biologie nous parle d’un monde vivant dans lequel la solitude n’est pas une option viable. Lynn Margulis a décrit la symbiose comme une forme «d’intimité entre étrangers» au cœur même de la vie, de l’évolution et de l’adaptation.

Vivre le Rhône: le podcast, partie 01
Vivre le Rhône: un podcast d’Audrey Bersier et Martin Reinartz
Cher·e·x auditeur·rice·x,
Depuis juin 2022, le Natural Contract Lab et l’association least déploient des pratiques de marche accompagnée, de tissage collectif, de rituels de soins, d’expériences somatiques et de cercles réparateurs. Autant de pratiques permettant de repenser la relation que les humains entretiennent avec le Rhône.
Ce que vous allez écouter est le premier épisode d’un podcast en trois parties, retraçant l’expérience de celleux qui se sont rapproché•es du fleuve en marchant.
J’aimerais vous souffler quelques conseils avant que vous vous lanciez dans l’écoute de ce podcast.
Si vous en avez la possibilité, rendez-vous sur le pont du Seujet, qui se trouve en plein centre de Genève. Prenez de bons écouteurs avec vous, de quoi écrire et votre gourde avec de l’eau ou votre tisane préférée. Une fois arrivé•e, lancez la lecture de l’audio.
Vous pourrez choisir de rester sur le pont ou de marcher le long du fleuve, en direction du pont Butin par exemple, comme indiqué sur la carte qui suit.

Vous pouvez aussi vous installez simplement dans un endroit qui vous est agréable. Et fermez les yeux.
Bonne écoute!
Vivre le Rhône: le podcast, ep.01
Avec des textes librement inspirés de L’inconnue du Haut-Rhône et Les Sœurs Caramarcaz de Corinna S. Bille, ainsi que Voyage en Suisse d’Alexandre Dumas.
Carte réalisée par Maud Abbé-Decarroux.
Écoutez la partie 02.
Ècoutez la partie 03.
*Tous les efforts possibles ont été faits pour obtenir les autorisations nécessaires et pour retrouver les détenteur·trice·x·s de droits d’auteur·trice·x·s, mais nous serons heureux·se·x de prendre les dispositions utiles pour obtenir l’autorisation de reproduire le matériel contenu dans ce podcast auprès des détenteur·trice·x·s de droits d’auteur·trice·x·s qu’il n’a pas été possible de contacter.
Avec le soutien de la Fondation d’entreprise Hermès et de la Fondation Jan Michalski.
Un monde sous-optimal
Biologiste transdisciplinaire et chercheur à l’Institut national de recherche sur l’agriculture, l’alimentation et l’environnement (INRAE) à Lyon, Olivier Hamant est engagé dans des projets d’éducation à la question socio-écologique à l’institut Michel Serres. Son livre «La troisième voie du vivant» envisage un avenir «sous-optimal» pour survivre à la crise environnementale: dans cet entretien, l’auteur fait l’éloge de la lenteur, de l’inefficacité et de la robustesse, et nous enjoint d’accepter un certain degré de chaos dans nos vies.
Auteur-e-s et philosophes se sont toujours inspiré-e-s de la nature pour spéculer sur la réalité et la société, mais souvent avec une approche instrumentale. Vous aussi, vous vous inspirez de la nature, mais, partant de votre position de biologiste, vous arrivez à des considérations qui remettent en cause nos préjugés sur le fonctionnement de la nature. Comment votre questionnement a-t-il commencé?
Pendant mon doctorat, mes travaux ont porté sur la biologie moléculaire appliquée aux plantes. Je me suis intéressé à des questions de contrôle génétique et informationnel. C’était un exemple évident d’imaginaire industriel transposé à la biologie: on utilisait des organigrammes, on dessinait des schémas de cascades de gènes, on parlait de «lignes de défense» ou de «canalisation métabolique»… Toute une sémantique qui implique que la vie serait comme une machine. Après mon doctorat, j’ai voulu faire quelque chose de plus intégré et interdisciplinaire, afin d’avoir une vision systémique de la biologie. Cette trajectoire ma confirmé que ce que je croyais savoir était erroné: j’avais été pollué par ce concept du «vivant-machine» et c’est là que j’ai commencé à dévier.
Le livre est une véritable leçon de «désapprentissage». Vous vous amusez à renverser certains concepts contemporains qui peuvent sembler positifs mais qui ne le sont finalement pas, comme «l’optimisation» par exemple.
L’optimisation est l’archétype du réductionnisme: pour optimiser, il faut d’abord réduire le problème pour le résoudre. En général, quand on résout un petit problème, on en crée d’autres ailleurs. Prenez l’exemple du canal de Suez: c’est une optimisation, du transport maritime en l’occurrence, qui nous rend très vulnérable. Il suffit d’un bateau de travers et c’est fini, on ne peut plus rien envoyer entre l’Asie et l’Europe!
Qu’en est-il de «l’efficacité»?
La photosynthèse est probablement le processus métabolique le plus important sur Terre: elle existe depuis 3,8 milliards d’années et elle est à l’origine de toute la biomasse et donc de toutes les civilisations. Le «rendement» de la photosynthèse est en général inférieur à 1%. Les plantes gaspillent donc plus de 99% de l’énergie solaire; elles sont vraiment, vraiment inefficaces. Les plantes n’absorbent pas toute la lumière: le fait qu’elles soient vertes impliquent qu’elles absorbent les bords de l’arc-en-ciel, la lumière rouge et bleu, et elle reflète le centre (le vert). Pourquoi donc ce gaspillage? Des chercheurs ont montré que c’est une réponse aux fluctuations de la lumière. La lumière et les cellules ne sont pas stables. Absorber les deux extrêmes (rouge et bleu), plutôt que toute la lumière du soleil, autorise les fluctuations. Les plantes gèrent cette variabilité avant le rendement. Elles construisent leur robustesse contre la performance.
Aujourd’hui, on sait que le monde est instable et les rapports scientifiques prédisent qu’il le sera davantage encore à l’avenir: on ne devrait pas se concentrer sur des questions d’efficacité mais de robustesse. Lorsqu’on cherche à s’inspirer de la biologie, on se focalise souvent sur les principes de circularité ou de coopération. C’est un bon début, mais si on ne tient pas compte de la robustesse construite contre la performance, cela ne fonctionnera pas. Par exemple, si on invente une circularité efficace, on ne prendra pas assez de marge de manœuvre (pour les événements extrêmes) et on finira par épuiser nos ressources. Si on rend la coopération efficace, on fera plutôt du gagnant-gagnant contreproductif et on en laissera certains sur le banc de touche. La robustesse est donc le principe le plus important car elle rend la circularité et la coopération opérationnelles.
Dans votre livre, vous êtes particulièrement critique envers le principe de la performance et vous établissez un parallèle entre violence contre l’environnement et burnout.
La performance génère le burnout, c’est bien décrit. Il peut donc s’agir du burnout d’une personne comme d’un écosystème. La trajectoire vers le burnout est suffisante pour condamner le tout-performant, mais, en plus, la performance est contre-productive à d’autres titres. Un exemple typique est celui des compétitions sportives: vous voulez finir premier et vous êtes prêt à tout, y compris à vous doper ou à tricher. Cela n’a rien à voir avec le sport et c’est préjudiciable à votre santé ou à votre carrière.

Vous prenez également des concepts, comme la lenteur ou l’hésitation, qu’on interprète en général négativement et vous expliquez qu’ils sont en fait positifs…
La lenteur et l’hésitation sont les clés de la compétence. On peut l’illustrer avec les cellules souches. Les biologistes se sont concentrés sur ces cellules parce qu’elles sont extraordinaires: elles peuvent renouveler toutes sortes de tissus. Pendant longtemps, on a pensé que tout cela était contrôlé par un organigramme hyper contrôlé. Il s’avère pourtant qu’un élément clé est leur lenteur: les cellules souches hésitent tout le temps et, parce qu’elles hésitent, elles peuvent tout faire! Les délais mettent du jeu dans les rouages. J’irai même plus loin: la lenteur est un levier indispensable de la transformation. Pour changer, il faut savoir s’arrêter d’abord. C’est comme être dans une voiture à un carrefour: si vous voulez changer de direction, vous devez vous arrêter, mettre votre clignotant et tourner. Si vous ne vous arrêtez pas, vous ne changerez pas.
Le changement est le mot clé ici. Les sciences dures, les chiffres et les systèmes de prédiction n’ont souvent pas la capacité de prendre en compte les imprévus ou le changement, ce qui nous donne l’illusion d’avoir une certaine forme de contrôle sur la réalité.
Heureusement, nous avons fait des progrès et maintenant, il s’agit plutôt d’utiliser les chiffres pour comprendre l’imprévisibilité du monde (au lieu d’utiliser les chiffres pour le contrôler). Par exemple, au laboratoire, on travaille sur la reproductibilité des formes des organes. Dans un champ de tulipes, toutes les fleurs se ressemblent. On pourrait imaginer un processus comme chez IKEA: construire des objets avec le même protocole les rend aussi reproductibles. Mais ce n’est pas le cas chez les vivants! Lorsqu’une fleur émerge, certaines cellules se divisent, d’autres meurent, les molécules vont et viennent… Bref, c’est le bazar. Et pourtant, au final, le miracle se produit: vous obtenez une fleur qui a la même forme, la même couleur et la même taille que sa voisine. Nous avons montré que la fleur utilise et même stimule toutes sortes de comportements erratiques, justement parce qu’ils apportent beaucoup d’informations, pour atteindre cette forme reproductible! Encore une fois, on construit de la robustesse contre la performance.
Donc, il nous faudrait accepter un certain degré de chaos?
Le sociologue Gilles Armani m’a raconté un jour une histoire sur la façon de traverser un fleuve impétueux. Le Rhône présente plein de tourbillons: à la nage, vous risquez d’être pris au piège et vous vous noierez. Lorsque les gens étaient habitués à vivre avec les rivières et, s’ils se retrouvaient pris dans le courant en nageant, ils ne se débattaient pas: ils inspiraient, se laissaient emporter par le tourbillon et le fleuve les recrachait plus loin, jusqu’à arriver près de la rive. Dans un monde fluctuant, il n’est plus question de destination à atteindre le plus rapidement possible, on se concentre sur la viabilité, construite non pas contre, mais sur les turbulences.
Image: Boris Artzybasheff.
La sagesse du myxomycète
Texte
Common Dreams
Peau Pierre
Faire commun
CROSS FRUIT
Arpentage
d’un champ à l’autre / von Feld zu Feld
Le physarum polycephalum est une espèce étrange de myxomycète, constitué d’une membrane à l’intérieur de laquelle flottent plusieurs noyaux, raison pour laquelle on le considère comme un être «acellulaire», c’est-à-dire ni monocellulaire, ni multicellulaire. Malgré la simplicité de sa structure, il présente des caractéristiques remarquables: le physarum polycephalum peut résoudre des problèmes complexes et se déplacer dans l’espace en se déployant en «tentacules», ce qui en fait un sujet passionnant pour les expériences scientifiques.
Le problème du voyageur de commerce est un problème algorithmique bien connu qui vise à optimiser les déplacements dans un réseau de chemins possibles. À l’aide d’une carte, des scientifiques de l’université d’Hokkaido ont placé un flocon d’avoine, dont se nourrit le physarum, sur les principaux carrefours du réseau de transport public de Tokyo. Libre de se déplacer sur la carte, le physarum a déployé ses tentacules qui, à la stupéfaction générale, ont rapidement reproduit les itinéraires réels des transports publics. Le mécanisme est très efficace: les tentacules s’étirent à la recherche de nourriture; si elles n’en trouvent pas, elles sécrètent une substance qui leur signale de ne pas poursuivre ce même itinéraire.
On aime envisager l’intelligence comme une chose incarnée, centralisée, qui se fonde sur la représentation. Le physarum nous apprend que ce n’est pas toujours le cas et que même les organismes les plus simples peuvent parfois suggérer de nouvelles façons de penser, d’agir et de collaborer.

Reporter la catastrophe
Si la fin est proche, pourquoi ne parvenons-nous pas à nous intéresser sérieusement au réchauffement global? Comment sortir de l’apathie de notre éternel présent? L’article qui suit est tiré de MEDUSA, une newsletter italienne qui traite des changements climatiques et culturels, publiée par Matteo De Giuli et Nicolò Porcelluzzi en collaboration avec NOT. Elle sort tous les deux mercredis et vous pouvez vous inscrire ici. En 2021, MEDUSA est aussi devenue un livre.
There is no alternative était l’un des slogans de Margaret Thatcher: le bien-être, les services, la croissance économique sont des objectifs qu’on ne peut atteindre qu’en parcourant la voie du libre marché. Aujourd’hui, quarante ans plus tard, dans un monde bâti sur ces promesses électorales, There is no alternative résonne plutôt comme un sombre constat, une devise qui trace les limites de l’imaginaire collectif: il n’y a pas d’alternative au système dans lequel nous vivons. Même lorsque nous sommes touché•e•x•s par la crise, même lorsque nous sommes confronté•e•x•s à des difficultés, à l’exploitation et aux inégalités, nous demeurons somme toute impuissante•x•s face à cet état de choses. Il n’y a pas d’issue — ou nous ne la voyons pas: l’espace du possible est désormais circonscrit.
Pourquoi ne parvenons-nous pas à nous intéresser sérieusement au réchauffement global? Parce que c’est l’un de ces systèmes complexes qui — ainsi que l’affirment Nick Srnicek et Alex Williams dans Inventing the Future — «opèrent à des échelles temporelles et spatiales qui dépassent la capacité de perception d’un individu» et dont les effets sont «si importants, que situer exactement notre expérience dans leur contexte s’avère impossible». Bref, le problème climatique est aussi la conséquence d’un problème cognitif. Nous errons dans les couloirs d’un édifice vaste et articulé, où à notre action ne correspond pas une réaction directe et immédiate et nous ne possédons aucune boussole éthique claire pour nous aider à nous orienter.
C’est justement pour approfondir ces sujets que j’ai décidé de lire What We Think About When We Try Not to Think About Global Warming (dorénavant WWTAWWTNTAGW), un essai du psychologue et économiste norvégien Per Espen Stoknes, un livre que j’ai longtemps hésité à lire pour une série de raisons qui ne se sont avérées qu’en partie valables. Tout d’abord, il y avait mon parti pris vaguement scientiste: malgré mon intérêt pour cet argument, la quatrième de couverture de WWTAWWTNTAGW évoque plus le rabat d’un livre de self-help que celui d’un ouvrage de vulgarisation sérieux. La voici: «Stoknes montre comment re-raconter l’histoire du changement climatique, en créant en même temps des actions positives et significatives pouvant être soutenues également par les négationnistes». Puis, il y avait le titre, WWTAWWTNTAGW, qui paraphrase maladroitement le titre déjà le plus amplement paraphrasé de l’histoire des titres de la littérature mondiale. Enfin — sans entrer en profondeur — il y avait le spectre de l’autre essai publié par Per Espen Stoknes en 2009, dont la couverture à elle seule continue à me provoquer un malaise insurmontable: Money & Soul: A New Balance Between Finance and Feelings.

Mettant de côté, du moins pour le moment, la morgue qui m’empêchait d’attaquer la lecture de WWTAWWTNTAGW, j’ai découvert un livre léger contenant plusieurs idées intéressantes. En bref: pourquoi sommes-nous si peu intéressé•e•x•s au changement climatique et à notre avenir? Pourquoi le percevons-nous comme un problème abstrait et lointain? Quelles sont les barrières cognitives qui nous calment, nous tranquillisent et nous empêchent d’avoir une once de vive préoccupation pour le sort de la planète? Stoknes en identifie cinq qui, résumées et condensées, sont plus ou moins celles-ci:
La distance. Le problème climatique est un enjeu encore lointain pour beaucoup d’entre nous et à bien des égards. Si les inondations, la sécheresse et les incendies sont de plus en plus fréquents, ils ne frappent encore qu’une petite partie de la planète. Les impacts les plus lourds sont encore loin devant nous, dans un siècle ou plus.
L’apocalypse. Le changement climatique est raconté comme un désastre insurmontable qui entraînera des pertes, des coûts et des sacrifices: l’instinct humain nous pousse à éviter ce sujet. Nous sommes prévisiblement contraires au deuil. L’absence d’offre de solutions pratiques renforce notre impuissance et les messages catastrophiques nous impactent. On nous a dit tellement de fois «la fin est proche» que cela ne nous affecte plus.
La dissonance. Lorsque ce que nous savons (utiliser de l’énergie fossile participe au réchauffement global) entre en conflit avec ce que nous sommes obligé•e•x•s de faire ou que nous finissons de toute façon par faire (conduire, prendre l’avion, manger de la viande de bœuf), une dissonance cognitive s’installe en nous. Pour en sortir, nous sommes poussé•e•x•s à mettre en doute ou à sous-estimer ce dont nous sommes certains (les faits) afin de mener plus confortablement notre vie quotidienne.
La négation. Lorsque nous nions, nous ignorons ou nous évitons de reconnaître certains faits inquiétants que nous savons être «vrais» concernant le changement climatique, nous cherchons un refuge contre la peur et le sentiment de culpabilité qu’ils induisent en nous et contre l’atteinte à notre mode de vie. Le déni est un mécanisme d’autodéfense qui ne repose pas sur l’ignorance, la stupidité ou le manque d’information d’une personne.
L’identité. Nous filtrons les informations en fonction de notre identité personnelle et culturelle. Nous cherchons les informations qui confirment les valeurs et les présuppositions déjà présentes dans notre esprit. Notre appartenance culturelle prime sur les faits. Si de nouvelles recommandations nous demandaient de changer, probablement nous ne les accueillerions pas. Nous sommes réfractaires aux demandes de changer notre identité personnelle.
Bien évidemment, des centaines d’autres raisons nous éloignent encore d’une stratégie de mitigation du changement climatique: les intérêts économiques, la lenteur des diplomaties, les conflits entre les modèles de développement, les États-Unis, l’Inde, l’égoïsme tout court, Le grand dérangement et tout ce que nous avons si bien appris à connaître au fil des ans. Mais Per Espen Stoknes suggère empiriquement un chemin à suivre. Le catastrophisme et l’alarmisme ne marchent pas. Il nous faut trouver un autre ton pour sortir de l’apathie de notre éternel présent.
Image: Le Grosser Aletsch, 1900 Photoglob Wehrli © Zentralbibliothek Zürich, Graphische Sammlung und Fotoarchiv/ 2021 Fabiano Ventura - © Macromicro Association.
Un sentiment profond de devoir agir
Parlez-nous brièvement de vous et expliquez-nous comment vous êtes devenue éco-activiste.
Je ne dirais pas que je suis une activiste. En dehors de mon rôle de coprésidente, je suis élue au parlement de ma ville. J’ai également créé un collectif écoféministe avec deux amies à Bienne, «La Bise», et je gagne ma vie comme infirmière dans le domaine de la petite enfance. Peu avant mes 18 ans, j’ai ressenti un sentiment profond de devoir agir. Ou au moins d’essayer. Je ne saurais vraiment dire ce qui a créé ce besoin de m’engager. J’ai commencé mon engagement politique au sein d’un petit groupe de jeunes vert·e·s. Et un jour les choses se sont enchaînées. On m’a demandé si je souhaitais me mettre sur une liste électorale. J’ai accepté et j’ai été élue. Cet événement m’a beaucoup aidé à réseauter et à trouver des personnes avec qui je pouvais échanger, militer, créer de nouveaux projets.
Dans quel état se trouve les glaciers en Suisse? Et en quoi est-ce important de prendre soin des glaciers en particulier?
L’état des glaciers en Suisse est désastreux. Avec la fonte des glaciers, la Suisse perd (en plus de sa biodiversité et de ses hivers blancs, entre autres) une importante réserve d’eau qui, selon les estimations, pourrait assurer la consommation de sa population pendant 60 ans.
Une partie de la résistance aux révolutions telles que l’abandon des énergies fossiles est liée à des intérêts économiques. Jouons à un jeu de scénarios: avec et sans énergies fossiles, à court et à long terme…
La croissance ne peut être infinie, elle nous conduit à notre propre destruction. L’indépendance vis-à-vis des combustibles fossiles nécessite de soutenir d’autres formes de sources d’énergie. En Suisse, la production d’électricité provient principalement de centrales hydrauliques (62%), de centrales nucléaires (29%), de centrales thermiques conventionnelles et d’installations d’énergies renouvelables (9%). Produire notre propre énergie nous permet de ne plus dépendre d’autres pays. C’est l’occasion pour les États de tracer une nouvelle voie et de créer des emplois dans de nouveaux domaines. C’est donc une bonne chose pour l’économie.
La protection de l’environnement est un sujet complexe. Parfois, pour corriger une erreur, on en commet une autre. Quelle est votre stratégie pour faire face à cette complexité?
Si on pense sans arrêt à ce qu’on va faire de mal, on ne peut aller de l’avant avec des stratégies qui ont un impact réel. On ne peut pas toujours tout faire correctement, mais on peut mettre en place des mesures qui ont un impact important sur le changement à long terme. Comme une indépendance vis-à-vis des sources d’énergies importées qui sont nocives pour la planète.
La solastalgie est une forme de détresse causé par l’impact du changement climatique, qui s’accompagne souvent d’un sentiment de perte vis-à-vis d’un paysage bien-aimé. Avez-vous l’impression de souffrir de solastalgie? Et quelle est votre expérience de ce problème dans les communautés suisses?
La solastalgie est un terme relativement peu connu, mais, en discutant avec des personnes vivant dans des régions plus sauvages ou alpines, on relève parfois ce sentiment de détresse vis-à-vis d’un paysage disparu ou modifié. Les sensibilités au changement climatique sont aussi diverses que les régions de suisse. Le lieu d’origine d’une personne influence la manière dont elle réagit aux conséquences de ce changement. Il semble naturel d’être plus touché par le manque de neige en hiver ou par la fonte des glaciers lorsqu’on vit ou que l’on a grandi en milieu alpin. Les personnes plus citadines sentent par exemple davantage les îlots de chaleur et la suffocation grandissante en été. À l’heure actuelle, je pense que je souffre davantage d’éco-anxiété que de solastalgie.
Vous faites partie du collectif écoféministe La Bise: pouvez-vous me parler des activités du collectif et de ce que les instances écoféministes apportent en particulier à la lutte générale contre la crise climatique?
La Bise est un collectif qui tente de rassembler les luttes. Le collectif a été créé il y a bientôt cinq ans. En parlant avec deux amies de ce qui nous animait ou nous agaçait dans les luttes féministes et écologiques, j’ai eu envie de nous réunir toutes les trois. L’idée de créer un espace bienveillant et inclusif pour parler de nos engagements était au cœur de notre ébauche de projet. Dans un premier temps, nous étions mobiles, nous n’avions pas de local. Puis nous avons pu créer notre bibliothèque écoféministe. La bibliothèque regroupe des livres de plusieurs catégories: féminisme et genre, séxualité, livres pour enfants, bandes déssinées. Nous avons une bibliothèque écoféministe, mais nous organisons aussi plus ou moins régulièrement des événements qui lient la lutte pour la protection de la planète et la lutte pour l’égalité des genres.
Plusieurs études montrent que les femmes et les minorités de genre font partie des êtres humains les plus touchés par le changement climatique. Un exemple parmi d’autres: les femmes et les minorités de genre sont souvent oubliées lors des catastrophes naturelles – souvent parce que ce sont ces mêmes personnes qui prennent soin des autres.
Vivre le Rhône: partie 1
«Quelles sont les histoires qui existent déjà?»
Une vidéo de Carlos Tapia met en scène le Rhône, Maria Lucia Cruz Correia, Vinny Jones et Lode Vranken. Février 2023.
Cliquez ici pour la partie 2.
Cliquez ici pour la partie 3.
Common Dreams Panarea: Flotation School
Common Dreams Panarea : Flotation School est un projet qui s’intéresse à la survie, aux biens communs, et aux différents espoirs et stratégies pour faire face au changement climatique et à l’Anthropocène. La vidéo, réalisée par les élèves du Collège Sismondi sous la direction de Carlos Tapia, documente le processus de cocréation mené par l’artiste Maria Lucia Cruz Correia, qui a abouti à la construction d’une «île flottante» sur les eaux du lac Léman.
GLOSSAIRE DE LA TRANSITION (T — T) par Ritó Natálio
Contexte
Les personnes en transition sont les capteurs d’une terre en transition.
Les personnes trans sont les radars de la transition de la terre.
L’eau est-elle peut-être un conducteur de contamination ?
RADARS DE LA TRANSITION
On dit que « la transition est un travail » et qu’il devrait être rémunéré. En lisant ces mots de Harry Josephine Giles (“Du salaire pour nos transitions”/ “Wages for transition”, 2019), l’Écrivain immigrant du Sud de l’Europe espère pouvoir trouver un sens à la connexion voilée entre les corps humains assoiffés de transformations (et impliqués dans des processus intimes de transition de leur genre assigné à la naissance) et les processus plus larges de transition apocalyptique du Système Terre (aussi appelés Anthropocène, ou tout simplement effondrement climatique). Si la transition est un travail, qui serait le bioprolétariat commun à ces processus ? Les hormones synthétiques administrées dans les thérapies hormonales ou les hormones libérées dans les sources d’eau à partir de l’utilisation massive de la pilule du lendemain ? Des corps humains ou des corps non humains occupés par des transitions de toutes sortes ?
Et quelle serait la différence entre transition et contamination ? Quelle serait la différence entre transition comme transformation en une nouvelle forme de vie, ou transition comme dégénérescence d’un corps existant ? Et cette question, ne serait-elle pas justement le reflet d’une pensée conservatrice d’une cisplanète ou d’un ciscorps, qui doit se maintenir ou se conserver dans le temps, et auquel un processus de transition viendrait ajouter une bonne dose de confusion ?
D’un autre côté, le processus actuel de réduction de la sociobiodiversité du Système Terre ne serait-il pas une forme de protestation du bioprolétariat qui met en évidence les conditions violentes d’un travail de transition non rémunéré ?
L’Écrivain immigrant du Sud de l’Europe arrive à Genève sans langue commune pour mener sa recherche, mais il vient avec la détermination d’organiser une assemblée de jeunes qui pourrait décrypter les signaux inaudibles et invisibles de la transition planétaire, permettant ainsi d’élargir ce qui est temporairement appelé ici « Glossaire de la Transition » (ou simplement T — T).
Assisté par des spécialistes somatiques – chorégraphes, artistes visuels, scientifiques et psychothérapeutes – les signes lus sont évidents : la pollution est une forme de manifestation politique d’agents biochimiques.
L’Écrivain raconte dans ses journaux :
5 juin 2024 : À chaque fois que j’écris à la première personne, un rayon de lumière change ou un nuage se dissout. Mon corps est la terre parce que la terre est mon corps, et en grattant un morceau de bras, je sens l’artère du Rhône se contracter sous mes doigts. Depuis que j’ai commencé à écrire sur ce monde, j’ai l’impression de venir d’un autre, un monde où léviter et protester font partie d’une même réalité. Ainsi, en respirant, je montre les dents de Genève et ses monstres : des lingots d’or provenant des mines d’Amérique du Sud, s’élèvent des coffres et survolent les cieux au-dessus du Jet d’Eau. Ma bouche est en or mais j’ai des caries comme tous les territoires qui transitent à partir de l’accumulation. La colonialité est mon propre corps.

Image: Because the Spanish thirst for gold, the Indians poured liquid gold into them, illustration de Theodore de Bry, circa siècle XVI.
Attention, familles, car les « perturbateurs endocriniens » attirent et trompent votre organisme !
Ces substances qui perturbent les messages chimiques de vos corps, se lient au récepteur et génèrent une réponse indésirable !
C’était le type de message que l’on lisait dans les prospectus du Conseil d'État en 2004 :
Mesdames et Messieurs les députés,
En date du 21 octobre 2004, le Grand Conseil a renvoyé au Conseil d’État une interpellation urgente écrite qui a la teneur suivante :
Des études et découvertes relativement récentes démontrent que nous sommes peut-être au seuil d’un nouveau et grave problème de pollution de l’eau.
En effet, des taux anormalement élevés d’hormones ont été mesurés dans l’eau, provenant du rejet dans l’eau d’urines « contaminées » et de produits utilisés contenant des hormones, les stations d’épuration actuelles ne pouvant pas les neutraliser.
L’usage de plus en plus fréquent d’œstrogènes chimiques à destination humaine et animale, de pesticides et d’insecticides, rejetés dans l’environnement, se retrouvent alors dans l’eau potable, pouvant provoquer une augmentation de production d’œstrogènes et des dérangements hormonaux chez l’humain.
Ainsi, des menstruations à 8 ans, ou l’infertilité des « hommes cis » se sont révélées être des conséquences effrayantes à traiter le plus vite possible : jeter l’eau contaminée par du bisphénol et des sels d’ammonium quaternaires, changer les jouets de la maison et brûler le mobilier sur la place publique avec les autres familles affectées. Ainsi, l’Écrivain immigrant voulait essayer de réunir dans un poème une expérimentation sur d’autres façons de comprendre les messages chimiques hormonaux, dans l’espoir que la transition soit embrassée comme une grande expérimentation de la langue. Voyons son journal :
10 juin 2024 : Je suis allé à la pharmacie acheter du gel de testostérone et l’ai appliqué sur le bras de Genève. L’eau issue de la fonte des Alpes se mélange au gel, et permet la transition plus douce de la musculature de la ville. Comme dans une étreinte, moi et G. échangeons des hormones et plongeons dans une piscine de pollution hormonale.

LES MARQUES DEVRAIENT EXISTER ET ELLES DOIVENT AVOIR UN SENS
Dans la continuité des études de thérolinguistique initiées par Ursula K. Le Guin dans « The author of the acacia seeds » (2011), propagées par Vinciane Despret dans « Autobiographie d’un poulpe » (2021), l’équipe de recherche de Peau-Pierre est convaincue que le langage est une extension haptique, sonore mais aussi télé-empathique entre des corps de formes différentes. La capacité à ressentir avec, et à distance, permet que le corps de la Terre – le Corps T – se mobilise par la transition empathique d’autres corps T et, avec eux, communique par des messages chimiques d’appartenance.
Dans nos ateliers, de nombreuses expériences ont été réalisées pour comprendre le corps humain comme un territoire, en créant des fables et des slogans autour de l’idée du corps comme une « miette temporelle » (Ulysse, Atelier Peau Pierre, Mai 2024, L’Abri) , une « blessure » ou un «cristal» (Jonas Van, Atelier Peau Pierre, Mai 2024, L’Abri). Lors de l’une de ces pratiques, les corps capteurs ont rapporté des épisodes curieux comme :
la sensation de transférer des hormones par l’eau
la sensation de deux colonnes vertébrales reliées par une fermeture éclair
la certitude qu’un tibia est un tronc d’arbre
les doigts se mouvant comme des feuilles
des mains de mille doigts
des petites créatures de sable faisant des révolutions molles dans le ventre d’une jambe
des lunettes de chair consistant à coller le front sur l’avant-bras d’un collègue
(contribution des participant.e.xs Atelier Soft Borders, avec Clém, Stella, Ritó et Aurore, Juillet 2023, Theatre Saint Gervais.)
Souvent, ce transfert de qualités entre un corps et un autre corps se produisait après un long temps de contact avec les mouvements. Par exemple, après avoir longtemps caressé une pierre, traversé et exploré ces surfaces, pierre et peau entraient en contact l’une avec l’autre jusqu’à échanger leurs qualités.
[continue…]


Image: print “Du salaire pour nos transitions”/ “Wages for transition” de Harry Josephine Giles, 2019.
GLOSSAIRE (possibilités)
HORMONE (Denise Médico)
J’ai encore oublié mon rituel à faire deux soirs semaine selon l’étiquette sur l’emballage blanc et rose, graphisme pharmaceutique suisse irréprochable, simple, trop droit, confiant et presqu’anodin. J’ouvre le tiroir du bas, je recherche les deux petits tubes en plastique qui s’assemblent pour en faire un piston-distributeur. Je le visse sur le tube en métal et tire en arrière le petit côté pour remplir le grand de crème à l’estradiol x mg. Je le mets bien au fond de mon vagin, j’imagine qu’il sera plus efficace, qu’il aura plus de temps et d’espace pour pénétrer les tissus et de se répandre ensuite dans mon système sanguin. J’imagine ces petits animaux qui me colonisent et me re-transforment, ils se collent à mes cellules, les embrassent de leurs bouches remplies, les contaminent volontairement et leur font croire qu’il est encore temps. Chargée de mon stock hormonal synthétique biocompatible, je reprends mon enveloppe de professeure psychothérapeute.
(Wikipedia, the free encyclopedia: une HORMONE, mot français signifiant en grec «mise en mouvement», est une classe de molécules de signalisation dans les organismes multicellulaires qui sont envoyées à des organes ou tissus distants par des processus biologiques complexes afin de réguler la physiologie et le comportement.)

Image: Boucle de rétroaction hormonale chez une adulte de sexe féminin. Hormone folliculo-stimulante, hormone lutéinisante, progestérone, estradiol. À droite : transport de l’auxine des feuilles aux racines chez Arabidopsis thaliana.
CORPS VOYAGEUR (Jonas Van)
Dans une salle au cœur de Genève, en milieu d’après-midi, notre groupe d’artistes se réunit. Une grande quantité d’eau inonde le sol. Collectivement, nous essayons de déplacer cette eau avec nos corps. Mais elle se déplace à une vitesse que nous ne comprenons pas ; il nous est impossible de la transporter physiquement.
Le corps humain compte environ 100 000 kilomètres de vaisseaux sanguins, ce qui est suffisant pour faire deux fois et demi le tour de la planète Terre. Les vaisseaux sanguins sont constitués d’artères et de veines. « Veine » vient du latin vena : petit canal souterrain naturel d’eau. En fait, en prenant l’eau entre nos mains, nous imitons le mouvement circulatoire élémentaire du corps, mais à l’extérieur de celui-ci.
Cette eau sur le sol catalyse nos mémoires. Et lorsque nos peaux se touchent finalement, l’eau est l’intermédiaire de cette rencontre. C’est ainsi qu’une fissure temporelle s’est ouverte dans la salle au cœur de Genève. Nos peaux, imitant le mouvement du système circulatoire, se sont progressivement réchauffées jusqu’à produire un frottement suffisant pour que l’eau entraîne le corps dans un voyage à travers l’espace-temps. L’exercice suivant a été de parler de l’endroit où nous avions voyagé. Ces ont pris la forme d’une capsule sonore.
CORPS-GLACIER (Stella Succi)
Si je pouvais penser comme il faudrait penser, j’aurais du mal à penser : la quantité de stimuli internes et externes que je reçois est impressionnante. Pour faire une comparaison, c’est comme être dans une pièce où beaucoup de gens parlent à haute voix, tous dans des langues différentes. En arrière-plan, il y a une grande musique, quelqu’un tape du pied à l’étage supérieur, et en plus il fait très chaud – on sue, et comme on sue ! Comment est-il possible de faire des calculs avec tout ce vacarme ? C’est pas possible ! Mais d’ailleurs, est-ce vraiment utile de compter ? En fait, je me mets à écouter. Voilà, c’est ma façon de penser. Suivre le discours biochimique du mammouth dont la décomposition s’est arrêtée entre mes molécules ; ou du gant tombé de l’alpiniste distrait, qui se dissout au ralenti comme une vieille cassette dans un walkman avec des piles épuisées ; et me laisser bercer par les murmures du CO2 : certains proviennent de mes profondeurs les plus secrètes, presque d’un inconscient, d’autres sont jeunes et enragés. Récemment, un voile coloré de sable du désert s’est également posé sur moi, avec ses phosphates, son ammonium, son fer… Vous l’aurez deviné : j’utilise la première personne du singulier pour me faire comprendre, mais le seul pronom qui ait du sens pour moi est they/them.
ALPINISME (Stella Succi)
La pratique de l’alpinisme naît au XVIIIe siècle avec le noble objectif de parvenir à maîtriser, même aux altitudes les plus extrêmes, la nature sauvage; d’éclairer de connaissances les vallées sombres; de déflorer la virginité intacte des montagnes (et disons-le, les montagnes ont aussi apprécié). D’ailleurs, la verticalité des montagnes, semblable à d’énormes érections de pierre, semble conçue à dessein pour défier les hommes les plus vigoureux et puissants, dignes de regarder la planète entière de haut en bas. Si les premières expéditions en haute montagne étaient guidées également par un intérêt scientifique, l’alpinisme moderne s’est enfin libéré de ce fardeau ennuyeux pour se consacrer à la simple conquête des sommets, à tout prix et par tous les moyens. L’alpinisme a donc fini par incorporer des valeurs culturelles qui définissent une relation de domination sur un environnement hostile – oserons-nous dire hystérique. Cependant, avec le glorieux avènement de l’anthropocène, certains phénomènes mystérieux ont été observés, où des alpinistes de renommée mondiale redescendent les pentes avec les symptômes les plus étranges – accès de toux, nausées, vertiges, desquamation de la peau. Les effets semblent imiter ceux d’une intoxication grave ou d’un empoisonnement : un fait inexplicable compte tenu de la notoire pureté de l’air alpin, toujours source de force et de bonne santé. Des cas d’hallucinations auditives ont également été signalés : il semblerait que certains alpinistes, avant de ressentir les premiers troubles, auraient entendu résonner dans les vallées un bruit particulier, décrit par certains comme un « rictus maléfique » ou un « rire satisfait ».
LA CHAÎNE HUMAINE DE L’EAU (Cyrus Khalatbari)
Extraction
La chaîne humaine de l’eau (géologique et informatique) commence par les corps au travail et les conditions de travail des mineurs. Prenons l’exemple de l’extraction du cobalt – un métal précieux utilisé dans les batteries, les disques durs et les cartes de circuits imprimés (PCB) – en République Démocratique du Congo (RDC) : des cœurs et des poumons gorgés de sang qui circule, à la sueur des hommes et des enfants et aux sachets d’eau qu’ils apportent pour faire face leur journée de travail dans des mines à ciel ouvert ou souterraines, l’état de notre culture informatique se révèle d’abord à travers les liquides qui parcourent notre corps et notre métabolisme. Parallèlement à l’eau comme élément central de la survie des corps au travail, la chaîne humaine de l’eau géologique et informatique s’étend également aux processus de purification et de raffinage, lors desquels le cobalt passe de minerai brut à un métal « pur ». Ici, une double dépendance à l’eau est mise en lumière : l’eau est essentielle au travail des mineurs et au fonctionnement de leurs corps, et elle est cruciale pour fabriquer et transformer le métal – les substrats, sous forme brute, sont « polis » afin d’être utilisés dans l’industrie technologique, pour sauvegarder et faire circuler les données dans notre vie quotidienne.
Optimisation
Les emojis en forme de cœur que nous ajoutons aux photos de chats mignons ou de matcha latte mousseux ont des ramifications importantes. Ces emojis nous relient à l’infrastructure tentaculaire d’optimisation et de refroidissement des centres de données. Derrière ces flux numériques triés et organisés de manière visuellement attrayante, le contenu est stocké, organisé et modélisé grâce à un réseau de canalisations d’eau et de systèmes de contrôle thermique. Bien que l’emplacement exact de ces installations soit inconnu, des informations publiques sont disponibles sur les États où ces opérations ont lieu. Pour Meta, il s’agit de l’Arizona, de l’Utah ou du Nouveau-Mexique (États-Unis), où les coûts de l’électricité figurent parmi les moins chers du pays. Malgré l’aridité de ces régions, de grandes quantités d’eau sont utilisées. Nourrissant une esthétique harmonieuse qui nous aliène aux réseaux sociaux, les emojis détournent et exploitent nos ressources naturelles. Des rivières aux lacs, en passant par les réservoirs et les nappes phréatiques, cette technologie est doublement liquide : elle se liquéfie pour le contrôle et le brouillage des données, et de manière plus littérale, son infrastructure dépend des cours d’eau et d’autres ressources pour refroidir les serveurs.
Déchets
Sur les sites de traitement des déchets électroniques comme Agbogbloshie (Accra, Ghana), les fluides s’écoulent et se mêlent à la nature, aux corps et à la technologie. Parmi la multitude de techniques indigènes qu’utilisent quotidiennement les « démanteleurs », ferrailleurs ou fondeurs indépendants pour nettoyer, transformer et récupérer ces composants mis au rebut, l’eau joue un rôle clé. Lors du broyage des appareils, elle permet d’abord de réduire la quantité de poussière et de fournir aux acheteurs des métaux récupérés « neufs ». Dans le recyclage de l’or et du cuivre, l’eau est aussi mélangée à des produits chimiques et des solvants. Les travailleurs utilisent par ailleurs des méthodes de séparation par flottaison pour dissocier différents composants : grâce à leur densité, les composants métalliques coulent tandis que le plastique et d’autres matériaux flottent. Malheureusement, en raison du manque d’infrastructures de recyclage, l’eau est ensuite évacuée dans le sol, les nappes phréatiques et les rivières environnantes. En plus de polluer l’environnement, des substances toxiques comme le plomb, le mercure ou le cadmium s’infiltrent dans les cours d’eau voisins, avant d’être ingérées par les animaux, dont le bétail. Les bêtes, une fois abattues, sont vendues sur les marchés locaux.
LE THERMOTRAVAIL COMPUTATIONNEL (Cyrus Khalatbari)
Computex 2023, Taïwan
En se baladant à COMPUTEX, on observe que « le travail de l’informatique est le travail de la gestion de la chaleur » (Brunton, 2015 : 159). Parmi les différents stands qui composent le salon, un point commun se dégage : on observe une accumulation de tubes d’ordinateurs, de ventilateurs et d’autres dispositifs de refroidissement conçus avec des systèmes d’éclairage dynamique que les joueurs peuvent activer à distance. Ces dispositifs, au-delà de leurs fonctions esthétiques, caractérisées par l’usage intensif des couleurs rouge, vert et bleu, n’ont qu’une seule fonction : pour reprendre les mots de Brunton, ils sont conçus pour permettre aux puces de fonctionner au maximum de leurs capacités tout en dissipant la chaleur le plus rapidement possible, en utilisant l’air, l’eau ou la glace.
De prime abord, ces dispositifs semblent purement techniques, limités au domaine de l’informatique et au fonctionnement des ordinateurs. En réalité, en incluant l’utilisation de l’eau, essentielle aux systèmes d’intelligence artificielle et aux données dans notre vie quotidienne (voir la chaîne humaine de l’eau), je soutiens que ces dispositifs sont aussi sociotechniques. Autrement dit, par leurs besoins et leurs caractéristiques, ils mettent en place de nouvelles cartographies du travail, englobant les grandes entreprises technologiques comme les acteurs plus petits. Alimenté par nos désirs algorithmiques et nos besoins en systèmes de recommandation toujours plus puissants et précis, qui se doivent de « simplement fonctionner » (Starosielski, 2016), le refroidissement devient alors un composant central de l’économie informatique. Ainsi, de la maîtrise de l’optimisation thermique découle le contrôle algorithmique : plus de fluidité, plus de dopamine, plus de temps passé à se connecter et à consommer.
C’est à COMPUTEX que se déroulent les compétitions d’overclocking à l’azote liquide (ln2). Ces compétitions consistent à verser de l’azote liquide sur les puces en silicium « brûlantes » des ordinateurs afin de produire le système de jeu le plus puissant, dans une course contre la montre ou dans format de compétition par équipe. Bien qu’à première vue triviales, ces compétitions sont cruciales pour l’industrie car elles offrent l’opportunité de « tester » les puces, en les poussant vers leurs limites thermiques, grâce à l’expertise des overclockers à l’azote liquide. Grâce à ces expérimentations gratuites, un transfert de connaissances s’opère et s’intègre aux générations de puces suivantes : moins piratables, plus privées, de meilleures « boîtes noires ».
Je définis ici le thermotravail computationnel comme une forme de dynamique de pouvoir asymétrique entre les grandes entreprises technologiques et les individus. Fusionnant trois mots (travail, thermique et computationnel), le terme fait référence à une situation où les puissantes entreprises de notre société computationnelle exploitent et exercent un contrôle sur les utilisateurs ou les communautés indépendantes, en raison des caractéristiques thermiques qui structurent cette société computationnelle.
Agbogbloshie (Accra, Ghana)
Ce thermotravail computationnel détermine également d’autres aspects du cycle de vie de nos ordinateurs, comme à Agbogbloshie, à Accra, au Ghana. Ce quartier, présenté par les chaînes d’information occidentales grand public comme l’endroit où « les ordinateurs vont mourir » (Wired, 2015), est en réalité un milieu dynamique de circularité et de transformation. En nuançant ces stéréotypes et discours réducteurs, des lieux comme Agbogbloshie mettent en lumière des communautés locales travaillant ensemble pour extraire de la valeur des déchets. Ici, les démanteleurs constituent la première communauté à activer cette chaîne de valeur. Parcourant les environs du site, ils repèrent des ordinateurs en panne qu’ils achètent à des prix minimes auprès des vendeurs. Ces ordinateurs sont ensuite démontés, leurs métaux triés (voir la chaîne humaine de l’eau). Du cuivre à l’aluminium, en passant par le laiton et l’acier, la matérialité de notre culture sociotechnique est alors réduite aux éléments qui l’alimentent.
C’est au niveau de ces métaux que le thermotravail computationnel s’opère, reflétant les dynamiques de pouvoir observées à COMPUTEX à Taïwan. Plus précisément, cela se manifeste dans les températures auxquelles ces métaux fondent et se transforment, pour répondre à leur tour aux besoins de l’industrie et du travail. L’aluminium, par exemple, fond à 660,3°C. Cela permet aux acteurs locaux de traiter ce matériau avec des techniques traditionnelles pour atteindre ce seuil de température, généralement en soufflant de l’air dans des foyers à l’aide de ventilateurs artisanaux. Pour l’acier, qui fond à 1400°C, les communautés locales de démantèlement dépendent des installations appartenant à des entreprises indiennes. Ces acteurs industriels puissants opèrent à plus grande échelle pour transformer les déchets métalliques en tiges de fer qui sont ensuite vendues à l’international. En tant qu’acteurs exclusifs du marché du traitement de l’acier en Afrique de l’Ouest, ils maintiennent le contrôle des prix, affectant à leur tour la croissance et l’indépendance des communautés locales.
presse
Rencontre avec Véronique Ferrero Delacoste à propos d’un champ à l’autre / von Feld zu Feld
Rhône FM, Good Morning Valais, 05/08/2025
Diskussion und Wanderung im Saflischtal
Pomona, 07/07/2025
d’un champ à l’autre: offrir un espace d’échange et de dialogue
Walliser Zeitung, 24/07/2025
Un projet artistique participatif
Park Info nr.41, Avril 2025
CROSS FRUIT: Art, écologie et action collective
Tv Onex, 21/03/2025
Nature morte
Radio GRRIF, 18/12/2024
Partager l’autorité
Journal de danse - Pavillon ADC, Octobre 2024-Fevrier 2025
L’art à table, espace des possibles
L’Hebdo du quotidien de l’art, 05/07/2024
Explore demain, au cœur des débats citoyens
Tribune de Genève, 22/04/2024
Permaculture, le modèle écologique qui réinvente la culture
L’Hebdo du quotidien de l’art, 09/02/2024
Une école flottante pour repenser notre rapport au climat et à l’environnement
RTS, 29/11/2023
Devenir gardien·ne du Rhône
Le Courrier, 20/07/2023
«Vivre le Rhône» célèbre l’identité du fleuve
Tribune de Genève, 13/07/2023
Le Rhône cherche gardien·ne
Le Courrier, 12/07/2023
Weaving Subjects à la MACO
«Vivre le Rhône», démarche citoyenne et artistique
Le Temps, 07/07/2023
Une initiative pour accompagner notre société dans sa transformation
Kunstbulletin 5/2023
least, une association qui veut sauver la planète grâce aux arts
Forum, RTS, 26/04/2023
«Common Dreams», une plateforme flottante à Genève
Le Temps, 20/04/2023
Une plateforme sur les flots pour mieux vivre
Le Temps, 20/04/2023
L’association least rêve de sauver la planète grâce aux arts
Tribune de Genève, 22/03/2023